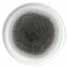

To find out more about our latest collections:
CONTACT US
Tel: +44 (0) 1782 577566
Email: info@churchill1795.com Website: www.churchill1795.com
To order samples please contact: uk.samples@churchill1795.com


To find out more about our latest collections:
CONTACT US
Tel: +44 (0) 1782 577566
Email: info@churchill1795.com Website: www.churchill1795.com
To order samples please contact: uk.samples@churchill1795.com
INTRODUCTION 4 - 5
PERFORMANCE DELIVERED 6 - 11
WHAT’S NEW 12 - 13
INTRODUCTION 14 - 15
AMBIENCE 20 - 23
ABSTRACT 16 - 17
ABSTRACT FEATURE PIECES 18 - 19 BALANCE 28 - 29
BANDS 42 - 45 ENERGY 32 - 33 JARDIN 40 - 41 MOONSTONE 30 - 31
PLATE TOWERS 36 - 37 SEQUEL 34 - 35
SIGNATURE TILES & WOODEN BOARDS 38 - 39 WHITE 24 - 27
STOKE SHOWROOM*
No.1 Marlborough Way, Tunstall, Stoke-on-Trent, ST6 5NZ, England
To arrange a visit to our Stoke Showroom Please Call: +44 (0) 1782 577566
LONDON SHOWROOM*
Business Design Centre, Suite 102, 52 Upper Street
Islington, London, N1 0QH, England
To arrange a visit to our London Showroom Please Call: +44 (0) 1782 524505
BERLIN SHOWROOM*
Rankestraße 8, 10789
Berlin, Germany
To arrange a visit to our Berlin Showroom Please Call: +49 (0) 30 33 91 11 10
MADRID SHOWROOM*
Princesa Street No 2, 7th Floor, Doors 4 & 5, Madrid 28008, Spain
To arrange a visit to our Madrid Showroom Please Call: +34 (0) 910 004 929
BUFFET CERAMIC SERVINGWARE 46 - 51 COOK & SERVE 54 - 55 COUNTERWAVE 52 - 53
INTRODUCTION 320 - 321 CERAMIC BUFFET TRAYS 322 - 323 MELAMINE 324 - 331 WOOD 332 - 341 POLYCARBONATE COVERS 326 - 327
CHURCHILL SUPER VITRIFIED
INTRODUCTION 56 - 57 BAMBOO 228 - 239 BIT ON THE SIDE 270 - 273 BUCKINGHAM 264 - 265
CHEFS’ PLATES 246 - 247
CLASSIC 256 - 257
COOKWARE 274 - 275
COUNTER SERVE 276 - 277
COUNTER SERVE HINTS 278 - 279
EMERGE 210 - 213
EVOLVE 244 - 245
EQUATION 254 - 255 ISLA 216 - 227
LOTUS 252 - 253 MEDITERRANEAN 254 - 255
In the printing of this brochure every effort has been made to ensure perfect reproduction of our products, but due to printing limitations, they may not be an exact match to the actual product.
CHURCHILL SUPER VITRIFIED (CONTINUED)
NOVA 258 - 259
NOURISH 266 - 269
ORB 250 - 251
ORBIT 250 - 251
PROFILE 240 - 243
RETRO BLUE 208 - 209
SNACK ATTACK 280 - 281
STONECAST 62 - 99
STONECAST ACCENTS 104 - 109
STONECAST AQUEOUS 124 - 129
STONECAST HINTS 100 - 103
STONECAST NOURISH 144 - 145
STONECAST PATINA 130 - 143
STONECAST PLUME 120 - 123
STONECAST RAW 110 - 119
STUDIO PRINTS HAZE 148 - 149
STUDIO PRINTS KINTSUGI 152 - 157
STUDIO PRINTS KINTSUGI ACCENTS 150 - 151
STUDIO PRINTS AGANO 200 - 201
STUDIO PRINTS HOMESPUN 194 - 199
STUDIO PRINTS HOMESPUN ACCENTS 190 - 193
STUDIO PRINTS MINERAL 188 - 189
STUDIO PRINTS RAKU 158 - 173
STUDIO PRINTS RAKU DUO 174 - 177
STUDIO PRINTS STONE 178 - 187
TRACE 244 - 245
VELLUM 214 - 215
VINTAGE PRINTS 204 - 207
VINTAGE PRINTS MED TILES 202 - 203 VOYAGER 280 - 281
WHITE 260 - 263
X SQUARED 248 - 249
X SQUARED+ 248 - 249
BAMBOO 236 - 237
CAFÉ 288 - 289
CAFÉ NOVA 288 - 289 COMPACT 290 - 291 ISLA 224 - 225
LATTE 288 - 289
MONOCHROME 282 - 285
PROFILE 242 - 243
STONECAST 62 - 99
STONECAST PATINA 130 - 143
STUDIO PRINTS HOMESPUN 196 - 199
INTRODUCTION 296 - 297
FUTURE CARE 308 - 311
IGNEOUS 316 - 319
MENU PORCELAIN 304 - 307
MENU SHADES BEVERAGE 302 - 303
MENU SHADES CALDERA 298 - 301
RUSTICS SIMMER 314 - 315
RUSTICS SNUG MUGS 312 - 313
MELAMINE 324 - 331
WOOD 332 - 341
BAMBOO GLASS TABLEWARE 238 - 239
ISLA GLASS TABLEWARE 226 - 227
INTRODUCTION 342 - 343
AGANO 344 - 345 BAMBOO 360 - 361
COOPER 362 - 363 EVOLVE 350 - 351 ISLA 356 - 357 PROFILE 354 - 355
RAKU 352 - 353 STONECAST 348 - 349 TANNER 358 - 359 TRACE 346 - 347
OUR ENVIRONMENT 364 - 365
FEATURES & BENEFITS INDEX 366 - 369 BADGING 370
ADDITIONS
STUDIO PRINTS RAKU 160 - 161
ULTIMO 286 - 287
VINTAGE PRINTS 206 - 207
WHITE HOLLOWARE 292 - 295
Within the hospitality sector, the choice of tableware must meet the highest standards for presentation, practicality and performance. Over 225 years of innovation, passion and expertise make Churchill the natural partner for providing tabletop solutions.


Dentro del sector hostelero, la vajilla debe alcanzar los estándares más elevados de presentación, practicalidad y durabilidad. Con más de 225 años de innovación, pasión y experiencia, Churchill resulta la elección natural para todas sus necesidades de vajilla.
Innerhalb des Gastgewerbes muss die Auswahl des Geschirrs den höchsten Ansprüchen an Präsentation, Praktikabilität und Leistung genügen. Über 225 Jahre Innovation, Passion und Know-how machen Churchill zum natürlichen Partner für den Tabletop.
Nel settore dell’hospitality, la scelta delle stoviglie per la tavola deve rispettare gli standard più alti di presentazione, praticità e performance. Oltre 225 anni di innovazione, passione e competenza hanno reso Churchill la scelta naturale per trovare soluzioni perla tavola.
Dans le secteur d’hospitalité, le choix de vaisselle doit se conformer aux critères de qualité pour présentation, fonctionnalité et performance. Avec plus de 225 ans d’innovation, passion et expertise Churchill font le partenaire naturel pour tous les solutions de vaisselle.
The Churchill Super Vitrified body is one of the strongest in the world, delivering presentation that lasts. A comprehensive collection of ranges from classic white to contemporary glaze effects in a variety of shapes. The Churchill Super Vitrified collection offers solutions for fast moving, professional back of house environments.
Fashion for food
Our Brands...
Delivering style without compromise, the full and varied Art de Cuisine range is designed for the demanding hospitality environment. A blend of classic and contemporary shapes in white and coloured finishes enhance food presentation. The extensive range in vitrified porcelain and vitrified stoneware delivers individuality and value to professional caterers. Passionate about food
page 14 CUTLERY

A premium tableware collection, Alchemy Performance Fine China is designed for elevated and refined food presentation. Manufactured in the UK, Alchemy offers the perfect balance of design and performance. The unique Alchemy formula creates one of the strongest ceramics in the world*, with the optimum level of added alumina and the highest quality fine china clay. Alchemy is a sophisticated collection that is designed to perform.
* Based on MOR
the dining experience page 342
Exclusively designed in-house, Churchill cutlery has been specifically created for the hospitality environment. Manufactured in high quality 18/10 stainless steel with a premium polished finish, Churchill cutlery meets the highest standards in performance.
Fully stocked in the UK, with all the benefits of the Churchill continuity and service promise. Offered in a variety of designs to enhance the dining experience and complement the Churchill ceramics portfolio.

* * Based on MOR
Churchill’s UK manufactured tableware is precisely engineered to perform to the demands of the hospitality environment. Every step in the process is practised and refined. From the sourcing of raw materials and unique formulation of the clay body, to shape engineering and numerous quality checks ensuring that Churchill products work as hard as you do.
Fabricada en el Reino Unido, la vajilla de Churchill está diseñada con precisión para cumplir con las demandas del entorno de la hostelería. Cada paso del proceso se prueba y se refina. Desde la recepción de las materias primas y la formulación única del cuerpo cerámico, hasta la ingeniería de la forma y los numerosos controles de calidad para garantizar que los productos Churchill trabajen tan duro como usted. Los mejores chefs de la industria eligen a Churchill por encima de otras marcas debido al rendimiento, la experiencia y el diseño de nuestras cerámicas que agregan valor a sus operaciones hosteleras.
Das in Großbritannien hergestellte Geschirr von Churchill ist genau auf die Anforderungen des Gastgewerbes abgestimmt. Jeder Arbeitsschritt wird praktiziert und verfeinert.Wir stellen sicher, dass von der Rohstoffbeschaffung über die einzigartige Rezeptur des Tonmaterials bis hin zur Formgestaltung und den zahlreichen Qualitätskontrollen unsere Churchill-Produkte mit Ihrer harten Arbeit mithalten können. Die Spitzenköche der Branche bevorzugen Churchill gegenüber anderen Marken aufgrund der Leistung, des Know-hows und des Designs unserer Keramiken, da diese die Qualität ihres Gastgewerbes erhöhen.
Prodotte nel Regno Unito, le stoviglie di Churchill sono accuratamente progettate per soddisfare le esigenze delle strutture ricettive. Ogni fase del processo viene sperimentata e perfezionata. Dall’approvvigionamento delle materie prime e dalla formula esclusiva dell’argilla alla progettazione delle forme e ai numerosi controlli qualità, per garantire che i prodotti Churchill lavorino duramente, proprio come te. I migliori chef preferiscono Churchill agli altri marchi, grazie alle prestazioni, alla competenza ed al design della nostra ceramica, tutte cose che aggiungono valore alle loro attività di accoglienza.
Fabriquée au Royaume-Uni, la vaisselle Churchill est conçue précisément pour répondre aux exigences du milieu hôtelier. Nous mélangeons une expérience acquise au fil de centaines d’années à une technologie de pointe et au design. Des contrôles de qualité garantissent que les 70 000 pièces que nous fabriquons chaque jour soient les meilleurs produits sur le marché. Nos produits travaillent aussi durement que vous.
Our unique clay recipe is essential in creating a strong and durable product for the hospitality industry. Our raw materials are selected to deliver the optimum balance of strength and whiteness.
Every piece of Churchill’s ceramic is designed with performance in mind. Through expert shape engineering, we reinforce strength and durability while continual investment in technology guarantees functionality and consistent quality.
100% of Churchill’s ceramics are vitrified which is essential to the hospitality industry. Through the process of vitrification, the particle structure of our ceramic body becomes strong, dense and watertight
Our glaze is hard wearing and designed specifically for the hospitality environment. The durability is a combination of the glaze recipe, the firing temperature and substrate. Our Eco Glaze is specially formulated to be re-usable, minimising our impact on the environment.

Churchill ceramics are continuously tested and quality checked, from the stage of raw materials, throughout the manufacturing process to the final fired piece
Churchill are experts in ceramic design and at the forefront of innovation. Our entire product portfolio is designed in the UK by our experienced and talented design team. We work with chefs from around the world ensuring we understand the needs of our customers.
At Churchill we are dedicated to reliability, ensuring our product is in stock and delivered on time. We pride ourselves on our stock levels and ability to deliver on time, all around the world.

Established in 1795, Churchill have been manufacturing ceramics in Stoke on Trent, England for 225 years.


we blend centuries of experience with cutting edge technology and design innovation to produce one of the strongest ceramic bodies in the world.
materiales materiali aD
Nuestra receta única de arcilla es esencial para crear un producto fuerte y resistente para la industria hostelera. Nuestras materias primas se seleccionan para ofrecer el equilibrio óptimo de resistencia y blancura.
Cada pieza de cerámica de Churchill está diseñada con rendimiento en mente. A través del diseño y la ingeniería, reforzamos la resistencia y durabilidad, mientras que la inversión continua en tecnología garantiza la funcionalidad y la calidad constante.
El 100% de la cerámica de Churchill está vitrificada, lo cual es esencial para la industria hostelera. A través del proceso de vitrificación, la estructura de partículas de nuestro cuerpo cerámico se vuelve fuerte, densa e impermeable.
La formula esclusiva della nostra argilla è essenziale per creare un prodotto resistente e durevole per il settore alberghiero. Selezioniamo le nostre materie prime per garantire un equilibrio ottimale traresistenza e bianchezza.

Ogni pezzo di ceramica Churchill è progettato per fornire le massime prestazioni. Grazie ad una esperta progettazione della forma, aumentiamo la resistenza e la durata, mentre il continuo investimento in tecnologia garantisce funzionalità e qualità costante.
Il 100% delle ceramica Churchill è vetrificato, cosa essenziale per il settore alberghiero. Il processo di vetrificazione conferisce alle particelle costitutive della nostra ceramica proprietà di resistenza, densità e impermeabilità
Nuestro esmalte es resistente y está diseñado específicamente para el entorno hostelero. La durabilidad es una combinación de la receta de esmalte, la temperatura de cocción y el sustrato. Nuestro Esmalte Eco está especialmente formulado para ser reutilizable, minimizando nuestro impacto en el medio ambiente.


La cerámica de Churchill se revisa continuamente para verificar la calidad, desde la etapa de las materias primas, durante todo el proceso de fabricación hasta la pieza final.
Churchill son expertos en diseño cerámico y están a la vanguardia de la innovación. Nuestra gama de productos está diseñada en el Reino Unido por nuestro talentoso equipo de diseño. Trabajamos con chefs a nivel global para garantizar que comprendamos las necesidades de nuestros clientes.
Il nostro smalto è resistente e appositamente studiato per le strutture ricettive. La durata nasce da una combinazione tra formula dello smalto, temperatura di cottura e substrato. Il nostro smalto Eco Glaze è appositamente formulato per essere riutilizzabile, riducendo al minimo l’impatto ambientale.

La ceramica Churchill viene costantemente sottoposta a test e controlli di qualità, dalle materie prime iniziali, durante l’intero processo di produzione, fino al pezzo cotto finale.
Noi di Churchill siamo esperti nella progettazione della ceramica e all’avanguardia nell’innovazione. Tutta la nostra gamma prodotti è progettata nel Regno Unito dal nostro team di disegnatori di grande esperienza e talento. Collaboriamo con gli chef di tutto il mondo per essere sicuri di comprendere le esigenze dei nostri clienti.
En Churchill estamos dedicados a la confiabilidad, asegurando que nuestro producto esté en stock y entregado a tiempo. Nos enorgullecemos de nuestros niveles de estocaje y de nuestra capacidad de entregar a tiempo, en todo el mundo.
Establecida en 1795, Churchill ha estado fabricando cerámica en Stoke on Trent, Inglaterra durante 225 años.
In Churchill ci impegniamo per essere sempre piu’ affidabili, garantendo la disponibilità dei prodotti a magazzino e la puntualità delle consegne. Ci vantiamo dei nostri livelli di scorte e della nostra capacità di effettuare consegne puntuali in ogni parte del mondo.
Fondata nel 1795, Churchill produce ceramica a Stoke on Trent, Inghilterra, da 225 anni.
Notre pâte unique est indispensable pour la création d’une assiette blanche, robuste et résistante. Les contrôles permanents menés sur nos matières premières garantissent la conformité, la fiabilité et la performance de nos produits.
Chaque produit céramique de la gamme Churchill est conçu pour être performant. Grâce au design et à l’ingénierie, nous renforçons la résistance et la longévité. Nous investissons en permanence dans la technologie ce qui garantit la fonctionnalité et la qualité supérieure de nos produits.
La vitrification est un point clé pour la céramique dans le secteur de la restauration. Les produits de la gamme Churchill sont vitrifiés à 100 %. La réduction d’air entre les particules donne une structurerobuste, hermétique, hydrofuge et apte à la nourriture.
Unser einzigartiges Tonrezept ist für die Herstellung robuster und strapazierfähiger Gastronomie- Produkte unerlässlich. Unsere Rohmaterialien werden sorgfältig ausgewählt, damit wir Ihnen die bestmögliche Kombination von Robustheit und Weiße bieten können.


Bei der Entwicklung jedes ChurchillKeramik-Artikels steht die Leistung im Vordergrund. Durch fachkundige Formgestaltung stärken wir die Robustheit und Haltbarkeit und wir investieren laufend in unsere Technologie, um Ihnen Funktionalität und gleichbleibende Qualität zu gewährleisten.
Churchill Keramik ist zu 100 % verglast. Wir wissen, dass dies in der Gastronomie unerlässlich ist. Der Verglasungsprozess macht die Partikelstruktur unserer Keramik robuster, dichter und wasserundurchlässig.
Notre émaillage est résistant à l'usure et conçu spécifiquement pour le secteur hôtelier. Le secret de la longévité est l’alliance de la recette d’émaillage, la température de cuisson et le support utilisé. Notre émaillage écologique est conçu spécifiquement pour être réutilisé, minimisant ainsi les incidences sur notre environnement.
Nous savons que nos produits sont performants parce que nous contrôlons au quotidien la vitrification, la résistance aux ébréchures, la résistance aux détergents industriels, l’étanchéité, la sécurité alimentaire et la régularité des tailles et des formes.
Churchill investit constamment dans la recherche et le développement, nous sommes experts en céramique et est aux avants postes en terme d'innovation. Toute notre gamme de produits est conçue au RoyaumeUni par une équipe expérimentée et talentueuse. Nous travaillons avec des chefs internationaux pour comprendre les besoins de nos clients.
Unsere Glasur ist verschleißfest und speziell für den Gebrauch in der Gastronomie entwickelt.
Die Widerstandsfähigkeit ist eine Kombination unseres Glasurrezepts, Brenntemperatur und Substrat. Unsere Öko-Glasur ist speziell formuliert und daher wiederverwendbar, wodurch unsere Auswirkungen auf die Umwelt minimiert werden.

Churchill Keramik wird kontinuierlich getestet und auf Qualität geprüft, von den Rohmaterialien, über den gesamten Herstellungsprozess bis hin zum fertig gebrannten Keramikartikel.
Hier bei Churchill sind wir Experten im Keramikdesign und stehen an der Spitze in Bezug auf Innovation. Unser komplettes Produktportfolio wird von unserem talentierten und erfahrenen Designteam vollständig hier im Vereinigten Königreich entworfen. Wir arbeiten mit Küchenchefs aus der ganzen Welt zusammen, um die Anforderungen unserer Kunden besser zu verstehen.

Nous nous engageons à assurer la fiabilité en veillant à ce que les commandes soient livrées intégralement et à temps. Nous sommes fiers de nos approvisionnements et de notre aptitude de livrer à temps, partout dans le monde.
Nous fabriquons des produits céramiques depuis 1795 à Stokeon-Trent en Angleterre c’est à dire depuis plus de 225 ans.
Wir bei Churchill setzen auf Zuverlässigkeit und stellen sicher, dass unsere Produkte vorrätig sind und pünktlich geliefert werden. Wir sind stolz auf unseren Lagerbestand und unsere Fähigkeit, pünktlich zu liefern und das überall auf der Welt.
Das Unternehmen Churchill wurde 1795 gegründet und stellt seit 225 Jahren in England, in Stoke on Trent, Keramik her.
Churchill are experts in ceramic design and at the forefront of innovation, bringing colour, texture and shape to the hospitality tabletop with several new product launches every year. We understand the importance of innovation, investing in detailed market research, material development and the latest technologies to deliver a continuous pipeline of new tableware. Our entire product portfolio is designed in the UK by our experienced and talented design team, and engineered to deliver strength and performance in the busiest of hospitality environments.
Churchill son expertos en diseño cerámico y están a la vanguardia de la innovación, aportando color, textura y forma a la mesa con varios lanzamientos de productos nuevos cada año. Entendemos la importancia de la innovación, invirtiendo en una investigación detallada del mercado, desarrollo de materiales y las últimas tecnologías para ofrecer una línea continua de nuevos productos para el sector hostelero.Todo nuestro portafolio de productos están diseñados en el Reino Unido por nuestro experimentado y talentoso equipo de diseño, y está diseñado para ofrecer resistencia y rendimiento en los entornos hoteleros más concurridos.
Churchill ist Experte für das Geschirr-Design und steht an der Spitze der Innovation. Jedes Jahr werden mehrmals neue Produkte auf den Markt gebracht, die Farbe, Textur und Form auf den Tisch des Gastgewerbes bringen. Wir sind uns der Bedeutung von Innovationen bewusst und investieren in detaillierte Marktforschung, Materialentwicklung und die neuesten Technologien, um kontinuierlich neues Geschirr zu entwickeln. Unser gesamtes Produktportfolio wird in Großbritannien von unserem erfahrenen und talentierten Designteam entwickelt und so konstruiert, dass es auch in den anspruchsvollsten Umgebungen des Gastgewerbes robust und leistungsfähig ist.
Churchill è esperta nel design della ceramica ed all’avanguardia nell’innovazione apportando colore, consistenza e forma alla tavola della ristorazione con diversi lanci di nuovi prodotti ogni anno. Comprendiamo l’importanza dell’innovazione, degli investimenti in approfondite ricerche di mercato, nello sviluppo dei materiali e nelle ultime tecnologie per garantire la continuità di nuovi articoli per la tavola. Il nostro intero assortimento è progettato nel Regno Unito dal nostro valido ed esperto team di progettazione e realizzato per garantire resistenza e prestazioni negli ambienti più impegnativi della ristorazione.
Churchill est expert en design céramique et à la pointe de l’innovation. Les lancements de produits chaque année présentent des assiettes aux nouvelles couleurs, textures et formes. Nous avons à coeur de garder en tête la notion d’innovation en investissant dans des études de marché détaillées, dans le développement de matériaux et les dernières technologies pour proposer régulièrement de nouveaux articles d’art de la table. L’ensemble de notre portefeuille de produits est conçu au Royaume-Uni par notre équipe design expérimentée et talentueuse. Nos produits sont conçus pour offrir résistance et performance dans les environnements de l’hôtellerie restauration les plus exigeants..


Product featured is Alchemy White.
Manufactured in the UK, Alchemy Performance Fine China is designed for elevated and refined food presentation, offering the perfect elegant tabletop solution for all manner of hotel food service areas.

Fabricado en el Reino Unido, Alchemy Performance Fine China está diseñado para una presentación de alimentos elevada y refinada, ofreciendo la solución de mesa perfecta y elegante para todo tipo de áreas de servicio de alimentos en hoteles.
Alchemy wird in Großbritannien hergestellt und bietet die perfekte Balance aus Design und Performance. Die elegante Lösung für alle Gastronomiebereiche im Hotel, vom Frühstücksservice bis zum Banqueting und Event-Catering.
Prodotto nel Regno Unito, Alchemy offre il perfetto equilibrio tra design e prestazioni, la soluzione ottimale per le diverse aree F&B dell’hotel.
Cette collection Alchemy est fabriquée au Royaume-Uni et offre un parfait équilibre entre design et performance, propose une solution de table élégante et parfaite pour tous les types de services de restauration des hôtels.
Designed for contemporary dining settings, Alchemy Abstract features a fresh geometrical embossment on pure white vitrified fine china. Alchemy Abstract is a high performing and functional collection, the added alumina in the fine china body enhances both strength and whiteness.








SERVICE PLATE
APRDUS131 33cm 13" CTN QTY 6 €50.31

PLATE
APRDUP111 30cm 11¾" CTN QTY 12 €26.63
APRDUP581 26.8cm 10⅝" CTN QTY 12 €18.19
PLATE
APRDUP101 25.4cm 10" CTN QTY 12 €16.43 APRDUP9 1 23cm 9" CTN QTY 12 €14.44
PLATE

APRDUP8 1 20.3cm 8" CTN QTY 12 €12.63
APRDUP651 16.2cm 6½" CTN QTY 12 €10.28
ROUND PASTA BOWL
APRDUPRB1 30.5cm 12" 79.7cl 28oz CTN QTY 12 €32.72
RIMMED SOUP BOWL

APRDUB9 1 24.5cm 9¾" 49.5cl 17oz CTN QTY 12 €16.55
STACKING TEACUP
APRDUSC71 20.6cl 7oz H: 6.6cm Dia: 8cm CTN QTY 12 €10.36
TEA/COFFEE CUP
€11.62
ESPRESSO CUP
Contemporary Elegance
Alchemy Abstract Feature Pieces showcase a striking and contemporary linear embossment on white vitrified performance fine china. These stylish shapes are the perfect statement items for premium food presentation, complementing existing Alchemy ranges such as Alchemy Abstract and White.




COUPE PLATE APRDAF581 27.2cm 10¾” CTN QTY 6 €25.97
COUPE PLATE APRDAF9 1 23.5cm 9 ” CTN QTY 6 €19.51




COUPE BOWL APRDAF101 27.1cm 10¾” 118cl 40oz CTN QTY 6 €34.74
COUPE BOWL APRDAF8 1 21cm 10¾” 59cl 20oz CTN QTY 6 €21.77
A stylish and elegant range of finer, lighter Alchemy plates, bowls and beverage pieces, Ambience is especially designed for fine dining creating the perfect canvas for food presentation. It works beautifully with the existing Alchemy range.










STANDARD RIM PLATE
APRAF1251 31.7cm 12½"
Food Presentation area: 21.5cm 8½" CTN QTY 6 €34.19
STANDARD RIM PLATE
APRAF1151 28cm 11"
Food Presentation area: 18.5cm 7¼" CTN QTY 6 €27.38
STANDARD RIM PLATE
APRAF8 1 21.7cm 8½"
Food Presentation area: 14cm 5½" CTN QTY 6 €18.26
STANDARD RIM PLATE
APRAF7 1 18.4cm 7¼"
Food Presentation area: 11.5cm 4½" CTN QTY 6 € 16.02
STANDARD RIM PLATE
APRAF6 1 16.2cm 6"
Food Presentation area: 10.5cm 4⅛" CTN QTY 6 €11.02
MEDIUM RIM PLATE






APRAF1171 28cm 11"
Food Presentation area: 14cm 5½" CTN QTY 6 €31.97
WIDE RIM PLATE
APRAF1191 28cm 11"
Food Presentation area: 11cm 4⅜" CTN QTY 6 €31.97
STANDARD RIM BOWL
APRAB1251 31.7cm 12½" 85cl 30oz Food Presentation area: 22cm 8½" CTN QTY 6 €30.88
STANDARD RIM BOWL
APRAB1151 28cm 11" 51.1cl 18oz
Food Presentation area: 18.5cm 7¼"
CTN QTY 6 €31.98
STANDARD RIM BOWL
APRAB7251 22cm 8½" 28.4cl 10oz
Food Presentation area: 14.5cm 5½" CTN QTY 6 €15.31
MEDIUM RIM BOWL
APRALB121 31.7cm 12½" 42.6cl 15oz
Food Presentation area: 16.5cm 6½" CTN QTY 6 €42.83
MEDIUM RIM BOWL
APRAB1171 28cm 11" 28.4cl 10oz
Food Presentation area: 14.5cm 5½" CTN QTY 6 €32.92
Price shown is price per piece
WIDE RIM SQUARE PLATE

APRASPW 1 21cm 8¼"
Food Presentation area: 11cm 4⅜"
CTN QTY 6 €28.68
MEDIUM RIM SQUARE PLATE
APRASPM 1 21cm 8¼"
Food Presentation area: 14.5cm 5¾"
CTN QTY 6 €28.68
SQUARE BOWL
APRABSM 1 21cm 8¼" 28.4cl 10oz
Food Presentation area: 14.5cm 5⅝" CTN QTY 6 €32.07
FINE TEACUP
APRAAFC81 22.7cl 8oz H: 6cm Dia: 10cm CTN QTY 6 €9.37
STANDARD RIM TEA SAUCER

APRAAFS61 16.5cm 6½" CTN QTY 6 €6.49 (Fits APRAAFC81)
CAN TEA CUP
APRAACT 1 22.7cl 8oz H: 6.5cm Dia: 8cm CTN QTY 6 €12.03
CAN TEA SAUCER
APRAATCS1 16.5cm 6½" CTN QTY 6 €8.31 (Fits APRAACT 1)

CAN COFFEE CUP

APRAACF 1 12.5cl 4.5oz H: 6cm Dia: 6.5cm
CTN QTY 6 €9.91
CAN COFFEE SAUCER
APRAACCS1 13.5cm 5½"
CTN QTY 6 €7.65 (Fits APRAACF 1)
CAN MUG
APRAACM 1 28.4cl 10oz H: 8cm Dia: 7.5cm
CTN QTY 6 €12.61
OVAL TEAPOT
APRAOT251 71cl 25oz H: 13.5cm
CTN QTY 6 €39.96
REPLACEMENT LID APRAOL251 CTN QTY 6 €9.87

OVAL TEAPOT
APRAOT151 42.6cl 15oz H: 12cm CTN QTY 6 €33.09
REPLACEMENT LID APRAOL151 CTN QTY 6 €9.87
OVAL COFFEE POT






APRAOC181 51.1cl 18oz H: 15.5cm CTN QTY 6 €39.96
REPLACEMENT LID APRAOL181 CTN QTY 6 €9.87
OVAL JUG
APRAOJ101 28.4cl 10oz H: 12cm CTN QTY 6 €17.13
OVAL JUG
APRAOJ5 1 14.2cl 5oz H: 7.5cm CTN QTY 6 €14.84
OVAL JUG


APRAOJ2 1 7.1cl 2oz H: 5.5cm CTN QTY 6 €12.56
OVAL COVERED
SUGAR BOWL
APRAOCS61 17cl 6oz H: 9cm
CTN QTY 6 €18.26
REPLACEMENT LID APRAOSL61






CTN QTY 6 €9.87
FINE SUGAR BOWL
APRAOSBF1 22.7cl 8oz H: 6cm Dia: 10cm
CTN QTY 6 €10.10
OVAL SALT
APRAAOS 1 H: 4.5cm
CTN QTY 6 €11.43
OVAL PEPPER APRAAOP 1 H: 4.5cm
CTN QTY 6 €11.43
BUTTER BLOCK
APRAFBB 1 2.8cl 1oz H: 4.5cm Dia: 5.8cm
CTN QTY 12 €6.87
Premium and timeless Alchemy White has been designed with versatility and functionality in mind. Simply appealing, this pure white fine china collection features a comprehensive solution for events catering and hotel dining.
















STACKING COFFEE CUP
APR ASC61 17cl 6oz H: 6cm Dia: 7.5cm
CTN QTY 24 €9.01
STACKING TEACUP
APR ASC71 20.6cl 7oz H: 6.6cm Dia: 8cm
CTN QTY 24 €9.01
ELEGANT CUP
APR AEC71 20.6cl 7oz H: 6.5cm Dia: 8.5cm
CTN QTY 24 €9.72
TEA/COFFEE CUP


APR ATC81 22cl 8oz H: 6cm Dia: 10cm CTN QTY 24 €10.10
CAPPUCCINO CUP
APR ACC 1 34cl 12oz H: 6.5cm Dia: 11cm CTN QTY 24 €11.69
CAPPUCCINO CUP
APR ACC81 22cl 8oz H: 6cm Dia: 10cm CTN QTY 24 €10.00
TEA SAUCER
APR AS6 1 15.3cm 6" CTN QTY 24 €6.18 (Fits APR ASC6 1, APR ASC71, APR AEC71, APR ATC81, APR ACC 1 & APR ACC81)
COUPE TEA SAUCER


APR ACS61 15.3cm 6" CTN QTY 24 €6.18 (Fits APR ASC6 1, APR ASC71, APR AEC71, APR ATC81, APR ACC 1 & APR ACC81)
STACKING COFFEE CUP
APR ASC31 8.3cl 3oz H: 5cm Dia: 6cm CTN QTY 24 €8.23
ESPRESSO CUP
APR AEC31 8.5cl 3oz H: 5.5cm Dia: 6.5cm
CTN QTY 24 €8.23
COFFEE SAUCER
APR AS5 1 12.8cm 5" CTN QTY 24 €5.61 (Fits APR ASC31, APR AEC31)
STACKING MUG
APR AM101 28.4cl 10oz H: 9cm Dia: 8cm CTN QTY 24 €10.55
MUG
APR AM 1 28cl 10oz H: 10.5cm Dia: 8cm CTN QTY 24 €10.86
TEAPOT
APR AT361 1lt 36oz H: 13cm
CTN QTY 6 €51.52
REPLACEMENT LID
APR ATL31 CTN QTY 6 €12.33 (Fits APR AT361)
TEAPOT
APR AT251 71cl 25oz H: 10.5cm CTN QTY 6 €46.12
REPLACEMENT LID
APR ATL21 CTN QTY 6 €12.33 (Fits APR AT251)
TEAPOT




APR AT151 42.6cl 15oz H: 9cm CTN QTY 6 €35.16
REPLACEMENT LID APR ATL11 CTN QTY 6 €12.33 (Fits APR AT151)











COFFEE POT
APR AC361 1lt 36oz H:17cm
CTN QTY 6 €53.18
REPLACEMENT LID
APR ACL11
CTN QTY 6 €12.33 (Fits APR AC361)
COFFEE POT
APR AC181 51.1cl 18oz H: 11cm
CTN QTY 6 €47.53
REPLACEMENT LID
APR ACL 1
CTN QTY 6 €12.33 (Fits APR AC181)
JUG
APR AJ101 28cl 10oz H: 9cm
CTN QTY 6 €18.57
APR AJ5 1 13.8cl 5oz H: 6.5cm
CTN QTY 6 €15.45
APR AOSB1 22cl 8oz H: 6.5cm Dia: 8.5cm
CTN QTY 6 €9.31
COVERED SUGAR BOWL
APR ACSB1 22cl 8oz H: 7.5cm Dia: 10.5cm CTN QTY 6 €21.74
REPLACEMENT LID
APR ALS 1
CTN QTY 6 €12.33
SAUCE BOAT
APR AB121 34cl 12oz H: 8.5cm Dia: 18cm CTN QTY 6 €29.97
MINI SAUCE BOAT
APR AB5 1 14.2cl 5oz H: 6cm Dia: 13.5cm
CTN QTY 6 €19.36
CONSOMMÉ BOWL


UNHANDLED
APR AUCB1 28.4cl 10oz H: 5.5cm Dia: 10cm
CTN QTY 24 €11.29
CONSOMMÉ BOWL HANDLED





APR AHCB1 28.4cl 10oz H: 5.5cm Dia: 10cm
CTN QTY 24 € 15.00
CONSOMMÉ STAND
SAUCER

APR AS6 1 15.3cm 6"
CTN QTY 24 €6.18
SUGAR SACHET HOLDER
APR ASSH1 11.3 x 7.3cm 5" x 3"
CTN QTY 6 €17.29
BUTTER PAD/ BALANCE TEA SAUCER

APR ABP 1 10.2cm 4"
CTN QTY 12 €6.32
SALT
APR AS 1 6cm 2¼"
CTN QTY 6 €14.49
PEPPER
APR AP 1 6cm 2¼"
CTN QTY 6 €14.49
EGG CUP
APR AEC 1 7cl 2oz H: 4.5cm Dia: 4.5cm
CTN QTY 6 €5.53
BUD VASE
APR ABV 1 12.5cm 4⅞" CTN QTY 6 €18.75
Alchemy Balance provides a perfect minimal platform for elevated food presentation. The premium white colour of the Alchemy fine china body and the simplistic Balance shapes create a fresh, blank canvas for all manner of cuisines.


















Add style and creativity to the tabletop with a beautiful range of bowls and plates inspired by the soft, organic curves of nature. Moonstone offers great flexibility and works across many different types of cuisine from fine dining to deli-buffet displays.




BOWL
APRSMB401 24.6 x 18.2cm 9¾" x 7¼" 112.4cl 40oz CTN QTY 6 €44.08
BOWL
APRSMB301 20.3 x 15.7cm 7⅞" x 6⅛" 85.2cl 30oz CTN QTY 6 €41.34
BOWL APRSMB201 17.7 x 13.2cm 7" x 5⅜" 56.8cl 20oz CTN QTY 12 €34.46







BOWL
APRSMB101 10.5 x 14.3cm 5⅝" x 4⅛" 28.4cl 10oz CTN QTY 12 €23.43
OVAL PLATE
x 35.5cm
OVAL PLATE
APRSMP111 21.5 x 28.8cm 8¼" x 11¼" CTN QTY 6 €33.08
OVAL PLATE








APRSMP7 1 14.5 x 19cm 5⅞" x 7½" CTN QTY 12 €20.68

Urban Chic
This stylish collection of contemporary, square and rectangular shaped plates and bowls is designed to integrate with the Alchemy White range. With chic elegance and the pure whiteness of fine china, it offers many exciting possibilities to enhance food presentation.



SQUARE PLATE

APR ASDP1 28cm 11" CTN QTY 6 €37.87
SQUARE PLATE APR ASP91 23.3cm 9" CTN QTY 6 €30.45

SQUARE PLATE APR ASSP1 17.7cm 7" CTN QTY 6 €20.86




SQUARE PLATE APR ASP51 13.2cm 5¼" CTN QTY 12 €11.64
SQUARE PASTA BOWL APR ASPB1 25.4cm 10" 71cl 25oz CTN QTY 6 €37.87
SQUARE BUFFET BOWL APR ASHB1 26.5cm 10½" 119cl 42oz CTN QTY 4 €59.61
SQUARE BOWL APR ASLB1 20.3cm 8" 56.8cl 20oz CTN QTY 6 €25.42




SQUARE

An elegant beverage range to add a sophisticated touch to the tabletop. In premium white fine china, Sequel is designed to complement the Alchemy and Ambience tableware collections.

COUPE ESPRESSO SAUCER APR CS5 1 12.5cm 5" CTN QTY 12 €6.11 (Fits APR C3 1)


COUPE TEA SAUCER
APR ACS61 15.3cm 6" CTN QTY 24 €6.18 (Fits APR AT161 APR AT121 APR ATC81)
TEAPOT APR TE161 42cl 15oz H: 9.8cm CTN QTY 6 €36.72 REPLACEMENT LID APR AL161 CTN QTY 6 €11.04




COFFEE POT
APR CP211 59cl 21oz H: 13.5cm CTN QTY 6 €48.94 REPLACEMENT LID APR AL211 CTN QTY 6 €11.04


COVERED
SUGAR BOWL APR CSB21 20cl 7oz H: 8.5cm CTN QTY 6 €20.39 REPLACEMENT LID APR CSBL1 CTN QTY 6 €11.04
Our Alchemy Plate Towers have been designed to provide the ultimate presentation for an array of shared dining experiences. Use for traditional Afternoon Tea, unique cheese board presentation or as a premium tapas centrepiece, these plate towers add interest to any tabletop.






THREE TIER PLATE TOWER*
APRAFPT31 Top Plate: 16.2cm 6"
Middle Plate: 21.7cm 8"
Bottom Plate: 28cm 11" Height: 33cm 13"
CTN QTY 2 €103.20
TWO TIER PLATE TOWER*
APRAFPT21
Top Plate: 21.7cm 8"
Bottom Plate: 28cm 11" Height: 22cm 8½"
CTN QTY 2 €80.28
LARGE RECTANGULAR PLATE TOWER*
APRBAPT21 Top Plate: 30 x 14.5cm 11¾" x 5¾"

Bottom Plate: 56 x 15.3cm 22" x 6" Height: 22cm 8½"
CTN QTY 2 €137.60
SMALL RECTANGULAR PLATE TOWER*

APRBAPT61
Top Plate: 17 x 10cm 6¾" x 3⅞"
Bottom Plate: 30 x 14.5cm 11¾" x 5¾" Height: 22cm 8½"
CTN QTY 2 €80.28
Create a signature style with our contemporary rectangular and organic tiles. Available in premium white and striking colour designs, perfect for canapes, starters, desserts and sharing plates.




SIGNATURE TILE
APR ATE 1 26.5 x 17cm
10⅝" x 6⅝"
CTN QTY 4 €22.01
GREY MARBLE TILE

MGY ATE 1 26.5 x 17cm 10⅝" x 6⅝"
CTN QTY 4 €30.02
CRANBERRY ROSE CHINTZ TILE
RCC ATE 1 26.5 x 17cm 10⅝" x 6⅝"
CTN QTY 4 €30.02
RECTANGULAR TILE
APR RST 1 37.6 x 14cm 14¾" x 5½"
CTN QTY 4 €34.13
(Fits Wooden Boards ZCAWWBDD1 and ZCAWLWSB1)




GREY MARBLE RECTANGULAR TILE


MGY RST 1 37.6 x 14cm
14¾" x 5½"
CTN QTY 4 €42.03
(Fits Wooden Boards ZCAWWBDD1, and ZCAWLWSB1)
PRAGUE ROSE CHINTZ RECTANGULAR TILE



RCP RST 1 37.6 x 14cm
14¾" x 5½"
CTN QTY 4 €42.03
(Fits Wooden Boards ZCAWWBDD1, and ZCAWLWSB1)

TOPAZ
QUARTZ
ACACIA
LARGE WOODEN DELI BOARD
ZCAWWBDD1 40 x 16.5cm 15¾" x 6½"
CTN QTY 4 €32.40
(Compatible with: APR RST 1, MGY RST 1, RCP RST 1, RKTBRST
A pure white canvas graced by a subtly embossed border. Jardin is a classic design with a timeless appeal that brings sophistication to the dining experience. Perfect for a fine dining restaurant environment.





Price shown is price per piece
PLATE
APREEP111 30cm 11¾"
CTN QTY 12 € 26.24
APREEP581 26.8cm 10⅝" CTN QTY 12 €18.23
APREEP101 25.4cm 10"
CTN QTY 12 €16.37
PLATE
APREEP9 1 23cm 9"
CTN QTY 12 €14.47
APREEP8 1 20.3cm 8" CTN QTY 12 €12.62
APREEP651 16.2cm 6½"
CTN QTY 12 €10.33
RIMMED SOUP BOWL
APREEB9 1 23cm 9" 49.5cl 17oz
CTN QTY 12 €16.26
ROUND BOWL
APREEB6 1 16.2cm 6½" 22cl 8oz CTN QTY 12 €10.55
CONSOMMÉ BOWL
UNHANDLED APREEUCB1 28.4cl 10oz H: 5.5cm Dia: 10cm CTN QTY 24 €12.98
CONSOMMÉ
STAND / SAUCER APREES6 1 15.3cm 6" CTN QTY 24 €7.01







STACKING TEACUP
APREESC71 20.6cl 7oz H: 6.6cm Dia: 8cm CTN QTY 24 €10.42
ELEGANT CUP
APREEEC71 20.6cl 7oz H: 6.5cm Dia: 8.5cm CTN QTY 24 €11.08
COUPE TEA/ COFFEE SAUCER

APREECS61 15.3cm 6" CTN QTY 24 €7.01 (Fits APREESC71, APREEEC71)
TEA SAUCER
APREES6 1 15.3cm 6" CTN QTY 24 €7.01 (Fits APREESC71, APREEEC71)
Understated elegance is the charm of Mono, with a minimalist black line making a striking contrast to the white body of Alchemy fine china, creating a modern and contemporary feel. Gold and Platinum lines are available to order across the whole Alchemy range, adding an extra dash of luxury and style.


















CONSOMMÉ BOWL
UNHANDLED
AUCB1 28.4cl 10oz H: 5.5cm Dia: 10cm
CTN QTY 24 €15.65
CONSOMMÉ BOWL HANDLED
AHCB1 28.4cl 10oz H: 5.5cm Dia: 10cm CTN QTY 24 €20.42
CONSOMMÉ
STAND/SAUCER
AS6 1 15.3cm 6" CTN QTY 24 €8.53 €9.83

STACKING COFFEE CUP ASC61 17cl 6oz H: 6cm Dia: 7.5cm CTN QTY 24 €12.78
STACKING TEACUP
ASC71 20.6cl 7oz H: 6.6cm Dia: 8cm CTN QTY 24 €11.02 €12.78
ELEGANT CUP
AEC71 20.6cl 7oz H: 6.5cm Dia: 8.5cm CTN QTY 24 €11.78 €13.70
TEA/COFFEE CUP
ATC81 22cl 8oz H: 6cm Dia: 10cm
CTN QTY 24 €14.00
CAPPUCCINO CUP
CAPPUCCINO CUP
ACC81 22cl 8oz H: 6cm Dia: 10cm CTN QTY 24 €14.02
TEA SAUCER
AS6 1 15.3cm 6" CTN QTY 24 €8.53 €9.83 (Fits ASC61, ASC71, AEC71, ATC81, ACC1, ACC81)
COUPE TEA/ COFFEE SAUCER ACS61 15.3cm 6" CTN QTY 24 €9.83 (Fits ASC61, ASC71, AEC71, ATC81, ACC1, ACC81)









STACKING COFFEE CUP
ASC31 8.5cl 3oz H: 5cm Dia: 6cm CTN QTY 24 €11.51
ESPRESSO CUP
AEC31 8.5cl 3oz H: 5.5cm Dia: 6.5cm CTN QTY 24 €9.91 €11.51
COFFEE SAUCER
AS5 1 12.8cm 5" CTN QTY 24 €7.77 €8.77 (Fits ASC31, AEC31)
STACKING MUG
AM101 28.4cl 10oz H: 9cm Dia: 8cm CTN QTY 24 €15.82
ACC 1 34cl 12oz H: 6.5cm Dia: 11cm CTN QTY 24 €16.72 MUG

AM 1 28cl 10oz H: 10.5cm Dia: 8cm CTN QTY 24 €16.46
TEAPOT
Price shown is price per piece OPEN SUGAR BOWL
AT361 1ltr 36oz H: 13cm
CTN QTY 6 €65.19 AT251 71cl 25oz H: 10.5cm CTN QTY 6 €58.03



TEAPOT AT151 42.6cl 15oz H: 9cm CTN QTY 6 €40.04 €44.85




COFFEE POT AC361 1ltr 36oz H: 17cm CTN QTY 6 €66.95
COFFEE POT
AC181 51.1cl 18oz H: 11cm CTN QTY 6 €49.45 €52.71
JUG AJ101 28cl 10oz H: 9cm CTN QTY 6 €25.49
JUG AJ5 1 13.8cl 5oz H: 6.5cm CTN QTY 6 €18.00 €20.76
COVERED SUGAR BOWL ACSB1 22cl 8oz H: 7.5cm Dia: 10.5cm CTN QTY 6 €28.36





AOSB1 22cl 8oz H: 6.5cm Dia: 8.5cm
CTN QTY 6 €10.99 €12.59
SUGAR SACHET HOLDER
ASSH1 11.3 x 7.3cm 5" x 3"
CTN QTY 6 €27.28
SAUCE BOAT
AB121 34cl 12oz H: 8.5m Dia: 18cm
CTN QTY 6 €40.12
MINI SAUCE BOAT AB5 1 14.2cl 5oz H: 6cm Dia: 13.5cm



CTN QTY 6 €25.31
Available in Black Band (AMO)
Available in Gold Band (AGB)
Available in Platinum Band (APB)
BALANCE BUTTER PAD/
TEA SAUCER ABP 1 10.2cm 4" CTN QTY 12 €8.91

SALT
AS 1 6cm 2¼" CTN QTY 6 €19.02 PEPPER AP 1 6cm 2¼" CTN QTY 6 €19.02
Alchemy Platinum & Gold bands are not recommended for dishwasher and microwave use
BUD VASE
ABV 1 12.5cm 4⅞" CTN QTY 6 €26.35
The Alchemy Buffet collection is a creative evolution of shapes, capturing the stunning profiles of Energy, Balance and Moonstone. Combine with our innovative melamine and wood buffet items to add impact to deli style food presentation.

RECTANGULAR CERAMIC BUFFET TRAY
APRBART 1 30 x 14.5cm 11¾" x 5¾"
CTN QTY 6 €32.40
RECTANGULAR CERAMIC BUFFET TRAY
APRBART21 56 x 15.3cm 22" x 6"
CTN QTY 4 €79.79
RECTANGULAR CERAMIC BUFFET TRAY
APRBART31 53 x 32.5cm 20⅞" x 12¾"
CTN QTY 2 €122.58
RECTANGULAR CERAMIC BUFFET TRAY
APRBART41 46 x 10cm 18" x 3⅞"
CTN QTY 4 €68.87
RECTANGULAR CERAMIC BUFFET TRAY
APRBART51 58 x 20cm 22⅞" x 7⅞"
CTN QTY 4 €124.00
RECTANGULAR CERAMIC BUFFET TRAY
APRBART61 17 x 10cm 6¾" x 3⅞"
CTN QTY 6 €23.43
SQUARE CERAMIC BUFFET TRAY
APRBAST 1 30.3 x 30.3cm 11⅞" x 11⅞"
CTN QTY 4 €72.56
HINTS BARLEY WHITE RECTANGULAR BUFFET TRAY SHWHART 1 30 x 14.5cm 11¾" x 5¾"



CTN QTY 6 €33.43
HINTS BARLEY WHITE SQUARE BUFFET TRAY SHWHAST 1 30.3 x 30.3cm 11⅞" x 11⅞"




CTN QTY 4 €74.92
HINTS INDIGO BLUE
RECTANGULAR BUFFET TRAY SHBIART 1 30 x 14.5cm 11¾" x 5¾"
CTN QTY 6 €33.43


HINTS INDIGO BLUE SQUARE BUFFET TRAY SHBIAST 1 30.3 x 30.3cm 11⅞" x 11⅞"
CTN QTY 4 €74.92
HINTS BARLEY WHITE
LARGE COUPE BOWL
SHWHAC141 38.5 x 8.8cm 15¼" x 3½" 500cl 175oz CTN QTY 4 €98.20

HINTS INDIGO BLUE
LARGE COUPE BOWL SHBIAC141 38.5 x 8.8cm 15¼" x 3½" 500cl 175oz CTN QTY 4 €98.20
BALANCE LARGE COUPE BOWL
APRBAC141 38.5 x 8.8cm 15¼" x 3½" 500cl 175oz CTN QTY 4 €95.10
Polycarbonate tray covers available on page 326.

Price shown is price per piece
SQUARE PLATE
APR ASDP1 28cm 11"
CTN QTY 6 €37.87
SQUARE PLATE
APR ASP91 23.3cm 9"
CTN QTY 6 €30.45
SQUARE PLATE
APR ASSP1 17.7cm 7"
CTN QTY 6 €20.86
SQUARE PLATE







APR ASP51 13.2cm 5¼"
CTN QTY 12 €11.64
SQUARE BUFFET BOWL
APR ASHB1 26.5cm 10½" 119cl 42oz
CTN QTY 4 €59.61
SQUARE PASTA BOWL
APR ASPB1 25.4cm 10" 71cl 25oz CTN QTY 6 €37.87
SQUARE BOWL
APR ASLB1 20.3cm 8" 56.8cl 20oz
CTN QTY 6 €25.42
SQUARE BOWL
APR ASSB1 14.2cm 5½" 28.4cl 10oz
CTN QTY 6 €17.02
SQUARE BOWL

APR ASTB1 10.2cm 4" 6cl 2oz
CTN QTY 12 €8.70
RECTANGLE PLATE


APR AE131 33 x 23cm 13" x 9"
CTN QTY 6 €40.42
COUPE PLATE
APRBAC121 30.5cm 12" CTN QTY 6 €25.37
COUPE PLATE
APRBAC581 26.8cm 10⅝" CTN QTY 6 €19.97
COUPE PLATE
APRBAC9 1 23cm 9" CTN QTY 6 €15.00
COUPE PLATE
APRBAC6 1 16.5cm 6½" CTN QTY 6 €10.57
COUPE BOWL
APRBAC141 38.5 x 8.8cm 15¼" x 3½" 500cl 175oz CTN QTY 4 €95.10
COUPE BOWL
APRBAC101 26.5cm 10½" CTN QTY 6 €26.72
COUPE BOWL
APRBAC8 1 20.3cm 8"
CTN QTY 6 €16.75
OVAL PLATE
APRSMP131 26.5 x 35.5cm 10½" x 13⅞"
CTN QTY 6 €52.34
OVAL PLATE
APRSMP111 21.5 x 28.8cm 8¼" x 11¼"
CTN QTY 6 €33.08
OVAL PLATE
APRSMP8 1 16.7 x 22.5cm 6½" x 8⅞"
CTN QTY 12 €24.82














APRSMP7 1 14.5 x 19cm 5⅞" x 7½"
CTN QTY 12 €20.68
BOWL
APRSMB401 24.6 x 18.2cm 9¾" x 7¼" 112.4cl 40oz CTN QTY 6 €44.08
BOWL
APRSMB301 20.3 x 15.7cm 7⅞" x 6⅛" 85.2cl 30oz
CTN QTY 6 €41.34
BOWL
APRSMB201 17.7 x 13.2cm 7" x 5⅜" 56.8cl 20oz
CTN QTY 12 €34.46







BOWL
APRSMB101 10.5 x 14.3cm 5⅝" x 4⅛" 28.4cl 10oz
CTN QTY 12 €23.43
TEAR DISH
APRBATD11 29.3cm 11½" 65.3cl 23oz


CTN QTY 6 €41.76
TEAR DISH
APRBATD91 23.6cm 9¼" 34cl 12oz
CTN QTY 6 €29.61
TEAR DISH
APRBATD61 16cm 6¼" 14.2cl 5oz
CTN QTY 12 €14.49
RICE BOWL
APRBAR161 44cl 16oz H: 7.5cm Dia: 14cm
CTN QTY 12 €13.34
RICE BOWL
APRBARB91 25.6cl 9oz H: 6.5cm Dia: 11cm
CTN QTY 24 €10.00
RICE BOWL
APRBARB41 12.5cl 4oz H: 5cm Dia: 9cm
CTN QTY 24 €8.36
FOOTED SOUP BOWL
APRBAFSB1 34cl 12oz H: 10.5cm Dia: 15cm
CTN QTY 6 €23.68
BUFFET BOAT DISH
APRBAB191 51.8cm 20⅜" 128cl 45oz
CTN QTY 4 €80.60
BUFFET BOAT DISH
APRBAB141 39.2cm 15½" 71cl 25oz
CTN QTY 6 €53.17
BUFFET BOAT DISH
APRBAB111 29cm 11½" 25.5cl 9oz
CTN QTY 6 €32.22
Alchemy Counterwave with its flowing curves is an innovative concept in hot and cold serving ware that enhances all types of counter food display. Designed specifically to sit within gastronorm chilled counters or used free form on hot decks, these beautifully crafted pieces propel food counter display to a new dimension.







Designed by leading British designer Sebastian Conran, the clean, simple lines and shapes of Alchemy Cook & Serve represent a striking and contemporary alternative to traditional cookware. Designed to bring state-of-the-art style to any kitchen or restaurant environment, with ramekins, oval and round dishes offering great flexibility of use.












The Churchill Super Vitrified body is one of the strongest in the world, delivering presentation that lasts. A comprehensive collection of ranges from classic to contemporary, whiteware to coloured glazes. A variety of shapes and sizes to provide your tabletop solution. The Churchill Super Vitrified collection offers solutions for chefs that work in fast moving, professionally disciplined back of house environments.

El cuerpo cerámico de Churchill Super Vitrified es uno de los más fuertes del mundo, entregando una presentación que dura. Una amplia colección de diseños desde clásicos hasta contemporáneos. La colección Churchill Super Vitrified ofrece una solución resistente para aquellos Chefs que trabajan en ambientes profesionales de gran concurrencia y demanda. st OVIG l IE FORMIDA bIl I CHE l AVORANO DURAMEN t E COME VOI…GARAN t I t O
Der Churchill Super Vitrified Body ist einer der stärksten Scherben der Welt und bietet allerhöchste Beständigkeit. Die umfangreiche Kollektion reicht von klassisch bis zeitgenössisch, von Weißware bis zu farbigen Glasuren. Eine Vielzahl von Formen und Größen für Ihre Tabletop-Lösung. Die Churchill Super VitrifiedKollektionen eignen für Gastronomiebetriebe in denen ein intensives Arbeitsaufkommen, zuverlässiges und robustes Geschirr erfordert.
s t RAORDINARIE st OVIG l IE CHE l AVORANO s ODO tAN t O QUAN t O t E ...GARAN t I t O
Il corpo ceramico Super Vetrified della Churchill è uno dei più forti al mondo e ci dà un prodotto la cui resa dura nel tempo. Un’ampia collezione: dal classico al contemporaneo. La Collezione Super Vetrified di Churchill offre soluzioni per chef che devono lavorare velocemente e con grande professionalità.
Le corps du ceramique super vitrifié est un des corps plus compétents dans le monde, qui donne la présentation dure. Churchill Super vitrifié est une gamme étendue du style classic et contemporain aussi. Les cuisiners qui travaillent dans l’environment très animé peuvent trouver les solutions parfaites dans la gamme de Churchill Super vitrifié.
Stonecast is an exciting collection of hand finished ceramics from Churchill, designed in different styles to suit all manner of hospitality environments.Available in a variety of versatile designs, from the iconic original Stonecast range to innovative new designs such as semi-matte Stonecast Raw and minimal Stonecast Accents, while rustic Stonecast Melamine complements the ceramics collection, enhancing food displays. The nature of the ceramic manufacturing process means that every piece of Stonecast will be slightly different, adding to the overall charm of the product.
Stonecast es una emocionante colección de cerámicas acabadas a mano de Churchill, diseñadas en diferentes estilos para adaptarse a todo tipo de entornos de hostelería. Disponible en una variedad de diseños versátiles, desde la icónica gama original de Stonecast hasta nuevos diseños innovadores como Stonecast Raw con un esmalte semimate y el diseño minimalista de Stonecast Accents, mientras que la melamina rústica de Stonecast complementa la colección de cerámica, mejorando las presentaciones de alimentos. La naturaleza del proceso de fabricación de la cerámica significa que cada pieza de Stonecast es ligeramente diferente, lo que aumenta el encanto general del producto.
Stonecast ist eine aufregende Kollektion, handgefertigter Keramik von Churchill, die in verschiedenen Stilen entworfen wurde, um in alle Richtungen der Gastronomie zu bedienen. Erhältlich in einer Vielzahl vielseitiger Designs, von der Kultserie Original Stonecast, bis hin zu innovativen neuen Designs wie dem halbmatten Stonecast Raw und dem minimalistischen Stonecast Accents, während das rustikale Stonecast Melamin die Porzellankollektion ergänzt und die Speisenpräsentation aufwertet. Die Natur des keramischen Herstellungsprozesses bedeutet, dass sich jedes Stück Stonecast ein wenig voneinander unterscheidet, was den Charme und den Spirit der ganzen Kollektion ausmacht.








Stonecast è un'entusiasmante collezione di ceramiche di Churchill rifinite a mano, progettate in diversi stili per adattarsi a tutti i tipi di ambienti dell'ospitalità. Disponibile in una varietà di decori versatili, dall'iconica gamma Stonecast originale a nuovi decori innovativi come Stonecast Raw semi-opaco ed il minimal Stonecast Accents, mentre la rustica Stonecast Melamine completa la collezione di ceramiche, migliorando l'esposizione delle pietanze. Il tipo di processo di produzione della ceramica fa sì che ogni pezzo di Stonecast sarà leggermente differente, aumentando il fascino generale del prodotto.

Stonecast est une gamme riche et surprenante de porcelaine décorée à la main. Les styles sont nombreux pour s’adapter à tous les univers et aux thématiques de la restauration contemporaine. De l'emblématique gamme originale Stonecast aux nouveaux designs innovants tels que le semi-mat Stonecast Raw, le minimal Stonecast Accents ou encore la mélamine Barley White, toutes les déclinaisons de Stonecast mettent en valeur le dressage et les présentations des chefs. Tous les décors de la gamme Stonecast sont appliqués à la main, ainsi chaque pièce est unique et légèrement différente, ce qui ajoute au charme général du produit.


Stonecast is a rustic tableware collection in colours inspired by the changing seasons and fresh ingredients, the design is hand decorated, making each piece unique.










































































COUPE PLATE
SNMSEV121 32.4cm 12¾" CTN QTY 6 €27.29

SNMSEV111 28.8cm 11¼" CTN QTY 12 €20.38
COUPE PLATE
SNMSEV101 26cm 10¼"
CTN QTY 12 €15.70
SNMSEVP81 21.7cm 82 3"
CTN QTY 12 €11.84
SNMSEVP61 16.5cm 6½"
CTN QTY 12 €9.04
LARGE
COUPE BOWL
SNMSEVB91 24.8cm 9¾" 113.6cl 40oz
CTN QTY 12 €20.38
ORGANIC ROUND PLATE
SNMSOG111 28.6cm 11¼" CTN QTY 12 €28.63
SNMSOG101 26.4cm 10⅜" CTN QTY 12 €20.97
ORGANIC ROUND PLATE


















SNMSOG8 1 21cm 8¼" CTN QTY 12 €14.87 SNMSOG7 1 18.6cm 7¼" CTN QTY 12 €12.89
ORGANIC ROUND BOWL
SNMSOGB11 25.3cm 9⅞" 110cl 38oz CTN QTY 12 €23.93 OVAL





















ORGANIC ROUND BOWL
SDESOGB11 25.3cm 9⅞" 110cl 38oz
CTN QTY 12 €23.93
WIDE RIM BOWL
SDESVWBL1 28cm 11" 46.8cl 16.5oz
CTN QTY 12 €24.27
WIDE RIM BOWL
SDESVWBM1 24cm 9½" 28.4cl 10oz
CTN QTY 12 €20.78
TRIANGLE PLATE
SDESTR121 31.1cm 12¼"
CTN QTY 6 €30.57
SDESTR101 26.5cm 10½"
CTN QTY 12 €22.43
TRIANGLE PLATE
SDESTR9 1 22.9cm 9"
CTN QTY 12 €15.89
SDESTR7 1 19.2cm 7¾"
CTN QTY 12 €13.77
TRIANGLE BOWL
SDESTRB91 23.5cm 9¼" 60cl 21oz
CTN QTY 12 €24.34
TRIANGLE BOWL
SDESTRB71 18.5cm 7¼" 37cl 13oz
CTN QTY 12 €20.19
SDESTRB61 15.3cm 6 26cl 9oz
CTN QTY 12 €17.92
CHEFS' TRIANGLE PLATE
SDESTC351 35.5 x 18.8cm 13¾" x 7⅜"
CTN QTY 6 €36.87
CHEFS' TRIANGLE PLATE
SDESTC301 30.4 x 20.5cm 12 x 8
CTN QTY 6 €31.74
CHEFS' TRIANGLE PLATE
SDESTC261 26.5 x 20.5cm 10⅜" x 8"
CTN QTY 12 €26.78
OBLONG PLATE
SDESOP141 34.5 x 18.5cm 13½" x 7¼"
CTN QTY 6 €44.47 SDESOP111 29.5 x 14cm 11¾ x 5½"



CTN QTY 12 €30.01
DEEP SQUARE PLATE
SDESDS101 26.8cm 10½"
CTN QTY 6 €41.34
OVAL PLATE











SDESOP7 1 19.2 x 16cm 7¾" x 6¼
CTN QTY 12 €14.48
NOODLE BOWL
SDESNDBL1 107.5cl 37.8oz H: 7cm Dia: 18.3cm CTN QTY 6 €18.28
SOUP BOWL
SDESRBL61 47cl 16oz H: 6.3cm Dia: 13.2cm CTN QTY 12 €12.43
SUGAR BOWL
SDESSSGR1 22.7cl 8oz H: 6.2cm Dia: 9.8cm CTN QTY 12 €7.54
ZEST BOWL
SDESZE121 34cl 12oz H: 6.5cm Dia: 12.1cm
CTN QTY 12 €11.84
CAPPUCCINO CUP
SDESCB441 50cl 17.5oz H: 7cm Dia: 11.5cm
CTN QTY 6 €14.87
CAPPUCCINO CUP
SDESCB401 46cl 16oz H: 7cm Dia: 11cm
CTN QTY 6 €10.70
CAPPUCCINO CUP
SDESCB281 34cl 12oz H: 6.5cm Dia: 11cm
CTN QTY 12 €8.97
CAPPUCCINO CUP

SDESCB201 22.7cl 8oz H: 5.5cm Dia: 9.5cm
CTN QTY 12 €7.32
SAUCER
SDESCSS 1 15.6cm 6¼ CTN QTY 12 €6.48
(Fits SDESCB441, SDESCB401, SDESCB281 & SDESCB201)
SDESCEB91 10cl 3.5oz H: 5.5cm Dia: 6.5cm
CTN QTY 12 €5.50
SAUCER

SDESESS 1 11.8cm 4½ CTN QTY 12 €6.33 (Fits SDESCEB91)
MUG
SDESVM121 34cl 12oz
H: 11cm Dia: 8cm
CTN QTY 12 €11.73
BEVERAGE POT

SDESSB151 42.6cl 15oz H: 10.5cm
CTN QTY 4 €32.59
REPLACEMENT LID SDESRL151

CTN QTY 6 €10.85
SDESSJ4 1 11.4cl 4oz H: 7cm CTN QTY 4 €14.48
RIPPLE CHIP MUG
SDESRPCM1 28cl 10oz H: 9.5cm 3⅞" Dia: 8.3cm 3¼"
CTN QTY 12 €10.30
RIPPLE DIP POT
SDESRPD21 5.7cl 2oz H: 5cm 2" Dia: 5.9cm 2
CTN QTY 12 €7.95
SAUCE DISH
SDESSD3 1 9cl 3oz H: 4cm Dia: 8cm CTN QTY 12 €7.76
SALT
SDESSSA 1 7cm 2½
CTN QTY 12 €13.43 PEPPER
SDESSPE 1 7cm 2½" CTN QTY 12 €13.43
BUD VASE
SDESSBV 1 12.5cm 5" CTN QTY 6 €17.13
COUPE PLATE
SWHSEV121 32.4cm 12¾"
CTN QTY 6 €27.29
COUPE PLATE
SWHSEV111 28.8cm 11¼"
CTN QTY 12 €20.38
SWHSEV101 26cm 10¼"
CTN QTY 12 €15.70
COUPE PLATE
SWHSEVP81 21.7cm 8
CTN QTY 12 €11.84
SWHSEVP61 16.5cm 6½"
CTN QTY 12 €9.04
LARGE COUPE BOWL
SWHSPLC21 31cm 12" 240cl 84.5oz
CTN QTY 6 €27.10
COUPE BOWL
SWHSEVB91 24.8cm 9¾ 113.6cl 40oz
CTN QTY 12 €20.38
SWHSEVB71 18.2cm 7¼” 42.6cl 15oz
CTN QTY 12 €13.23
DEEP COUPE PLATE
SWHSPD271 28.1cm 11"
H: 3.7cm
CTN QTY 12 €22.90
DEEP COUPE PLATE
SWHSPD251 25.5cm 10" H: 3.5cm
CTN QTY 12 €20.45
SWHSPD221 22.5cm 8⅞" H: 2.7cm
CTN QTY 12 €16.83
CHEFS’ WALLED PLATE

SWHSWP281 27.5cm 10¾" H: 2cm
CTN QTY 6 €35.70
ORGANIC ROUND PLATE
SWHSOG111 28.6cm 11¼"
CTN QTY 12 €28.63
SWHSOG101 26.4cm 10⅜"
CTN QTY 12 €20.97
ORGANIC ROUND PLATE


















SWHSOG8 1 21cm 8¼"

Price shown is price per piece
SWHSTR9 1 22.9cm 9
CTN QTY 12 €15.89
SWHSTR7 1 19.2cm 7¾
CTN QTY 12 €13.77
TRIANGLE BOWL
SWHSTRB91 23.5cm 9¼ 60cl 21oz
CTN QTY 12 €24.34
TRIANGLE BOWL
SWHSTRB71 18.5cm 7¼" 37cl 13oz
CTN QTY 12 €20.19
SWHSTRB61 15.3cm 6” 26cl 9oz
CTN QTY 12 €17.92
TRIANGLE SHALLOW BOWL
SWHSTB271 27.2 x 26.7cm 10¾" x 10½" 78cl 27oz
CTN QTY 12 €26.88
SWHSTB231 21 x 21cm 8¼” x 8¼” 41cl 14oz
CTN QTY 12 €20.67
CHEFS’ TRIANGLE
WALLED PLATE
SWHSWT271 26cm 10¼" H: 2cm
CTN QTY 6 €30.56
CHEFS’ TRIANGLE WALLED PLATE SWHSWT211 20cm 7⅞" H: 2cm
CTN QTY 6 €24.20
CHEFS' TRIANGLE PLATE
SWHSTC351 35.5 x 18.8cm 13¾ x 7⅜
CTN QTY 6 €36.87
CHEFS' TRIANGLE PLATE
SWHSTC261 26.5 x 20.5cm 10⅜" x 8"
CTN QTY 12 €26.78
CHEFS' GEO PLATE
SWHSGE351 35 x 18.5cm 13¾" x 7¼"
CTN QTY 6 €40.68
CHEFS' GEO PLATE
SWHSGE301 30 x 15.5cm 11¾" x 6⅛"
CTN QTY 12 €27.15
CHEFS' OBLONG PLATE No. 4
SWHSXO141 35.5 x 18.9cm 13⅞" x 7⅜"
CTN QTY 6 €44.47
CHEFS' OBLONG PLATE No. 3 SWHSXO111 29.8 x 15.3cm 11¾" x 6" CTN QTY 12 €30.01






CHEFS' OBLONG PLATE No. 2 SWHSXO101 26.9 x 12.7cm 10½" x 5" CTN QTY 12 €28.59
CHEFS' TRIANGLE PLATE
SWHSTC301 30.4 x 20.5cm 12 x 8
CTN QTY 6 €31.74
CHEFS' OBLONG PLATE No. 8
SWHSOBL41 30 x 19.9cm 12" x 7 "
CTN QTY 6 €40.79
CHEFS' OBLONG PLATE No.7
SWHSOBL31 26.1 x 20.2cm 10¼" x 8"
CTN QTY 12 €37.05
CHEFS' OBLONG PLATE No.6
SWHSOBL21 23.7 x 15.7cm 9 " x 6⅛"
CTN QTY 12 €29.16
CHEFS' OBLONG PLATE No.5
SWHSOBL11 15.4 x 12.6cm 6" x 5"
CTN QTY 12 €14.27
OBLONG PLATE
SWHSOP141 34.5 x 18.5cm 13½" x 7¼"
CTN QTY 6 €44.47
OBLONG PLATE
SWHSOP111 29.5 x 14cm 11¾" x 5½" CTN QTY 12 €30.01
CHEFS' OBLONG PLATE No. 1 SWHSXO7 1 20 x 12.1cm 7 " x 4¾" CTN QTY 12 €17.55








CHEFS' OBLONG PLATTER No. 9 SWHSXP141 34.4 x 23.4cm 13½" x 9¼" CTN QTY 6 €50.94
















ROUND DISH
SWHSID7 1 18.5 x 16.8cm 7⅛ x 6⅝ 35.8cl 12.6oz
CTN QTY 12 €18.52
ROUND DISH
SWHSID6 1 16 x 14.5cm 6¼"x 5¾ 24.7cl 8.7oz
CTN QTY 12 €14.93
SWHSPDLH1 28.4cm 11⅛"
CTN QTY 6 €21.97
DEEP SKILLET PAN
SWHSPN2 1 24.5cm 9⅝" 57cl 20oz
CTN QTY 6 €28.33
SMALL SKILLET PAN
SWHSPN1 1 23cm 9" 37cl 13oz
CTN QTY 6 €22.64
LIDDED STEW POT
SWHSLSPT1 14cm 5½" 43cl 15oz
CTN QTY 6 €28.33
REPLACEMENT LID SWHSLD1 1 CTN QTY 6 €11.32

DEEP SQUARE PLATE
SWHSDS101 26.8cm 10½
CTN QTY 6 €41.34
OVAL COUPE PLATE
SWHSOP7 1 19.2 x 16cm 7¾" x 6¼
CTN QTY 12 €14.48
Covered by Churchill 5 Year Edge
INTERMEDIATE OVAL
EARED DISH
SWHSIOEN1 23.2 x 12.5cm 9⅛" x 5" 38cl 13.4oz
CTN QTY 6 €24.81
SMALL OVAL EARED DISH
SWHSSOEN1 20.5 x 11.3cm 8⅛" x 4⅜" 25.5cl 9oz
CTN QTY 6 €18.86
LARGE ROUND EARED DISH


SWHSLREN1 17.5 x 21.5cm 7" x 8½" 59cl 20.8oz
CTN QTY 6 €27.68
SMALL ROUND EARED DISH


SWHSSREN1 15 x 18cm 5⅞" x 7⅛" 30cl 10.6oz
CTN QTY 6 €18.86
SWHSLASN1 16 x 12 x 5cm 6⅜" x 4¾" x 2" 60cl 21.1oz
CTN QTY 12 €18.09
RAMEKIN

SWHSLRKN1 9cm 3½" 19.5cl 6.9oz
CTN QTY 24 €5.98 SWHSSRKN1 7cm 2¾" 9cl 3.2oz
CTN QTY 24 €5.24
SWHSNDBL1 107.5cl 37.8oz H: 8cm Dia: 18.3cm
CTN QTY 6 €18.28
SOUP BOWL
SWHSRBL61 47cl 16oz H: 6.3cm Dia: 13.2cm CTN QTY 12 €12.43
SUGAR BOWL
SWHSSSGR1 22.7cl 8oz H: 6.2cm Dia: 9.8cm CTN QTY 12 €7.54
ZEST BOWL
SWHSZE121 34cl 12oz H: 6.5cm Dia: 12.1cm
CTN QTY 12 €11.84
STACKING BOWL
SWHSVB141 36cl 12.6oz H: 5.5cm Dia: 11.5cm
CTN QTY 6 €10.30
STACKING CUP
SWHSVSC81 22cl 8oz H: 7cm Dia: 8.5cm
CTN QTY 12 €7.04
SAUCER
SWHSVSM 1 15cm 5⅞" CTN QTY 12 €6.35 (Fits SWHSVSC81 )
CAPPUCCINO CUP
SWHSCB441 50cl 17.5oz H: 7cm Dia: 11.5cm
CTN QTY 6 €14.87 SWHSCB401 46cl 16oz H: 7cm Dia: 11.5cm
CTN QTY 6 €10.70
CAPPUCCINO CUP
SWHSCB281 34cl 12oz H: 6.5cm Dia: 11cm CTN QTY 12 €8.97 SWHSCB111 28cl 10oz H: 6cm Dia: 11cm CTN QTY 12 €8.22
CAPPUCCINO CUP
SWHSCB201 22.7cl 8oz H: 5.5cm Dia: 9.5cm CTN QTY 12 €7.32 SWHSCB061 17cl 6oz H: 5.5cm Dia: 9cm CTN QTY 12 €6.81
SWHSCSS 1 15.6cm 6¼" CTN QTY 12 €6.48 (Fits SWHSCB441, SWHSCB401, SWHSCB281, SWHSCB111, SWHSCB201 & SWHSCB061)
ESPRESSO CUP
SWHSCEB91 10cl 3.5oz H: 5.5cm Dia: 6.5cm CTN QTY 12 €5.50
SAUCER
SWHSESS 1 11.8cm 4½"
CTN QTY 12 €6.33 (Fits SWHSCEB91)
MUG
SWHSVM121 34cl 12oz H: 11cm Dia: 8cm
CTN QTY 12 €11.73
SWHSSB301 85.2cl 30oz H: 15cm
CTN QTY 4 €42.30
REPLACEMENT LID SWHSRL301


CTN QTY 6 €10.85
BEVERAGE POT



SWHSSB151 42.6cl 15oz H: 10.5cm
CTN QTY 4 €32.59
REPLACEMENT LID SWHSRL151
CTN QTY 6 €10.85
JUG
SWHSSJ4 1 11.4cl 4oz H: 7cm CTN QTY 4 €14.48
SWHSSJ2 1 5.6cl 2oz H: 5cm
CTN QTY 12 €8.74
RIPPLE CHIP MUG
SWHSRPCM1 28cl 10oz H: 9.5cm Dia: 8.3cm
CTN QTY 12 €10.30
SWHSRPD21 5.7cl 2oz H: 5cm Dia: 5.9cm
CTN QTY 12 €7.95
SAUCE DISH
SWHSSD3 1 9cl 3oz H: 4cm Dia: 8cm
CTN QTY 12 €7.76
SWHSBS141 13cm 5¼" 40cl 14oz H: 6.5cm
CTN QTY 12 €11.58
SWHSBSB91 13cm 5¼" 26cl 9oz H: 4.5cm
CTN QTY 12 €9.96
SWHSBSB61 11.6cm 4 ” 20cl 7oz H: 4cm
CTN QTY 12 €8.80
SWHSBSCM1 10cm 3 " 29cl 11oz H: 8cm
CTN QTY 12 €9.84
SWHSBSDB1 10.2cm 4" 24cl 8.4oz H: 6cm
CTN QTY 12 €8.39
SWHSBSD41 8.5cm 3 11cl 4oz H: 5cm
CTN QTY 12 €7.89 SWHSBSD21 7cm 2 ” 6cl 2oz H: 4cm
CTN QTY 12 €6.31
SALT
SWHSSSA 1 7cm 2½"
CTN QTY 12 €13.44
PEPPER
SWHSSPE 1 7cm 2½"
CTN QTY 12 €13.44
BUD VASE
SWHSSBV 1 12.5cm 5"
CTN QTY 6 €17.13



















































NOODLE BOWL
SPGSNDBL1 107.5cl 37.8oz H: 8cm Dia: 18.3cm CTN QTY 6 €18.28
SOUP BOWL
SPGSRBL61 47cl 16oz H: 6.3cm Dia: 13.2cm CTN QTY 12 €12.43
SUGAR BOWL
SPGSSSGR1 22.7cl 8oz H: 6.2cm Dia: 9.8cm CTN QTY 12 €7.54
ZEST BOWL
SPGSZE121 34cl 12oz H: 6.5cm Dia: 12.1cm CTN QTY 12 €11.84
STACKING BOWL
SPGSVB141 36cl 12.6oz H: 5.5cm Dia: 11.5cm CTN QTY 6 €10.30
STACKING CUP
SPGSVSC81 22cl 8oz H: 7cm Dia: 8.5cm CTN QTY 12 €7.04
SAUCER
SPGSVSM 1 15cm 5⅞" CTN QTY 12 €6.35 (Fits SPGSVSC81)
CAPPUCCINO CUP
SPGSCB281 34cl 12oz H: 6.5cm Dia: 11cm CTN QTY 12 €8.97
CAPPUCCINO CUP
SPGSCB111 28cl 10oz H: 6cm Dia: 11cm CTN QTY 12 €8.22
CAPPUCCINO CUP
SPGSCB201 22.7cl 8oz H: 5.5cm Dia: 9.5cm CTN QTY 12 €7.32
CAPPUCCINO CUP
SPGSCB061 17cl 6oz H: 5.5cm Dia: 9cm CTN QTY 12 €6.81
SAUCER
SPGSCSS 1 15.6cm 6¼ CTN QTY 12 €6.48 (Fits, SPGSCB281, SPGSCB111, SPGSCB201 & SPGSCB061)
ESPRESSO CUP
SPGSCEB91 10cl 3.5oz H: 5.5cm Dia: 6.5cm CTN QTY 12 €5.50
SAUCER SPGSESS 1 11.8cm 4½" CTN QTY 12 €6.33 (Fits SPGSCEB91)





MUG SPGSVM121 34cl 12oz H: 11cm Dia: 8cm CTN QTY 12 €11.73

BEVERAGE POT


SPGSSB301 85.2cl 30oz H: 15cm CTN QTY 4 €42.30 REPLACEMENT LID SPGSRL301 CTN QTY 6 €10.85
RIPPLE CHIP MUG
SPGSRPCM1 28cl 10oz H: 9.5cm Dia: 8.3cm CTN QTY 12 €10.30
RIPPLE DIP POT
SPGSRPD21 5.7cl 2oz H: 5cm Dia:
SAUCE DISH
SPGSSD3 1 9cl 3oz H: 4cm Dia: 8cm CTN QTY 12 €7.76
Covered by Churchill 5 Year Edge Chip Warranty
STONECAST • CHURCHILL SUPER VITRIFIED
















TRIANGLE PLATE
SCFSTR7 1 19.2cm 7¾"
CTN QTY 12 €13.77
TRIANGLE BOWL SCFSTRB91 23.5cm 9¼" 60cl 21oz
CTN QTY 12 €24.34
TRIANGLE BOWL
SCFSTRB71 18.5cm 7¼" 37cl 13oz CTN QTY 12 €20.19
TRIANGLE BOWL
SCFSTRB61 15.3cm 6" 26cl 9oz CTN QTY 12 €17.92
OBLONG PLATE
SCFSOP141 34.5 x 18.5cm 13½" x 7¼" CTN QTY 6 €44.47

OBLONG PLATE
SCFSOP111 29.5 x 14cm 11¾" x 5½" CTN QTY 12 €30.01

DEEP SQUARE PLATE
SCFSDS101 26.8cm 10½" CTN QTY 6 €41.34

OVAL COUPE PLATE
SCFSOP7 1 19.2 x 16cm 7¾" x 6¼"
CTN QTY 12 €14.48
SUGAR BOWL
SCFSSSGR1 22.7cl 8oz H: 6.2cm Dia: 9.8cm CTN QTY 12 €7.54
ZEST BOWL SCFSZE121 34cl 12oz H: 6.5cm Dia: 12.1cm CTN QTY 12 €11.84



CAPPUCCINO CUP SCFSCB281 34cl 12oz H: 6.5cm Dia: 11cm CTN QTY 12 €8.97

CAPPUCCINO CUP
SCFSCB201 22.7cl 8oz H: 5.5cm Dia: 9.5cm CTN QTY 12 €7.32
SAUCER
SCFSCSS 1 15.6cm 6¼" CTN QTY 12 €6.48 (Fits SCFSCB281 & SCFSCB201)
SCFSCEB91 10cl 3.5oz H: 5.5cm Dia: 6.5cm CTN QTY 12 €5.50
SAUCER


SCFSESS 1 11.8cm 4½" CTN QTY 12 €6.33 (Fits SCFSCEB91)


MUG
SCFSVM121 34cl 12oz H: 11cm Dia: 8cm CTN QTY 12 €11.73
BEVERAGE POT
SCFSSB151 42.6cl 15oz H: 10.5cm
CTN QTY 4 €32.59
REPLACEMENT LID
SCFSRL151
CTN QTY 6 €10.85
JUG SCFSSJ4 1 11.4cl 4oz H: 7cm CTN QTY 4 €14.48

SAUCE DISH
SCFSSD3 1 9cl 3oz H: 4cm Dia: 8cm CTN QTY 12 €7.76
















OBLONG
OBLONG

NOODLE BOWL
CAPPUCCINO CUP
SSOSCB281 34cl 12oz H: 6.5cm Dia: 11cm CTN QTY 12 €8.97






SAUCER

SAUCER



SAUCE









































Hints is designed for those who want the rustic Stonecast look but with just a hint of colour, hand decorated with a fine speckled and stippled edge band.
COUPE PLATE
SHBIEV121 32.4cm 12¾"
CTN QTY 6 €27.29
COUPE PLATE
SHBIEV111 28.8cm 11¼"
CTN QTY 12 €20.38
SHBIEV101 26cm 10¼"
CTN QTY 12 €15.70
COUPE PLATE
SHBIEVP81 21.7cm 8
CTN QTY 12 €11.84
COUPE PLATE
SHBIEVP61 16.5cm 6½"
CTN QTY 12 €9.04
COUPE BOWL
SHBIEVB91 24.8cm 9¾" 113.6cl 40oz
CTN QTY 12 €20.38
COUPE BOWL
SHBIEVB71 18.2cm 7¼" 42.6cl 15oz
CTN QTY 12 €13.23
TRIANGLE PLATE
SHBITR121 31.1cm 12¼"
CTN QTY 6 €30.57
TRIANGLE PLATE
SHBITR101 26.5cm 10½"
CTN QTY 12 €22.43
TRIANGLE PLATE
SHBITR9 1 22.9cm 9"
CTN QTY 12 €15.89
TRIANGLE BOWL
SHBITRB91 23.5cm 9¼" 60cl 21oz CTN QTY 12 €24.34
TRIANGLE BOWL
SHBITRB61 15.3cm 6" 26cl 9oz
CTN QTY 12 €17.92
CHEFS' OBLONG PLATTER No.9


SHBIXP141 34.4 x 23.4cm 13½" x 9¼"
CTN QTY 6 €50.94
CHEFS' OBLONG PLATE No.4
SHBIXO141 35.5 x 18.9cm 13⅞" x 7⅜"
CTN QTY 6 €44.47
CHEFS' OBLONG PLATE No.3
SHBIXO111 29.8 x 15.3cm 11¾" x 6"
CTN QTY 12 €30.01
OVAL PLATE
SHBID12 1 30.5cm 12" CTN QTY 12 €29.46






OVAL PLATE











SHBID10 1 25.4cm 10"
CTN QTY 12 €24.51
Add a touch of rusticity to food displays with buffetware decorated with the fine speckle and stippled edge band of Stonecast Hints.




LARGE COUPE BOWL
SHBIAC141 38.5 x 8.8cm 15¼" x 3½" 500cl 175oz
CTN QTY 4 €98.20
SQUARE BUFFET TRAY
SHBIAST 1 30.3 x 30.3cm 11⅞ x 11⅞"
CTN QTY 4 €74.92
RECTANGULAR BUFFET TRAY
SHBIART 1 30 x 14.5cm 11¾" x 5¾" CTN QTY 6 €33.43
SQUARE DISH
SHBISBD 1 25 x 25 x 6.2cm 10 x 10 x 2½" 2ltr 70.4oz
CTN QTY 6 €47.12
SMALL DISH
SHBIRCD 1 18 x 19.4 x 11.5cm 7" x 6½" x 4½" 2ltr 70.4oz
CTN QTY 4 €55.68
2/4 FLAT TRAY
SHBISLBD1 53 x 15 x 2.5cm 21" x 6" x 1" 1.4ltr 50oz
CTN QTY 4 €92.82
RECTANGULAR DISH
SHBIXLBD1 53 x 32.5 x 6.2cm 21 x 13 x 2½ 6ltr 211.8oz
CTN QTY 2 €157.05
SHBILBD 1 53 x 16 x 6.2cm 21" x 6½ x 2½" 3ltr 105.6oz




CTN QTY 2 €108.52
RECTANGULAR DISH
SHBIRLBD1 38 x 25 x 6.2cm 15” x 10” x 2½” 3.5ltr 123.2oz
CTN QTY 4 €78.54
LARGE COUPE BOWL
SHWHAC141 38.5 x 8.8cm 15¼ x 3½ 500cl 175oz
CTN QTY 4 €98.20
SQUARE BUFFET TRAY

SHWHAST 1 30.3 x 30.3cm 11⅞" x 11⅞" CTN QTY 4 €74.92
RECTANGULAR BUFFET TRAY
SHWHART 1 30 x 14.5cm 11¾" x 5¾" CTN QTY 6 €33.43
SQUARE DISH
SHWHSBD 1 25 x 25 x 6.2cm 10" x 10" x 2½" 2ltr 70.4oz

CTN QTY 6 €47.12
SMALL DISH
SHWHRCD 1 18 x 19.4 x 11.5cm 7" x 6½" x 4½" 2ltr 70.4oz
CTN QTY 4 €55.68
2/4 FLAT TRAY
SHWHSLBD1 53 x 15 x 2.5cm 21 x 6" x 1 1.4ltr 50oz CTN QTY 4 €92.82


RECTANGULAR DISH
SHWHXLBD1 53 x 32.5 x 6.2cm 21" x 13" x 2½ 6ltr 211.8oz
CTN QTY 2 €157.05
SHWHLBD 1 53 x 16 x 6.2cm 21" x 6½" x 2½" 3ltr 105.6oz
CTN QTY 2 €108.52
SHWHRLBD1 38 x 25 x 6.2cm 15” x 10” x 2½” 3.5ltr 123.2oz
CTN QTY 4 €78.54
A subtle alternative to all over colour, Stonecast Accents incorporates white space into the iconic spinwash design. Accents brings a contemporary feel to the collection, while maintaining the rustic character of Stonecast.
Subtle Colour Balance
COUPE PLATE ASPPEV111 28.8cm 11¼" CTN QTY 12 €21.40
COUPE PLATE
ASPPEV101 26cm 10¼" CTN QTY 12 €16.49
COUPE PLATE ASPPEVP81 21.7cm 8 " CTN QTY 12 €12.43
COUPE BOWL
ASPPEVB91 24.8cm 9¾" 113.6cl 40oz CTN QTY 12 €21.40
COUPE BOWL
12
CHEFS' OBLONG PLATE No.4 ASPPXO141 35.5 x 18.9cm 13⅞" x 7⅜" CTN QTY 6 €46.69





CHEFS' OBLONG PLATE No.3 ASPPXO111 29.8 x 15.3cm 11¾" x 6" CTN QTY 12 €31.52












































































































The hand decorated Plume design interprets the fluidity of painting mediums. A unique formula creates layers of colour that interact and blend together, forming the characteristic Plume effect.






























Inspired by the fluidity of water, the Stonecast Aqueous design emulates a liquid pooling effect and is hand finished in colours reminiscent of natural bodies of water.














































Stonecast Patina is inspired by the tones and surface texture created naturally over time. The nature of the manufacturing process means that each piece will be slightly different.































































COUPE BOWL
TRIANGLE PLATE












PAATTR121 31.1cm 12¼" CTN QTY 6 €30.57 PAATTR101 26.5cm 10½” CTN QTY 12 €22.43

PAATTR9 1 22.9cm 9” CTN QTY 12 €15.89
PAATTR7 1 19.2cm 7¾” CTN QTY 12 €13.77




















































Studio Prints Collections are a contemporary take on traditional studio pottery, celebrating the creative history of ceramics. Studio Prints are achieved with Churchill’s innovative print process. The print is positioned directly under the glaze, creating a protective layer over the decoration. The ranges provide all of the durability and technical reassurance required for a hospitality environment.
Las colecciones Studio Prints son una versión contemporánea de la cerámica de estudio tradicional, que celebra la historia creativa de la cerámica. Studio Prints se logra con el innovador proceso de impresión de Churchill. La impresión se coloca directamente debajo del esmalte, creando una capa protectora sobre la decoración. Las gamas proporcionan toda la durabilidad y la seguridad técnica necesarias para un entorno hostelero.
Die Studio Prints Kollektionen sind eine zeitgemäße Interpretation der traditionellen Studiotöpferei und zelebrieren die kreative Geschichte der Keramik. Churchill Studio Prints werden mit unserem innovativem Druckverfahren hergestellt. Der Druck wird direkt unter der Glasur positioniert, wodurch eine Schutzschicht über dem Dekor entsteht. Unser gesamtes Sortiment bietet die für die Gastronomie erforderliche Langlebigkeit und technische Sicherheit.

Le collezioni Studio Prints sono una moderna visione del tradizionale laboratorio di vasellame e rappresentano la creativa storia della ceramica. La collezione Studio Prints si ottiene grazie all’innovativo processo di stampa di Churchill. Il motivo stampato è direttamente posizionato sotto lo smalto, creando uno strato protettivo sopra la decorazione. Le gamme di prodotti offrono la durata e la sicurezza tecnica necessarie per una struttura ricettiva.
Les collections Studio Prints sont une version contemporaine de la poterie d'atelier traditionnelle, célébrant l'histoire créative de la céramique. La collection Studio Prints utilise le procédé d’impression Churchill. Le processus consiste à apposer l’impression directement sur l’assiette qui sera recouverte par l’émail, créant une couche protectrice.




The Haze design features a multi tonal pattern inspired by the process of spaying glaze onto ceramics. Haze is decorated underglaze in Churchill's semi matte Vellum finish.

















Kintsugi Accents, a contemporary take on the all over crackled Kintsugi design. Available in Quartz Black, a bold and striking tone perfect for elevating food presentation. Printed underglaze for added durability, each piece of Kintsugi Accents is unique.
COUPE PLATE
KAQBEV111 28.8cm 11¼" CTN QTY 12 €22.61
COUPE PLATE
KAQBEV101 26cm 10¼" CTN QTY 12 €15.98
COUPE PLATE
KAQBEVP81 21.7cm 8 " CTN QTY 12 €13.51
COUPE PLATE
KAQBEVP61
12
COUPE
COUPE
CHEFS' OBLONG PLATE NO.4 KAQBXO141 35.5 x 18.9cm 13⅞ x 7⅜" CTN QTY 6 €44.47











CHEFS' OBLONG PLATE NO.3
KAQBXO111 29.8 x 15.3cm 11¾ x 6" CTN QTY 12 €30.01
- Under glaze print finish meaning long-lasting results.
The Kintsugi design is a modern interpretation of the Japanese art of repairing broken pottery. The intricate crackled design features a subtle, reactive texture that makes each piece unique.

COUPE PLATE
KTAMEV111 28.8cm 11¼" CTN QTY 12 €22.61
COUPE PLATE
KTAMEV101 26cm 10¼" CTN QTY 12 €15.98
COUPE PLATE
KTAMEVP81 21.7cm 8 " CTN QTY 12 €13.51

COUPE BOWL
KTAMEVB91 24.8cm 9¾" 113.6cl 40oz CTN QTY 12 €22.61
COUPE BOWL
KTAMEVB71 18.2cm 7¼" 42.6cl 15oz CTN QTY 12 €13.51
CHEFS WALLED PLATE




KTAMWP261 26cm 10¼" H: 2cm CTN QTY 6 €27.78
CHEFS' WALLED PLATE
KTAMWP211 21cm 8¼" H: 2cm CTN QTY 6 €22.00

TRIANGLE PLATE
KTAMTR101 26.5cm 10½" CTN QTY 12 €24.97

TRIANGLE PLATE
KTAMTR9 1 22.9cm 9" CTN QTY 12 €17.26
TRIANGLE PLATE KTAMTR7 1 19.2cm 7¾" CTN QTY 12 €13.48









TRIANGLE BOWL
KTAMTRB91 23.5cm 9¼" 60cl 21oz CTN QTY 12 €30.55
TRIANGLE BOWL
KTAMTRB71 18.5cm 7¼" 37cl 13oz CTN QTY 12 €21.16
CHEFS'
CHEFS'
- Under glaze print finish meaning long-lasting results.




















TRIANGLE


















Prints Raku is inspired by the traditional glazing process known as Raku firing, which creates unique and expressive results. Manufactured in the UK, Raku is achieved with Churchill's innovative print process.




















CHEFS' TRIANGLE PLATE
RKTBTC361 35.6 x 25cm 14" x 9¾"
CTN QTY 6 €40.73
RKTBTC351 35.5 x 18.8cm 13¾" x 7⅜"
CTN QTY 6 €36.87
CHEFS' TRIANGLE PLATE
RKTBTC301 30.4 x 20.5cm 12" x 8"
CTN QTY 6 €31.74
RKTBTC261 26.5 x 20.5cm 10⅜" x 8"
CTN QTY 12 €26.78
RKTBTC201 20 x 15cm 7⅞" x 5⅞"
CTN QTY 12 €16.90
CHEFS' GEO PLATE
RKTBGE351 35 x 18.5cm 13¾" x 7¼"
CTN QTY 6 €40.68 RKTBGE301 30 x 15.5cm 11¾" x 6⅛" CTN QTY 12 €27.15
CHEFS' OBLONG PLATE No.4
RKTBXO141 35.5 x 18.9cm 13⅞" x 7⅜"
CTN QTY 6 €44.47
CHEFS’ OBLONG PLATE No.3
RKTBXO111 29.8 x 15.3cm 11¾" x 6" CTN QTY 12 €30.01
CHEFS' OBLONG PLATE No.2
RKTBXO101 26.9 x 12.7cm 10½" x 5" CTN QTY 12 €28.59
CHEFS' OBLONG PLATE No.1
RKTBXO7 1 20 x 12.1cm 74/5 x 4¾" CTN QTY 12 €17.55







CHEFS' OBLONG PLATTER No.9
RKTBXP141 34.4 x 23.4cm 13½" x 9¼"
CTN QTY 6 €50.94
CHEFS' OBLONG PLATE No.8
RKTBOBL41 30 x 19.9cm 12" x 7 "
CTN QTY 6 €40.79
CHEFS' OBLONG PLATE No.7
RKTBOBL31 26.1 x 20.2cm 10¼" x 8"
CTN QTY 12 €37.05
CHEFS' OBLONG PLATE No.6
RKTBOBL21 23.7 x 15.7cm 9 " x 6⅛"
CTN QTY 12 €29.16
CHEFS' OBLONG PLATE No.5
RKTBOBL11 15.4 x 12.6cm 6" x 5" CTN QTY 12 €14.27
SQUARE PLATE
RKTBSP111 25.2cm 10" CTN QTY 12 €23.81

RKTBSP9 1 21.5cm 8½" CTN QTY 12 €17.02
RKTBOP121 31.7 x 25.5cm 12½" x 10" CTN QTY 12 €31.63 RKTBOP581 27 x 22.9cm 10⅝" x 9" CTN QTY 12 €29.26
CHEFS' OVAL PLATE









RKTBOV351 34.7 x 17.3cm 13⅝" x 6¾" CTN QTY 6 €36.87 RKTBOV301 29.9 x 15cm 11¾" x 5⅞"
CTN QTY 12 €24.28
RECTANGULAR TILE
RKTBRST 1 37.6 x 14cm 14¾" x 5½'' CTN QTY 4 €42.03 (Fits Wooden Boards ZCAWWBDD1, ZCAWWGDD1, ZCAWLWSB1)
ROUND DISH
RKTBID7 1 18.5 x 16.8cm 7⅛" x 6⅝" 35.8cl 12.6oz
CTN QTY 12 €18.52
RKTBID6 1 16 x 14.5cm 6¼" x 5¾" 24.7cl 8.7oz
CTN QTY 12 €14.93
CAPPUCCINO CUP
RKTBCB281 34cl 12oz H: 6.5cm Dia: 11cm CTN QTY 12 €11.30 RKTBCB201 22.7cl 8oz H: 5.5cm Dia: 9.5cm CTN QTY 12 €9.32

ESPRESSO CUP

SAUCER

TRIANGLE SHALLOW BOWL





















CHEFS’














COUPE PLATE
RKAGEV111 28.8cm 11¼" CTN QTY 12 €22.61

COUPE PLATE
RKAGEVP81 21.7cm 8 " CTN QTY 12 €13.51

COUPE BOWL
RKAGEVB71 18.2cm 7¼" 42.6cl 15oz CTN QTY 12 €13.51
DEEP COUPE PLATE
RKAGPD271 28.1cm 11" H: 3.7cm CTN QTY 12 €27.07
DEEP COUPE PLATE
RKAGPD251 25.5cm 10" H: 3.5cm
CTN QTY 12 €22.72
CHEFS' OBLONG PLATE No.4


RKAGXO141 35.5 x 18.9cm 13⅞" x 7 CTN QTY 6 €44.47
CHEFS' OBLONG PLATE No.3
RKAGXO111 29.8 x 15.3cm 11¾" x 6
OVAL PLATE


RKAGOP121 31.7 x 25.5cm 12½" x 10" CTN QTY 12 €31.63













- Under glaze print finish meaning long-lasting results.




































Raku Duo, a design that brings a new dimension to the collection with striking two colour compositions. The complementary colour combinations create a premium frame for elevated food presentation.
























Studio Prints Stone is inspired by the traditional process of hand carving ceramics from natural stone. Emulating tones and textures of nature, Stone is achieved with Churchill's innovative print process and each piece is unique.




COUPE PLATE
COUPE PLATE
COUPE PLATE STAMEVP81 21.7cm 8 " CTN QTY 12 €13.51

COUPE PLATE
COUPE BOWL STAMEVB91 24.8cm 9 " 113.6cl 40oz CTN QTY 12 €22.61
COUPE BOWL STAMEVB71 18.2cm 7¼" 42.6cl 15oz CTN QTY 12 €13.51
CHEFS' OBLONG PLATE No.4 STAMXO141 35.5 x 18.9cm 13⅞" x 7⅜" CTN QTY 6 €44.47

CHEFS' OBLONG PLATE No.3 STAMXO111 29.8 x 15.3cm 11¾" x 6" CTN QTY 12 €30.01










COUPE PLATE
STGPEV111 28.8cm 11¼"
CTN QTY 12 €22.61
COUPE PLATE
STGPEV101 26cm 10¼" CTN QTY 12 €15.98
COUPE PLATE
STGPEVP81 21.7cm 8 " CTN QTY 12 €13.51
COUPE PLATE
STGPEVP61 16.5cm 6½" CTN QTY 12 €8.87
COUPE BOWL STGPEVB91 24.8cm 9 " 113.6cl 40oz
CTN QTY 12 €22.61
COUPE BOWL STGPEVB71 18.2cm 7¼" 42.6cl 15oz CTN QTY 12 €13.51
CHEFS' OBLONG PLATE No.4 STGPXO141 35.5 x 18.9cm 13⅞" x 7⅜" CTN QTY 6 €44.47


CHEFS' OBLONG PLATE No.3 STGPXO111 29.8 x 15.3cm 11¾" x 6" CTN QTY 12 €30.01









- Under glaze print finish meaning long-lasting results.


























































Studio Prints Mineral is inspired by the mottled surface texture created by traditional artisan glazes. Achieved with Churchill’s innovative print process, every piece is unique.
ORGANIC ROUND PLATE
ORGANIC ROUND PLATE
ORGANIC ROUND PLATE MNBLOG8 1 21cm 8¼" CTN QTY 12 €19.02







ORGANIC ROUND PLATE



ORGANIC ROUND BOWL
ORGANIC ROUND PLATE MNGROG111 28.6cm 11¼" CTN QTY 12 €37.92



ORGANIC ROUND PLATE MNGROG101 26.4cm 10 " CTN QTY 12 €27.66
ORGANIC ROUND PLATE MNGROG8 1 21cm 8¼" CTN QTY 12 €19.02

ORGANIC ROUND PLATE MNGROG7 1 18.6cm 7¼” CTN QTY 12 €14.66
ORGANIC ROUND BOWL




























Homespun is a contemporary take on studio ceramics, featuring a concentric pattern that emulates hand thrown pottery. Printed underglaze with a hand applied edge band, each piece of Homespun unique.













COUPE PLATE
SPSGEV111 28.8cm 11¼"
CTN QTY 12 €22.61
SPSGEV101 26cm 10¼"
CTN QTY 12 €15.98
COUPE PLATE
SPSGEVP81 21.7cm 8 "
CTN QTY 12 €13.51
SPSGEVP61 16.5cm 6½"
CTN QTY 12 €8.87
COUPE BOWL
SPSGEVB91 24.8cm 9¾" 113.6cl 40oz
CTN QTY 12 €22.61
SPSGEVB71 18.2cm 7¼" 42.6cl 15oz
CTN QTY 12 €13.51
WIDE RIM BOWL
SPSGVWBL1 28cm 11" 46.8cl 16.5oz
CTN QTY 12 €26.68
SPSGVWBM1 24cm 9½" 28.4cl 10oz
CTN QTY 12 €22.86
SPSGOP121
CHEFS' OBLONG PLATE No.4
SPSGXO141 35.5 x 18.9cm 13⅞" x 7⅜"
CTN QTY 6 €44.47
CHEFS' OBLONG PLATE No.3 SPSGXO111 29.8 x 15.3cm 11¾" x 6" CTN QTY 12 €30.01












SPSGSP111 25.2cm 10" CTN QTY 12 €23.81
- Under glaze print finish meaning long-lasting results.
















Studio Prints Agano design is a contemporary take on traditional Japanese ceramics. Ideal for food presentation, the linear and radial pattern draws the eye to the centre of the plate.












The Med Tiles design is an impression of the antique Moorish tiles found in the Mediterranean cities of Spain, Portugal and North Africa. Inspired by the vast heritage behind these patterns, the design features a worn and aged look.



























Price shown is price per piece
PRAGUE ROSE CHINTZ PLATE
RCP VP111 30.5cm 12"
CTN QTY 6 €19.58
RCP VP581 27.6cm 10⅞"
CTN QTY 6 €15.79
PRAGUE ROSE CHINTZ PLATE






RCP VP8 1 21cm 8¼"
CTN QTY 6 €10.11
PRAGUE ROSE CHINTZ TRIANGLE PLATE
RCP TR9 1 22.9cm 9"
CTN QTY 12 €15.58
PRAGUE ROSE CHINTZ RECTANGULAR TILE


RCP RST 1 37.6 x 14cm 14¾" x 5½"
CTN QTY 4 €42.03 (Fits ZCAWWBDD1)
GREY ROSE
CHINTZ PLATE
RCG VP111 30.5cm 12"
CTN QTY 6 €19.58
RCG VP581 27.6cm 10⅞"
CTN QTY 6 €15.79
GREY ROSE CHINTZ PLATE




RCG VP8 1 21cm 8¼" CTN QTY 6 €10.11
GREY ROSE
CHINTZ OVAL PLATE

RCG OP121 31.7cm x 25.5 cm 12½" x 10" CTN QTY 6 €31.85
CRANBERRY ROSE CHINTZ PLATE
RCC VP111 30.5cm 12"
CTN QTY 6 €19.58
RCC VP581 27.6cm 10⅞
CTN QTY 6 €15.79
CRANBERRY ROSE CHINTZ PLATE
RCC VP651 17cm 6⅝"
CTN QTY 6 €8.21
CRANBERRY ROSE CHINTZ OVAL PLATE



RCC OP121 31.7 x 25.5cm 12½" x 10"
CTN QTY 6 €31.85
CRANBERRY ROSE CHINTZ TILE
RCC ATE 1 26.5 x 17cm 10⅝" x 6⅝"
CTN QTY 4 €30.02
CRANBERRY TOILE PLATE
TOC VP111 30.5cm 12"
CTN QTY 6 €19.58
CRANBERRY TOILE PLATE
TOC VP8 1 21cm 8¼" CTN QTY 6 €10.11
CRANBERRY TOILE CHEFS OBLONG PLATE No.3 TOC XO111 29.8cm x 15.3cm 11¾" x 6" CTN QTY 12 €30.01



GEORGIAN TEACUP
WH GTC71 19.8cl 7oz H: 7cm Dia: 9cm CTN QTY 12 €6.87
GEORGIAN TEACUP
BWL GTC71 19.8cl 7oz H: 7cm Dia: 9cm
CTN QTY 12 €9.68
BLUE BRAMBLE
GEORGIAN TEACUP
BBA GTC71 19.8cl 7oz H: 7cm Dia: 9cm
CTN QTY 12 €9.68
CRANBERRY WILLOW
GEORGIAN TEACUP
CWL GTC71 19.8cl 7oz H: 7cm Dia: 9cm CTN QTY 12 €9.68
CRANBERRY BRAMBLE GEORGIAN TEACUP
CBA GTC71 19.8cl 7oz
H: 7cm Dia: 9cm CTN QTY 12 €9.68


BWL PS301 85.2cl 30oz H: 17.5cm
CTN QTY 4 €44.03
REPLACEMENT LID
BWL LS301
CTN QTY 6 €13.03
BWL PS151 42cl 15oz H: 14.5cm CTN QTY 4 €35.02 REPLACEMENT LID BWL LS151 CTN QTY 6 €13.03
BLUE WILLOW SANDRINGHAM JUG BWL JS251 14cl 5oz H: 10cm CTN QTY 4 €14.02
BLUE WILLOW OPEN SANDRINGHAM SUGAR BOWL BWL B35 1 9cm 3½" CTN QTY 12 €9.99
GEORGIAN SAUCER
WH GTS 1 14.1cm 5½"
CTN QTY 12 €4.56
(Fits all teacups above)
SUGAR BOWL LID BWL LS 1 CTN QTY 6 €13.03

BLUE WILLOW
GEORGIAN SAUCER
BWL GTS 1 14.1cm 5½"
CTN QTY 12 €6.45 (Fits all teacups above)
BLUE BRAMBLE
GEORGIAN SAUCER
BBA GTS 1 14.1cm 5½"
CTN QTY 12 €6.45 (Fits all teacups above)
CRANBERRY WILLOW GEORGIAN SAUCER
CWL GTS 1 14.1cm 5½"
CTN QTY 12 €6.45 (Fits all teacups above)
CRANBERRY BRAMBLE
GEORGIAN SAUCER
CBA GTS 1 14.1cm 5½"
CTN QTY 12 €6.45
(Fits all teacups above)
- Under glaze print finish meaning long-lasting results.
VINTAGE PRINTS • CHURCHILL SUPER VITRIFIED
COUPE













is a collection of stylish tableware decorated in artisan style glazes. The appearance of studio pottery is created through glaze finishes and an exposed biscuit base in the earthy Churchill Emerge coloured body.


























COUPE PLATE
WHVMEV111 28.8cm 11¼" CTN QTY 12 €14.87 WHVMEV101 26cm 10¼” CTN QTY 12 €10.73
COUPE PLATE
WHVMEVP81 21.7cm 8 " CTN QTY 12 €8.82 WHVMEVP61 16.5cm 6½” CTN QTY 12 €5.87
COUPE BOWL
WHVMEVB91 24.8cm 9¾ 113.6cl 40oz
CTN QTY 12 €14.87
WHVMEVB71 18.2cm 7¼” 42.6cl 15oz
CTN QTY 12 €8.86
CHEFS’ WALLED PLATE






WHVMWP261 26cm 10¼” H: 2cm
CTN QTY 6 €22.61
WHVMWP211 21cm 8¼” H: 2cm
CTN QTY 6 €17.77
TRIANGLE PLATE
WHVMTR101 26.5cm 10½
CTN QTY 12 €17.75 WHVMTR9 1 22.9cm 9” CTN QTY 12 €12.27
TRIANGLE PLATE
WHVMTR7 1 19.2cm 7¾"

CTN QTY 12 €9.58
TRIANGLE BOWL
WHVMTRB91 23.5cm 9¼" 60cl 21oz
CTN QTY 12 €20.44
TRIANGLE BOWL
WHVMTRB71 18.5cm 7¼" 37cl 13oz
CTN QTY 12 €15.03
CHEFS’ OBLONG PLATE No.4
WHVMXO141 35.5 x 18.9cm 13⅞ x 7⅜" CTN QTY 6 €33.78
CHEFS’ OBLONG PLATE No.3
WHVMXO111 29.8 x 15.3cm 11¾ x 6” CTN QTY 12 €22.59
CAPPUCCINO CUP
WHVMCB281 34cl 12oz H: 5.5cm Dia: 11cm
CTN QTY 12 €8.69
WHVMCB201 22.7cl 8oz H: 5.5cm Dia: 9.5cm
CTN QTY 12 €6.93
SAUCER






WHVMCSS 1 15.6cm 6¼”
CTN QTY 12 €5.03 (Fits WHVMCB281 & WHVMCB201)
ESPRESSO CUP
ESPRESSO
SUGAR BOWL
WHVMSSGR1 22.7cl 8oz H: 6.2cm Dia: 9.8cm
CTN QTY 12 €6.32

Coastal Sand is a hand applied spinwash that enhances the intricate Isla embossment. The soft, neutral tone is inspired by the shoreline and is perfect for mixing with Isla white and other spinwash colours.












Inspired by the Shoreline
The distinctive and elegant Isla embossment emulates the natural beauty and patterns of the coast. Enhanced with colour, the intricate Isla embossment intensifies with the addition of Shale Grey. Statement colour items within the collection complement the full white embossed range.






























Inspired by the Shoreline
PRESENTATION PLATE
WHISIP121 30.5cm 12" CTN QTY 12 €17.40
FOOTED PLATE
WHISIF111 30.5cm 12" CTN QTY 12 €12.77





FOOTED PLATE
FOOTED PLATE
FOOTED PLATE




WHISIF9 1 23.4cm 9⅛" CTN QTY 12 €7.54
PLATE
WHISIP8 1 21cm 8¼" CTN QTY 12 €6.29
DEEP COUPE PLATE
The contemporary and intricate Isla design is inspired by shapes and textures found along the seashore. Featured on a comprehensive range of tableware shapes and beverage items, the modern yet graceful Isla embossment is reminiscent of the coastline. Covered by Churchill 5 Year Edge



PLATE





WHISIP651 17cm 6⅝" CTN QTY 12 €4.79
WHISIF581 27.6cm 10⅞" CTN QTY 12 €10.37 Items with a



WHISIF101 26.1cm 10¼"
CTN QTY 12 €8.74
DEEP COUPE PLATE
WHISID271 28.1cm 11'' H: 3.7cm
CTN QTY 12 €18.54
Price shown is price per piece
WHISIWBL1 28cm 11" 46.8cl 16.5oz
CTN QTY 12 €16.46 WHISIWBM1 24cm 9½” 28.4cl 10oz
CTN QTY 12 €14.07
WHISIPPB1 30.8cm 12⅛" 87.5cl 30.5oz
CTN QTY 12 €20.79


WHISIRSB1 24.9cm 9¾" 50cl 17.5oz CTN QTY 12 €9.37
WHISIPOB1 17cm 6⅝" 25.5cl 9oz CTN QTY 12 €4.69
CHEFS' OBLONG PLATE





WHISIO141 35.5 x 18.9cm 13⅞" x 7⅜'' CTN QTY 6 €35.32 WHISIO111 29.5 x 15cm 11¾” x 6’’ CTN QTY 12 €23.62
CHEFS’
TRIANGLE PLATE
WHISIC351 35.5 x 18.8cm 13¾ x 7⅜” CTN QTY 6 €30.00
CHEFS’
TRIANGLE PLATE
WHISIC301 30.4 x 20.5cm 12 x 8” CTN QTY 6 €25.86


WHISIB141 36cl 12.6oz
CTN QTY 6 €8.57 (Fits WH FS6 1)
STACKING CUP
WHISISC81 22cl 8oz H: 7cm Dia: 8.5cm
CTN QTY 12 €8.39
WHISIT121 34cl 12oz H: 7cm Dia: 10.5cm
CTN QTY 12 €8.68
TEA CUP
WHISIT8 1 22cl 8oz H: 6.5cm Dia: 9.5cm CTN QTY 12 €6.09
WHISISM 1 15cm 5⅞" CTN QTY 12 €4.73 (Fits WHISISC81, WHISIT121, WHISIT8 1)
STACKING CUP
WHISISC31 9cl 3oz H: 5.3cm Dia: 6cm CTN QTY 12 €6.63
ESPRESSO CUP
WHISIE3 1 11cl 3.9oz H: 5.8cm Dia: 6.4cm CTN QTY 12 €3.84
SAUCER
WHISISS 1 12.8cm 5" CTN QTY 12 €3.84 (Fits WHISISC31, WHISIE3 1)


WHISIM121 34cl 12oz H: 11cm Dia: 10.6cm CTN QTY 12 €9.60
WHISIT301 85.2cl 30oz H: 15cm
CTN QTY 4 €39.16
REPLACEMENT LID
WHISL30 1
CTN QTY 6 €10.11
WHISIT151 42.6cl 15oz H: 10.5cm
CTN QTY 4 €29.74
REPLACEMENT LID
WHISL15 1
CTN QTY 6 €10.11

TEA FILTER
SS TF 1 H: 7.2cm 2¾" Dia: 6cm 2¼"
CTN QTY 4 €7.80 (Fits WHISIT151)
WHISIUG81 22.7cl 8oz H: 7cm
CTN QTY 4 €16.62
JUG
WHISIUG41 11.4cl 4oz H: 5.5cm
CTN QTY 4 €13.44
JUG
WHISIUG21 5.6cl 2oz H: 4.4cm CTN QTY 12 €8.54
OPEN SUGAR BOWL
WHISISGR1 22.7cl 8oz H: 6.2cm Dia: 9.8cm CTN QTY 12 €6.65
OPTIONAL LID (plain)
WH SSLD1 CTN QTY 12 €9.28

Inspired by the Shoreline
ORGANIC GLASS PLATE
GLCLOP291 29.5cm 11 "
CTN QTY 6 €23.47
ORGANIC GLASS PLATE




GLCLTBP11 22.5cm 8⅞" CTN QTY 6 €17.37
ORGANIC GLASS BOWL
GLCLOB241 24.5cm 9 ” 110cl 37oz
CTN QTY 6 €21.44
ORGANIC GLASS BOWL
GLCLTBB21 21cm 8¼" 60cl 21oz
CTN QTY 6 €17.37
ORGANIC GLASS BOWL
GLCLTBB11 17cm 6½" 26.5cl 9.3oz
CTN QTY 6 €11.58
ORGANIC OVAL GLASS PLATTER









GLCLTBO11 30 x 16.2cm 11¾" x 6 " CTN QTY 6 €17.37
COASTAL SAND FOOTED PLATE
ANISIF581 27.6cm 10⅞" CTN QTY 12 €15.79
COASTAL
1 21cm
12
OCEAN BLUE FOOTED PLATE
OCISIF581 27.6cm 10⅞"
CTN QTY 12 €15.79
OCEAN BLUE PLATE

OCISIP8 1 21cm 8¼"
CTN QTY 12 €10.34















dusty blue tone of Bamboo Mist is hand applied to Bamboo, enhancing the intricate embossment with colour inspired by the landscape.















Taking inspiration from nature, Bamboo has a sculptural grace which balances design with performance. The raised embossed design is influenced by the natural flowing form of bamboo. Available in a comprehensive collection of items, perfect for all manner of hospitality setting, including large scale catering.
PRESENTATION PLATE
WHBALP121 30.5cm 12" CTN QTY 12 €17.40
WIDE RIM PLATE
WHBALW111 30.5cm 12" CTN QTY 12 €18.45
WIDE RIM PLATE
WHBALW581 27.2cm 10⅝" CTN QTY 12 €14.80
FOOTED PLATE
WHBALF111 30.5cm 12"
CTN QTY 12 €12.77
FOOTED PLATE
WHBALF581 27.6cm 10⅞"
CTN QTY 12 €10.37
FOOTED PLATE
FOOTED PLATE
PLATE
PLATE
WHBALP581 27.6cm 10⅞" CTN QTY 12 €10.33
WHBALF101 26.1cm 10¼" CTN QTY 12 €8.74 PLATE







WHBALP101 26.1cm 10¼" CTN QTY 12 €8.73
WHBALF9 1 23.4cm 9⅛" CTN QTY 12 €7.54
WHBALP111 30.5cm 12"
CTN QTY 12 €12.77

PLATE
WHBALP651 17cm 6⅝" CTN QTY 12 €4.79
WHBALP9 1 23.4cm 9⅛" CTN QTY 12 €7.54
PLATE












WHBALP8 1 21cm 8¼"
CTN QTY 12 €6.29
Price shown is price per piece
QUARTZ BLACK
DEEP COUPE PLATE
RKBQLD251 25.5cm 10" H: 3.5cm
CTN QTY 12 €23.20
DEEP COUPE PLATE
WHBALD271 28.1cm 11" H: 3.7cm
CTN QTY 12 €18.54
DEEP COUPE PLATE
WHBALD251 25.5cm 10" H: 3.5cm
CTN QTY 12 €15.58
WIDE RIM BOWL
WHBALWBL1 28cm 11" 46.8cl 16.5oz
CTN QTY 12 €16.46
WIDE RIM BOWL
WHBALWBM1 24cm 9½" 28.4cl 10oz
CTN QTY 12 €14.07
PASTA BOWL
WHBALRPP1 30.8cm 12⅛" 59.6cl 21oz CTN QTY 12 €23.30
RIMMED BOWL
WHBALRSB1 24.9cm 9¾" 50cl 17.5oz
CTN QTY 12 €9.37
OATMEAL BOWL WHBALPOB1 17cm 6⅝" 25.5cl 9oz
CTN QTY 12 €4.69
TRIANGLE
SHALLOW BOWL
WHBALB271 27.2 x 26.7cm 10¾" x 10½'' 78cl 27oz
CTN QTY 12 €23.52
TRIANGLE
SHALLOW BOWL WHBALB231 21 x 21cm 8¼" x 8¼" 41cl 14oz







CTN QTY 12 €18.09
OBLONG PLATE












WHBALO111 29.5 x 15cm 11¾" x 5½" CTN QTY 12 €23.62
SQUARE PLATE
WHBALS111 25.5cm 10" CTN QTY 12 €19.07
SQUARE PLATE
WHBALS9 1 22cm 8½"
CTN QTY 12 €12.73
SQUARE PLATE
WHBALS7 1 17cm 6½" CTN QTY 12 €9.07

OVAL PLATE
WHBALO141 34.6 x 26.3 x 5cm 13½" x 9" x 2" CTN QTY 12 €31.81
OVAL PLATE
WHBALO121 29 x 22.7 x 3.8cm 11½" x 9" x 1½" CTN QTY 12 €24.93
OVAL PLATE
WHBALO101 25 x 19.4 x 3.2cm 9½" x 7½" x 1¼"
CTN QTY 12 €20.16
OVAL PLATE WHBALO8 1 19.5 x 15 x 2.5cm 7¾" x 5⅞" x 1"






CTN QTY 12 €15.42
RIMMED OVAL DISH
WHBALR131 33cm 13" CTN QTY 6 €30.95
RIMMED OVAL DISH

WHBALR111 28cm 11" CTN QTY 6 €21.15
STACKING BOWL
WHBALB141 36cl 12.6oz H: 5.5cm
Dia: 11.5cm
CTN QTY 6 €8.57
STACKING BOWL
WHBALB101 28cl 10oz H: 4.5cm Dia: 11.5cm
CTN QTY 6 €7.38
HANDLED STACKING BOWL
WHBALH141 36cl 12.6oz
H: 5.5cm
Dia: 11.5cm
CTN QTY 6 €13.18
BOWL STAND WHBALS6 1 15.2cm 6" CTN QTY 12 €4.72 (Fits WHBALB141, WHBALB101, WHBALH141)
SNACK BOWL
WHBALS141 13cm 5¼'' 40cl 14oz
CTN QTY 12 €9.45
SHALLOW BOWL
WHBALSB91 13cm 5¼'' 26cl 9oz
CTN QTY 12 €9.15
SHALLOW BOWL WHBALSB61 11.6cm 4 '' 20cl 7oz
CTN QTY 12 €7.99
CHIP MUG
WHBALSCM1 10cm 7 '' 29cl 11oz
CTN QTY 12 €8.23
DEEP BOWL
WHBALSDB1 10.2cm 4'' 24cl 8.4oz
CTN QTY 12 €7.65
DIP POT
WHBALSD41 8.5cm 3 '' 11cl 4oz CTN QTY 12 €7.36
DIP POT
WHBALSD21 7cm 2 '' 6cl 2oz
CTN QTY 12 €5.52
RICE BOWL
WHBALB451 11.5cm 4½" 28cl 10oz
CTN QTY 12 €6.87 (Fits WHBALSM 1)
super vitrified
Price shown is price per piece
STACKING CUP
WHBALSC81 22cl 8oz H: 7cm Dia: 8.5cm CTN QTY 12 €8.39
STACKING CUP
WHBALC281 28cl 10oz H: 6.5cm Dia: 10cm CTN QTY 12 €7.91
STACKING CUP
WHBALC201 20cl 7oz H: 5.5cm Dia: 9cm CTN QTY 12 €6.09

COFFEE CUP


WHBALT121 34cl 12oz H: 7cm Dia: 10.5cm CTN QTY 12 €8.68
TEA CUP

WHBALT8 1 22cl 8oz H: 6.5cm Dia: 9.5cm CTN QTY 12 €6.09
SAUCER
WHBALSM 1 15cm 5⅞"
CTN QTY 12 €4.73 (Fits WHBALSC81, WHBALC281, WHBALC201, WHBALC161, WHBALT121, WHBALT8 1)
STACKING CUP
WHBALSC31 9cl 3oz H: 5.3cm Dia: 6cm CTN QTY 12 €6.63
ESPRESSO CUP

WHBALE3 1 11cl 3.5oz H: 5.8cm Dia: 6.4cm CTN QTY 12 €3.84
SAUCER

WHBALSS 1 12.8cm 5" CTN QTY 12 €3.84 (Fits WHBALSC31, WHBALC9 1, WHBALE3 1)
MUG
WHBALM121 34cl 12oz H: 11cm Dia: 10.6cm CTN QTY 12 €9.60
BEVERAGE POT
WHBALB301 85.2cl 30oz H: 15cm CTN QTY 4 €39.16 REPLACEMENT LID WH RL301 CTN QTY 6 €10.11

BEVERAGE POT


WHBALB151 42.6cl 15oz H: 10.5cm CTN QTY 4 €29.74 REPLACEMENT LID WH RL151 CTN QTY 6 €10.11


JUG
WHBALJ8 1 22.7cl 8oz H: 8.5cm CTN QTY 4 €16.62 WHBALJ4 1 11.4cl 4oz H: 7cm CTN QTY 4 €13.44
JUG
WHBALJ2 1 5.6cl 2oz H: 5cm CTN QTY 12 €8.54
OPEN SUGAR BOWL
WHBALSGR1 22.7cl 8oz H: 6.2cm Dia: 9.8cm CTN QTY 12 €6.65
OPTIONAL LID (plain)
WH SSLD1 CTN QTY 12 €9.28
SALT
WHBALSA 1 7cm 2½" CTN QTY 12 €13.14 PEPPER WHBALPE 1 7cm 2½" CTN QTY 12 €13.14














Profile flatware has an enhanced face profile with a defined rim to showcase the food at its very best. The slim and defined rolled edge ensures excellent durability. The plates and rimmed bowls are all streamlined up to 20% lighter than Classic plates making them an easy to handle solution.



















12 €7.57

Price shown is price per piece
WIDE RIM BOWL
WH VWBM1 24cm 9½" 28.4cl 10oz
CTN QTY 12 €12.78
NOODLE BOWL
WH NDBL1 107.5cl 37.8oz H: 8cm Dia: 18.3cm
CTN QTY 6 €12.19
DEEP BOWL
WH DPBW1 77cl 26oz H: 7cm Dia: 15.5cm
CTN QTY 6 €10.57
STACKING BOWL
WH VB141 36cl 12.6oz H: 5.5cm Dia: 11.5cm
CTN QTY 6 €7.47
STACKING BOWL
WH VB101 28cl 10oz H: 4.5cm Dia: 11.5cm CTN QTY 6 €6.43 (Fits WH FS6 1)
HANDLED STACKING BOWL
WH VH141 36cl 12.6oz H: 5.5cm Dia: 11.5cm CTN QTY 6 €11.48 (Fits WH FS6 1)
BOWL STAND
WH FS6 1 15.2cm 6" CTN QTY 24 €4.16 (Fits WH VB101, WH VB141 & WH VH141)
STACKING CUP
WH VSC81 22cl 8oz H: 7cm Dia: 8.5cm CTN QTY 12 €5.52
STACKING CUP
WH VC281 28cl 10oz H: 6.5cm Dia: 10cm
CTN QTY 12 €6.87
STACKING CUP
WH VC201 20cl 7oz H: 5.5cm Dia: 9cm
CTN QTY 12 €5.27
COFFEE CUP

WH VT121 34cl 12oz H: 7cm Dia: 10.5cm CTN QTY 12 €7.50

TEACUP
WH VT8 1 22cl 8oz H: 6.5cm Dia: 9.5cm
CTN QTY 12 €5.73
SAUCER
WH VSM 1 15cm 5⅞" CTN QTY 12 €4.10 (Fits WH VC281, WH VC201, WH VSC81, WH VT121 & WH VT8 1)
STACKING CUP
WH VSC31 9cl 3oz H: 5.3cm Dia: 6cm CTN QTY 12 €3.73
ESPRESSO CUP



WH VE3 1 11cl 3.9oz H: 5.8cm Dia: 6.4cm CTN QTY 12 €4.94
SAUCER



WH VSS 1 12.8cm 5" CTN QTY 12 €3.33
(Fits WH VC111, WH VC9 1 WH VSC31 & WH VE3 1)
MUG
WH VM121 34cl 12oz H: 11cm Dia: 8cm
CTN QTY 12 €8.36
BEVERAGE POT
WH SB301 85.2cl 30oz H: 15cm
CTN QTY 4 €36.06
REPLACEMENT LID
WH RL301
CTN QTY 6 €10.11
BEVERAGE POT
WH SB151 42.6cl 15oz H: 10.5cm
CTN QTY 4 €27.38
REPLACEMENT LID WH RL151




CTN QTY 6 €10.11
ELEGANT TEAPOT



WH EB151 42.6cl 15oz H: 11.5cm
CTN QTY 4 €27.38
REPLACEMENT LID WHISL15 1

CTN QTY 6 €10.11
STAINLESS STEEL
TEA FILTER
SS TF 1 H: 7.2cm 2¾" D: 6cm 2 /4" CTN QTY 4 €7.80 (Fits WH EB151)

JUG
WH SJ8 1 22.7cl 8oz H: 8.5cm CTN QTY 4 €14.43
JUG
WH SJ4 1 11.4cl 4oz H: 7cm CTN QTY 4 €11.69
JUG WH SJ2 1 5.6cl 2oz H: 5cm
CTN QTY 12 €7.44
OPEN SUGAR BOWL


WH SSGR1 22.7cl 8oz H: 6.2cm Dia: 9.8cm
CTN QTY 12 €5.75
OPTIONAL LID
WH SSLD1
CTN QTY 12 €9.28
BUTTER BLOCK
WH CBB 1 6cm 2⅛" 2.8cl 1oz
CTN QTY 12 €5.53
SUGAR SACHET HOLDER
WH SH 1 11.7 x 7.3cm 4⅝" x 2⅞"
CTN QTY 6 €18.31
WH SSA 1 7cm 2½"
CTN QTY 12 €10.74
PEPPER
WH SPE 1 7cm 2½"
CTN QTY 12 €10.74
BUDVASE
WH SBV 1 12.5cm 5" CTN QTY 6 €11.63



















CHEFS WALLED PLATE
WH WP281 27.5cm 10¾" H: 2cm
CTN QTY 6 €26.79
WH WP261 26cm 10¼" H: 2cm
CTN QTY 6 €20.55
CHEFS’ WALLED PLATE


WH WP211 21cm 8¼” H: 2cm
CTN QTY 6 €16.15
WH WP161 15.7cm 6⅛” H: 2cm
CTN QTY 6 €15.00
CHEFS’ TRIANGLE WALLED PLATE
WH WT271 26cm 10¼"
H: 2cm
CTN QTY 6 €22.61
WH WT211 20cm 7⅞” H: 2cm
CTN QTY 6 €17.77
CHEFS' TRIANGLE PLATE
WH TC361 35.6 x 25 cm 14" x 9¾"
CTN QTY 6 €30.99
WH TC351 35.5 x 18.8cm 13¾" x 7 "
CTN QTY 6 €28.04
CHEFS' TRIANGLE PLATE
WH TC301 30.4 x 20.5cm 12" x 8" CTN QTY 6 €24.16
CHEFS' TRIANGLE PLATE
WH TC261 26.5 x 20.5cm 10 " x 8" CTN QTY 12 €20.36
CHEFS' TRIANGLE PLATE
WH TC201 20 x 15 cm
7⅞" x 5⅞"
CTN QTY 12 €12.86
TRIANGLE SHALLOW BOWL
WH TB271 27.2 x 26.7cm 10¾" x 10½"
CTN QTY 12 €20.44
WH TB231 21 x 21cm 8¼" x 8¼"
CTN QTY 12 €15.72
CHEFS' GEO PLATE
WH GE351 35 x 18.5cm 13¾" x 7¼"
CTN QTY 6 €29.37
WH GE301 30 x 15.5cm 11¾” x 6⅛”
CTN QTY 12 €19.52
CHEFS' OBLONG PLATE No. 2
WH XO101 26.9 x 12.7cm 10½" x 5"
CTN QTY 12 €18.17
CHEFS' OBLONG PLATE No. 1 WH XO7 1 20 x 12.1cm 7 " x 4¾" CTN QTY 12 €14.28

















CHEFS' OVAL PLATE
WH OV351 34.7 x 17.3 cm 13⅝" x 6¾"
CTN QTY 6 €28.04
WH OV301 29.9 x 15 cm 11¾" x 5⅞"
CTN QTY 12 €18.48
CHEFS' OBLONG PLATE No. 6 WH OBL21 23.7 x 15.7cm 9 " x 6⅛"
CTN QTY 12 €18.64
CHEFS' OBLONG PLATE No. 5 WH OBL11 15.4 x 12.6cm 6" x 5"

CTN QTY 12 €11.61
Chefs' Plate shapes also available in Stonecast from page 58 and Studio Prints from page 146
The versatile squares and oblongs within the X Squared ranges are ideal for a contemporary modular look. X Squared features soft edges, while the modern lines of X Squared+ are more angular. The collections are perfect space saving solutions for serving mains, starters, desserts and sharing plates.
































Price
Soft and organic triangle shapes across a range of pure white plates and bowls, ideal for serving all manner of dishes. Lotus offers innovation in shape design, adding value to the dining experience and elevating food presentation.





TRIANGLE PLATE
WH TR121 31.1cm 12¼"
CTN QTY 6 €22.33
TRIANGLE PLATE
WH TR101 26.5cm 10½"
CTN QTY 12 €16.13
TRIANGLE PLATE
WH TR9 1 22.9cm 9"
CTN QTY 12 €11.14
TRIANGLE PLATE
WH TR7 1 19.2cm 7¾"
CTN QTY 12 €8.70
TRIANGLE BOWL
WH TRB91 23.5cm 9¼" 60cl 21oz
CTN QTY 12 €18.58
TRIANGLE BOWL
WH TRB71 18.5cm 7¼" 37cl 13oz CTN QTY 12 €13.66
TRIANGLE BOWL
WH TRB61 15.3cm 6" 26cl 9oz CTN QTY 12 €11.82

TRIANGLE SHALLOW BOWL
WH TB271 27.2 x 26.7cm 10¾" x 10½"
CTN QTY 12 €20.44
TRIANGLE SHALLOW BOWL
WH TB231 21 x 21cm 8¼" x 8¼" CTN QTY 12 €15.72
CHEFS' TRIANGLE PLATE WH TC361 35.6 x 25 cm 14" x 9¾" CTN QTY 6 €30.99




CHEFS' TRIANGLE PLATE
WH TC351 35.5 x 18.8cm 13¾" x 7 " CTN QTY 6 €28.04
CHEFS' TRIANGLE PLATE WH TC301 30.4 x 20.5cm 12" x 8" CTN QTY 6 €24.16












CHEFS' TRIANGLE PLATE WH TC261 26.5 x 20.5cm 10¼" x 7⅞" CTN QTY 12 €20.36
CHEFS'
LOTUS • CHURCHILL SUPER VITRIFIED










The original Classic collection, simple shapes designed to perform in the most rigorous of hospitality environments. A comprehensive solution of core tableware pieces, including eight plate sizes, ideal to form the basis of any tabletop combination.













CLASSIC

Nova is a range of plates and bowls in key sizes combining understated design with functionality and durability. The narrow rim of Nova allows greater service area for food presentation. Ideal for all types of dining occasions no matter the scale.











NOVA PLATE
WH P11 1 28cm 11"
CTN QTY 12 €13.29
NOVA PLATE
WH P10 1 25.4cm 10"
CTN QTY 24 €9.31
NOVA PLATE
WH P9 1 23cm 9"
CTN QTY 24 €7.91
NOVA PLATE
WH P8 1 20.3cm 8"
CTN QTY 24 €5.94
NOVA PLATE
WH P7 1 17.8cm 7"
CTN QTY 24 €4.91
NOVA PLATE
WH P6 1 15.2cm 6"
CTN QTY 24 €4.08
PIZZA PLATE/PLATTER

WH PPP 1 34cm 13½"
CTN QTY 6 €21.09
NOVA RIMMED SOUP
WH NS8 1 21cm 8¼" 49cl 17.2oz
CTN QTY 24 €7.75
This collection of White bowls, ovals and accessories provide a comprehensive choice of key shapes and sizes. All products perfectly co-ordinate with the other Churchill Super Vitrified ranges.



OVAL PLATE / PLATTER WH D14 1 36cm 14¼" CTN QTY 12 €27.93

OVAL PLATE / PLATTER WH D13 1 34cm 13¼" CTN QTY 12 €25.19
OVAL PLATE / PLATTER WH D12 1 30.5cm 12" CTN QTY 12 €21.36
OVAL PLATE / PLATTER WH D11 1 28cm 11" CTN QTY 12 €18.38










OVAL PLATE / PLATTER WH D10 1 25.4cm 10"
OVAL PLATE / PLATTER WH D9 1 23cm 9" CTN QTY 12 €14.15
OVAL PLATE / PLATTER WH D8 1 20.3cm 8" CTN QTY 12 €10.65
CLASSIC RIMMED SOUP

WH S9 1 23cm 9" 32.5cl 11.4oz CTN QTY 24 €8.17
SERVING BOWL
WH SB8 1 21.4cm 8½" 137cl 48.2oz CTN QTY 12 €9.99
Price shown is price per piece
COUPE BOWL
WH C7 1 18.5cm 7¼" 54cl 19oz
CTN QTY 24 €7.13
RICE BOWL
WH RB451 11.5cm 4½" 28cl 10oz
CTN QTY 24 €8.20
LARGE FOOTED BOWL
WH LSB 1 14.5cm 5½" 71cl 25oz
CTN QTY 6 €13.09
SOUP BOWL
WH SB 1 13cm 5⅛" 54cl 19oz
CTN QTY 6 €10.28
SOUP BOWL
WH SMB 1 12cm 4¾" 44cl 16oz
CTN QTY 6 €8.94
SOUP BOWL
WH SSB 1 11cm 4⅜" 28cl 10oz
CTN QTY 24 €7.91
CONSOMMÉ BOWL (without handles)
WH NSU 1 11.5cm 4½" 40cl 14oz CTN QTY 24 €7.22

CONSOMMÉ BOWL (without handles)

WH ASU 1 10.5cm 4⅛" 28cl 10oz
CTN QTY 24 €6.84
CONSOMMÉ BOWL (with handles)







WH CSC 1 11.5cm 4½" 40cl 14oz
CTN QTY 24 €12.95
CONSOMMÉ STAND
WH TSOL1 15cm 5⅞"
CTN QTY 24 €4.22
SANDRINGHAM JUG/ CREAMER
WH JS1 1 56cl 20oz H: 15cm
CTN QTY 4 €19.68 WH JS501 28cl 10oz H: 12cm
CTN QTY 4 €15.54
SANDRINGHAM JUG/ CREAMER




WH JS251 14cl 5oz H: 10cm
CTN QTY 4 €11.71
GRAVY BOAT
WH GB 1 36.2cl 13oz CTN QTY 4 €21.02
MINI SAUCE BOAT
WH MSB 1 11.2cl 4oz H: 6.5cm Dia: 11cm CTN QTY 6 €12.20
GRAVY BOAT STAND




WH D8 1 20.3cm 8" CTN QTY 12 €10.65
CRESCENT SALAD PLATE



WH CR 1 20.3cm 8" CTN QTY 12 €15.34

BUTTER PAD
WH BP 1 10cm 4"
CTN QTY 24 €3.66
VINEGAR / OIL BOTTLE
WH VB 1 16cl 6oz H: 13cm
CTN QTY 6 €17.13
EGG CUP
WH EC 1 4.8cm 1⅞"
CTN QTY 24 €3.97
SACHET HOLDER
WH SH 1 11.7 x 7.3cm 4⅝" x 2⅞"
CTN QTY 6 €18.31
BUD VASE
WH BV 1 12.7cm 5"
CTN QTY 6 €13.16
SANDRINGHAM /
NOVA SUGAR BOWL
WH B35 1 9cm 3½" 25.6cl 9oz CTN QTY 12 €6.28
SUGAR BOWL LID
WH LS 1 9cm 3½"
CTN QTY 6 €10.49 (bowl does not come with lid as standard)

SANDRINGHAM
SALT & PEPPER
WH SS 1 8.4cm 3¼"
CTN QTY 12 €12.15
WH PS 1 8.4cm 3¼" CTN QTY 12 €12.15
The distinctive Buckingham design has a timeless presence, featuring a decorative embossment on classical white, the design has a vintage charm. Combine Buckingham with other white collections for a simplistic look, or mix in some colour with Vintage Prints for a retro feel.


BUCKINGHAM PLATE
W BP121 30.5cm 12"
CTN QTY 12 €24.07
W BP111 28cm 11"
CTN QTY 12 €16.78
BUCKINGHAM PLATE
W BP101 25.4cm 10"
CTN QTY 24 €12.87
W BP8 1 21.5cm 8½"
CTN QTY 24 €10.55
BUCKINGHAM PLATE
W BP651 16.5cm 6½"
CTN QTY 24 €7.11
OVAL PLATE/PLATTER









W BD121 30.5cm 12"
CTN QTY 12 €29.93
W BD101 25.4cm 10"
CTN QTY 12 €22.16
PASTA PLATE

W BPP 1 28cm 11" 62.5cl 22oz

CTN QTY 12 €23.15
RIMMED SOUP BOWL





W BS9 1 23cm 9" 33cl 11.6oz
CTN QTY 24 €10.42
OATMEAL BOWL
W BO 1 18cm
CONTOUR
CONTOUR CHIP MUG
CONTOUR
CONTOUR DIP POT
WH BSD41 11cl 4oz H: 5cm Dia: 8.5cm 3⅜" CTN QTY 12 €6.01
CONTOUR DIP POT

WH BSD21 6cl 2oz H: 4cm Dia: 7cm 2¾" CTN QTY 12 €4.49


LINEAR SOUP BOWL



WH SSSB1 42.6cl 15oz H: 6.5cm Dia: 12cm 3¾" CTN QTY 12 €8.23
LINEAR CHIP MUG
WH SSCM1
Price shown is price per piece
CONTOUR NOODLE BOWL
RBBLNDBL1 107.5cl 37.8oz H: 8cm Dia: 18.3cm 7¼''
CTN QTY 6 €14.63
CONTOUR DEEP BOWL
RBBLDPBW1 77cl 26oz H: 7cm Dia: 15.5cm
CTN QTY 6 €12.31
CONTOUR SNACK BOWL
RBBLBS141 40cl 14oz H: 6.5cm Dia: 13cm 5¼"
CTN QTY 12 €9.27
CONTOUR SHALLOW BOWL
RBBLBSB91 26cl 9oz H: 4.5cm Dia: 13cm 5¼"
CTN QTY 12 €7.96 RBBLBSB61 20cl 7oz H: 4cm Dia: 11.6cm 4⅝" CTN QTY 12 €7.03
CONTOUR CHIP MUG
RBBLBSCM1 29cl 11oz H: 8cm Dia: 10cm 3⅞" CTN QTY 12 €7.88
CONTOUR DEEP BOWL
RBBLBSDB1 24cl 8.4oz H: 6cm Dia: 10.2cm 4" CTN QTY 12 €6.72
CONTOUR DIP POT
RBBLBSD41 11cl 4oz H: 5cm Dia: 8.5cm 3⅜" CTN QTY 12 €6.31
CONTOUR DIP POT
RBBLBSD21 6cl 2oz H: 4cm Dia: 7cm 2¾" CTN QTY 12 €5.04
CONTOUR SNACK BOWL
RBSABS141 40cl 14oz
H: 6.5cm Dia: 13cm 5¼"
CTN QTY 12 €9.27
CONTOUR SHALLOW BOWL RBSABSB91 26cl 9oz H: 4.5cm Dia: 13cm 5¼" CTN QTY 12 €7.96
CONTOUR SHALLOW BOWL
RBSABSB61 20cl 7oz H: 4cm Dia: 11.6cm 4⅝" CTN QTY 12 €7.03
CONTOUR CHIP MUG
RBSABSCM1 29cl 11oz H: 8cm Dia: 10cm 3⅞"
CTN QTY 12 €7.88
CONTOUR DEEP BOWL
RBSABSDB1 24cl 8.4oz H: 6cm Dia: 10.2cm 4" CTN QTY 12 €6.72
CONTOUR DIP POT
RBSABSD41 11cl 4oz H: 5cm Dia: 8.5cm 3⅜" CTN QTY 12 €6.31
CONTOUR DIP POT
RBSABSD21 6cl 2oz H: 4cm Dia: 7cm 2¾" CTN QTY 12 €5.04
CONTOUR SNACK BOWL
RBGYBS141 40cl 14oz H: 6.5cm Dia: 13cm 5¼" CTN QTY 12 €9.27
CONTOUR
CONTOUR SHALLOW BOWL RBGYBSB61 20cl 7oz H: 4cm Dia: 11.6cm 4⅝"
CTN QTY 12 €7.03
CONTOUR SNACK BOWL RBGNBS141 40cl 14oz H: 6.5cm Dia: 13cm 5¼" CTN QTY 12 €9.27
CONTOUR
CONTOUR SHALLOW BOWL
RBGNBSB61 20cl 7oz H: 4cm Dia: 11.6cm 4⅝" CTN QTY 12 €7.03
CONTOUR CHIP MUG
RBGYBSCM1 29cl 11oz H: 8cm Dia: 10cm 3⅞"
CTN QTY 12 €7.88
CONTOUR DEEP BOWL
RBGYBSDB1 24cl 8.4oz H: 6cm Dia: 10.2cm 4" CTN QTY 12 €6.72
CONTOUR DIP POT
RBGYBSD41 11cl 4oz H: 5cm Dia: 8.5cm 3⅜" CTN QTY 12 €6.31
CONTOUR DIP POT
RBGYBSD21 6cl 2oz H: 4cm Dia: 7cm 2¾" CTN QTY 12 €5.04
CONTOUR CHIP MUG
RBGNBSCM1 29cl 11oz H: 8cm Dia: 10cm 3⅞"
CTN QTY 12 €7.88
CONTOUR DEEP BOWL
RBGNBSDB1 24cl 8.4oz H: 6cm Dia: 10.2cm 4" CTN QTY 12 €6.72
CONTOUR DIP POT
RBGNBSD41 11cl 4oz H: 5cm Dia: 8.5cm 3⅜" CTN QTY 12 €6.31
CONTOUR DIP POT
RBGNBSD21 6cl 2oz H: 4cm Dia: 7cm 2¾" CTN QTY 12 €5.04
RIPPLE WHITE CHIP MUG



WH RPCM1 9.5 x 8.3cm 3⅞" x 3¼" 28cl 10oz

CTN QTY 12 €6.96
RIPPLE CINNAMON CHIP MUG
BCBRRPCM1 9.5 x 8.3cm 3⅞" x 3¼" 28cl 10oz
CTN QTY 12 €6.96



RIPPLE CINNAMON DIP POT

BCBRRPD41 7 x 6.2cm 2⅞" x 2½" 11cl 4oz
CTN QTY 12 €6.24
BCBRRPD21 5.9 x 5cm 2 " x 2" 5.7cl 2oz
CTN QTY 12 €4.65
RIPPLE SAPPHIRE CHIP MUG
BCBLRPCM1 9.5 x 8.3cm 3⅞" x 3¼" 28cl 10oz
CTN QTY 12 €6.96
RIPPLE SAPPHIRE DIP POT
BCBLRPD41 7 x 6.2cm 2⅞" x 2 ½" 11cl 4oz
CTN QTY 12 €6.24 BCBLRPD21 5.9 x 5cm 2 x 2" 5.7cl 2oz
CTN QTY 12 €4.65
SQUARE DIP POT

WH BODP1 5.5cm 2⅛" 5.7cl 2oz
CTN QTY 24 €4.66
SPARK
SPARK

W BESC1 14 x 5.8cm 2⅝" x 5½" 38.5cl 13.5oz CTN QTY 24 €11.12

WHITE SOUP BOWL
WH RBL61 47cl 16oz
H: 6.3cm Dia: 13.2cm

CTN QTY 12 €8.39
WHITE ROUND DISH
WH ID7 1 18.5 x 16.8cm 7¼" x 6⅝" 35.8cl 12.6oz
CTN QTY 12 €14.15
WHITE ROUND DISH



WH ID6 1 16 x 14.5cm 6¼" x 5¾" 24.7cl 8.7oz
CTN QTY 12 €11.40
RIPPLE WHITE DIP DISH
WH RPDD1 11.3 x 3.5cm 4½" x 1 " 14cl 5oz CTN QTY 12 €4.79
SAUCE DISH
WH SD2 1 5.68cl 2oz H: 2.7cm Dia: 8cm
CTN QTY 24 €4.10
SQUARE
SQUARE
RIPPLE CINNAMON DIP DISH BCBRRPDD1 11.3 x 3.5cm 4½" x 1 " 14cl 5oz CTN QTY 12 €4.79



ZEST WHITE BOWL

WH SBZE1 12.9 x 7.6cm 5" x 3" 50cl 17.5oz
CTN QTY 6 €9.66
ZEST SAPPHIRE BOWL
BCBLSBZE1 12.9 x 7.6cm 5" x 3" 50cl 17.5oz
CTN QTY 6 €9.66
ZEST SNACK BOWL
WH ZE121 12.1 x 6.5cm 4⅞" x 2½" 34cl 12oz
CTN QTY 12 €7.99 WH ZE101 11.6 x 6cm 4½" x 2⅜" 28cl 10oz
CTN QTY 12 €7.48
ZEST SNACK BOWL
BCBKZE121 12.1 x 6.5cm 4⅞" x 2½" 34cl 12oz
CTN QTY 12 €7.99 BCBKZE101 11.6 x 6cm 4½" x 2⅜" 28cl 10oz
CTN QTY 12 €7.48
SAUCE BOWLS
RIPPLE SAPPHIRE
DIP DISH
BCBLRPDD1 11.3 x 3.5cm 4½" x 1 " 14cl 5oz
CTN QTY 12 €4.79
BUTTER BLOCK
WH BBB 1 6cm 2⅛" 2.8cl 1oz CTN QTY 12 €5.53
BUTTER BLOCK
WH CBB 1 6cm 2⅛" 2.8cl 1oz
CTN QTY 12 €5.53
SAUCE DISH
WH SD4 1 11cl 4oz H: 5cm Dia: 8.5cm CTN QTY 24 €5.22
SAUCE DISH
WH SD3 1 9cl 3oz H: 4cm Dia: 8cm
CTN QTY 24 €4.80
PEBBLE PLANT POT
BCPEPL4 1 6.7 x 6.9cm 2¾" x 2 " 11.4cl 4oz
CTN QTY 12 €6.20
PEBBLE PLANT POT
BCPEPL2 1 5.5 x 5.8cm
2¼" x 2¼" 5.7cl 2oz
CTN QTY 12 €4.62
PEBBLE DIP DISH
BCPEPL5 1 3.5 x 9.7cm 3⅞" x 1½" 14.2cl 5oz
CTN QTY 12 €4.80
MINI
PAPRIKA PLANT POT
BCPAPL171 10.4 x 10.9cm 41 8 x 4¼" 48.3cl 17oz
CTN QTY 6 €9.63 BCPAPL121 9 x 9.7cm 2⅞" x 3½" 34cl 12oz
CTN QTY 12 €6.99
PAPRIKA PLANT POT
BCPAPL4 1 6.7 x 6.9cm 2¾" x 25 8 " 11.4cl 4oz
CTN QTY 12 €6.20
WHITE HANDLED PADDLE

WH PDLH1 28.4cm 11⅛"
CTN QTY 6 €16.76
PAPRIKA PLANT POT

BCPAPL2 1 5.5 x 5.8cm 2¼" x 2¼" 5.7cl 2oz
CTN QTY 12 €4.62
PAPRIKA DIP DISH
BCPAPL5 1 3.5 x 9.7cm 3⅞" x 1½" 14.2cl 5oz
CTN QTY 12 €4.80
PEBBLE PLANT POT


BCPEPL171 10.4 x 10.9cm 41 8" x 4¼" 48.3cl 17oz
CTN QTY 6 €9.63
BCPEPL121 9 x 9.7cm 2⅞" x 3½" 34cl 12oz
CTN QTY 12 €6.99
Cookware is an attractive oven-to-tableware range that combines vital performance with contemporary understated design. Featuring a high thermal shock resistance to reduce breakages, Cookware offers excellent heat retention properties and is oven, microwave and dishwasher safe.


RECTANGULAR DISH
WHCWLASN1 16 x 12 x 5cm 6⅜" x 4¾" x 2" 60cl 21.1oz
CTN QTY 12 €13.58
RECTANGULAR DISH
BCBKLASN1 16 x 12 x 5cm 6⅜" x 4¾" x 2" 60cl 21.1oz
CTN QTY 12 €13.58
SHALLOW
RECTANGULAR DISH
WHCWSASN1 15.5 x 11.5 x 4cm 6⅛" x 4½" x 1½" 40cl 14oz
CTN QTY 12 €12.31
SQUARE PIE DISH
WHCWSPDN1 12 x 12 x 5cm 4¾" x 4¾" x 2" 45cl 15.8oz
CTN QTY 12 €12.31



BCBKSPDN1 12 x 12 x 5cm 4¾" x 4¾" x 2" 45cl 15.8oz
CTN QTY 12 €12.31
ROUND PIE DISH
WHCWRPDN1 13.5cm x 5cm 5¼" x 2" 50cl 17.6oz CTN QTY 12 €11.58



ROUND PIE DISH
BCBKRPDN1 13.5 x 5cm 5¼" x 2" 50cl 17.6oz

CTN QTY 12 €11.58
OVAL PIE DISH
WHCWOPDN1 15.2 x 11.3 x 5cm 6" x 4¾" x 2" 45cl 15.8oz
CTN QTY 12 €12.79
OVAL PIE DISH



BCBKOPDN1 15.2 x 11.3 x 5cm 6" x 4¾" x 2" 45cl 15.8oz
CTN QTY 12 €12.79
OVAL EARED DISH

WHCWLOEN1 34.5 x 19cm 13½" x 7½" 109cl 38oz

CTN QTY 6 €39.68
WHCWMOEN1 28 x 15.6cm 11" x 6⅛" 78cl 27.5oz
QTY 6 €22.22
SMALL
Counter Serve is an innovative product, designed to offer the perfect solution for all hot and cold counter service, with flexible layout and a clean white body. Counter Serve provides consistent presentation, improving the look of food display.



RECTANGULAR BAKING TRAY

WHCWRSBD1 12 x 25 x 6.2cm 5" x 10" x 2½" 1ltr 35oz


CTN QTY 4 €36.91
SQUARE DISH
WHCWSBD 1 25 x 25 x 6.2cm 10" x 10" x 2½" 2ltr 70.4oz
CTN QTY 6 €41.42
RECTANGULAR TRAY
WHCWRLBD1 38 x 25 x 6.2cm 15" x 10" x 2½" 3.5ltr 123.2oz
CTN QTY 4 €64.56
RECTANGULAR TRAY
WHCWXLBD1 53 x 32.5 x 6.2cm 21" x 13" x 2½" 6ltr 211.8oz


CTN QTY 2 €129.34
RECTANGULAR TRAY

WHCWLBD 1 53 x 16 x 6.2cm 21" x 6½" x 2½" 3ltr 105.6oz

CTN QTY 2 €90.54
2/4 FLAT TRAY
WHCWSLBD1 53 x 15 x 2.5cm 21" x 6" x 1" 1.4ltr 50oz
CTN QTY 4 €77.60
WHCWRCDL1 34 x 20 x 11.5cm 13⅜" x 7⅞" x 4½" 4ltr 140.8oz
CTN QTY 2 €88.20
SMALL DISH
WHCWRCD 1 18 x 19.4 x 11.5cm 7" x 6½" x 4½" 2ltr 70.4oz
CTN QTY 4 €49.27
SHALLOW DISH*
WHCWSCD 1 17.5 x 18.5 x 8.5cm 6⅞" x 7⅜" x 3⅜" 1.6ltr 56oz
CTN QTY 4 €43.65
SQUARE JUG

WHCWSQJ 1 18 x 12cm 7" x 4½" 1.5ltr 52.8oz
CTN QTY 2 €38.59
POLYCARBONATE
SQUARE JUG LID
WHCWSQJL1 11cm 4⅜"
CTN QTY 6 €6.67
Stonecast brings rustic charm to hot counter presentation, hand decorated in the UK with a fine speckle and rustic edge band making each piece unique. Timeless hot or cold counter dishes decorated in Stonecast Hints, Barley White and Indigo Blue are designed to enhance food presentation with a hint of colour.

SHBISBD 1 25 x 25 x 6.2cm 10 x 10 x 2½ 1ltr 70.4oz
CTN QTY 6 €47.12
RECTANGULAR DISH
SHBIRLBD1 38 x 25 x 6.2cm 15 x 10 x 2½ 3.5ltr 123.2oz
CTN QTY 4 €78.54
RECTANGULAR DISH
SHBIXLBD1 53 x 32.5 x 6.2cm 21 x 13 x 2½ 6ltr 211.8oz
CTN QTY 2 €157.05
RECTANGULAR DISH
SHBILBD 1 53 x 16 x 6.2cm 21 x 6½ x 2½ 3ltr 105.6oz
CTN QTY 2 €108.52
SMALL DISH
SHBIRCD 1 18 x 19.4 x 11.5cm 7" x 6½" x 4½" 2ltr 70.4oz
CTN QTY 4 €55.68
SHWHSBD 1 25 x 25 x 6.2cm 10" x 10" x 2½" 1ltr 70.4oz
CTN QTY 6 €47.12
RECTANGULAR DISH
SHWHRLBD1 38 x 25 x 6.2cm 15" x 10" x 2½" 3.5ltr 123.2oz
CTN QTY 4 €78.54
SHBISLBD1 53 x 15 x 2.5cm 21" x 6" x 1" 1.4ltr 50oz
CTN QTY 4 €92.82
RECTANGULAR DISH
SHWHLBD 1 53 x 16 x 6.2cm
21" x 6½" x 2½"
3ltr 105.6oz
CTN QTY 2 €108.52
SMALL DISH
SHWHRCD 1 18 x 19.4 x 11.5cm 7" x 6½" x 4½" 2ltr 70.4oz
CTN QTY 4 €55.68
SHWHXLBD1 53 x 32.5 x 6.2cm 21" x 13" x 2½" 6ltr 211.8oz
CTN QTY 2 €157.05



SHWHSLBD1 53 x 15 x 2.5cm 21” x 6" x 1” 1.4ltr 50oz
CTN QTY 4 €92.82
An innovative range developed to be the ultimate flexible food presentation solution. The “one size fits all plate” is specifically designed to hold the diverse range of cups and dishes.

WH TSP 1 24.4cm 9½"
CTN QTY 6 €20.98
SOUP BOWL
WH SB 1 13cm 5¼" 54cl 19oz
CTN QTY 6 €10.28
WH SMB 1 12cm 4¾" 44cl 16oz
CTN QTY 6 €8.94
SMALL SOUP BOWL

WH SSB 1 11cm 4⅜" 28cl 10oz CTN QTY 24 €7.91
RICE BOWL
WH RB451 11.5cm 4½" 28cl 10oz CTN QTY 24 €8.20
CAFÉ CUP
WH MCLL1 44cl 16oz
CTN QTY 6 €9.27
WH CCLL1 22.4cl 8oz
CTN QTY 24 €6.66
WH CCL 1 11cl 4oz
CTN QTY 24 €5.18
ELEGANT MUG
STACKING MUG
CAPPUCCINO CUP
WH CB441 50cl 17.5oz CTN QTY 6 €10.07 WH CB281 34cl 12oz CTN QTY 24 €7.91 WH CB201 22.7cl 8oz CTN QTY 24 €6.32
ONE CUP TEAPOT

WH OCT 1 36.2cl 13oz CTN QTY 4 €25.40
CAPPUCCINO CUP WH CB281 34cl 12oz CTN QTY 24 €7.91



REPLACEMENT TEAPOT LID
WH OCTL1 CTN QTY 6 €9.56
SAUCE DISH
WH SD4 1 11cl 4oz H: 5cm Dia: 8.5cm CTN QTY 24 €5.52 WH SD3 1 9cl 3oz H: 4cm Dia: 8cm CTN QTY 24 €4.80
SAUCE DISH
WH SD2 1 5.68cl 2oz H: 2.7cm Dia: 8cm CTN QTY 24 €4.10

DIPPER POT/ BUTTER PAD
WH DP 1 4.5cl 1.5oz H: 4cm Dia: 5.5cm CTN QTY 24 €4.00
ECLIPSE DISH
WHVYED 1 18.5cm 7 " 22.4cl 8oz CTN QTY 12 €14.28
ODYSSEY SALT
WHVYOS 1 8.75cm 3½" CTN QTY 6 €10.07
ODYSSEY PEPPER WHVYOP 1 8.75cm 3½" CTN QTY 6 €10.07

super vitrified

Reminiscent of artisan pottery, Monochrome is hand dipped in three reactive coloured glazes. Create a rustic look with a coloured saucer or a contemporary look with a white saucer.



SAPPHIRE BLUE
CAPPUCCINO CUP
MOBLCB281 34cl 12oz H: 6.5cm Dia: 11cm
CTN QTY 12 €8.97
MOBLCB201 22.7cl 8oz H: 5.5cm Dia: 9.5cm
CTN QTY 12 €7.34
CINNAMON BROWN CAPPUCCINO CUP

MOBRCB281 34cl 12oz
H: 6.5cm
Dia: 11cm
CTN QTY 12 €8.97
MOBRCB201 22.7cl 8oz
H: 5.5cm Dia: 9.5cm
CTN QTY 12 €7.34
ONYX BLACK CAPPUCCINO CUP


MOBKCB281 34cl 12oz
H: 6.5cm
Dia: 11cm
CTN QTY 12 €8.97
MOBKCB201 22.7cl 8oz
H: 5.5cm
Dia: 9.5cm
CTN QTY 12 €7.34
MOMBCSS 1 15.6cm 6¼"
CTN QTY 12 €6.48
(Fits MOBLCB281, MOBRCB281, MOBKCB281, MOBLCB201, MOBRCB201, MOBKCB201, MOBLVM121, MOBRVM121 & MOBKVM121)
MOVCCSS 1 15.6cm 6¼"
CTN QTY 12 €6.48
(Fits MOBLCB281, MOBRCB281, MOBKCB281, MOBLCB201, MOBRCB201, MOBKCB201, MOBLVM121, MOBRVM121 & MOBKVM121)
MOIBCSS 1 15.6cm 6¼"
CTN QTY 12 €6.48 (Fits MOBLCB281, MOBRCB281, MOBKCB281, MOBLCB201, MOBRCB201, MOBKCB201, MOBLVM121, MOBRVM121 & MOBKVM121)




WH CSS 1 15.6cm 6¼"
CTN QTY 24 €4.56
(Fits MOBLCB281, MOBRCB281, MOBKCB281, MOBLCB201, MOBRCB201, MOBKCB201, MOBLVM121, MOBRVM121 & MOBKVM121)
Price
SAPPHIRE BLUE MUG
CINNAMON BROWN MUG
ONYX BLACK MUG
SAPPHIRE BLUE BOWL
MOBLRBL61 13.2 x 6.3cm 5⅛" x 2½" 47cl 16oz CTN QTY 12 €12.43
CINNAMON BROWN BOWL
MOBRRBL61 13.2 x 6.3cm 5⅛" x 2½" 47cl 16oz CTN QTY 12 €12.43
ONYX BLACK BOWL
MOBKRBL61 13.2 x 6.3cm 5⅛" x 2½" 47cl 16oz CTN QTY 12 €12.43
SAPPHIRE BLUE BEVERAGE POT
MOBLSB151 42.6cl 15oz H: 10.5cm CTN QTY 4 €32.59
REPLACEMENT LID WH RL151
CTN QTY 6 €10.11
CINNAMON BROWN BEVERAGE POT MOBRSB151 42.6cl 15oz H: 10.5cm CTN QTY 4 €32.59
REPLACEMENT LID WH RL151 CTN QTY 6 €10.11
ONYX BLACK BEVERAGE POT
MOBKSB151 42.6cl 15oz H: 10.5cm CTN QTY 4 €32.59
REPLACEMENT LID WH RL151 CTN QTY 6 €10.11
SAPPHIRE BLUE JUG MOBLSJ4 1 11.4cl 4oz H: 7cm CTN QTY 4 €14.48
CINNAMON BROWN JUG MOBRSJ4 1 11.4cl 4oz H: 7cm CTN QTY 4 €14.48
ONYX BLACK JUG MOBKSJ4 1 11.4cl 4oz H: 7cm CTN QTY 4 €14.48
SAPPHIRE BLUE SUGAR BOWL MOBLSSGR1 22.7cl 8oz H: 6.2cm Dia: 9.8cm CTN QTY 12 €7.54

CINNAMON BROWN SUGAR BOWL MOBRSSGR1 22.7cl 8oz H: 6.2cm Dia: 9.8cm CTN QTY 12 €7.54

ONYX BLACK JUG SUGAR BOWL MOBKSSGR1 22.7cl 8oz H: 6.2cm Dia: 9.8cm CTN QTY 12 €7.54

The Ultimate Choice
Price shown is price per piece
Ultimo is a contemporary beverage solution, exclusively designed by coffee connoisseurs. The range offers a selection of desirable cups and mugs, statement beverage pots, stylish jugs and bowls which truly enhance the coffee experience. The curved interior base of the cups creates the perfect ‘crema’.
CAFÉ LATTE CUP
WH BC141 40cl 14oz H: 8cm Dia: 11.5cm CTN QTY 12 €8.98
CAFÉ LATTE CUP
WH BC101 28.4cl 10oz H: 7cm Dia: 10.5cm CTN QTY 24 €7.89
CAFÉ AMERICANO CUP
WH BCA81 22.7cl 8oz H: 6cm Dia: 10cm CTN QTY 24 €7.11
CAPPUCCINO CUP

WH BCC61 18.4cl 6oz H: 5.5cm Dia: 9.5cm CTN QTY 24 €6.28
LARGE COUPE SAUCER
WH BS6 1 16cm 6¼" CTN QTY 24 €4.35 (Fits WH BL181, WH BC141, WH BC101, WH BCA81 and WH BCC61)
ESPRESSO CUP
WH BEC21 7cl 2.5oz H: 6.5cm Dia: 5cm CTN QTY 24 €5.42
SMALL COUPE SAUCER





WH BS4 1 12cm 4¾" CTN QTY 24 €3.53 (Fits WH BEC31, WH BEC21)
BEVERAGE POT
WH BT301 85.2cl 30oz H: 16cm CTN QTY 4 €34.05
BEVERAGE POT REPLACEMENT LID WH UL301 CTN QTY 6 €9.56
BEVERAGE POT



WH BT151 42.6cl 15oz H: 13.5cm
CTN QTY 4 €25.88
BEVERAGE POT REPLACEMENT LID WH UL151 CTN QTY 6 €9.56


JUG
WH BJ5 1 14.2cl 5oz H: 6cm CTN QTY 4 €11.04
JUG
WH B25 1 7cl 2.5oz H: 5cm CTN QTY 12 €9.53
ULTIMO • CHURCHILL SUPER VITRIFIED
Designed to withstand the rigors of the hospitality industry, Cafe and Latte are popular and timeless beverage collections. Available in a variety of key sizes, perfect for serving all manner of hot drinks. Price



CAPPUCCINO CUP
WH CB441 50cl 17.5oz
H: 7cm Dia: 11.5cm
CTN QTY 6 €10.07 WH CB401 46cl 16oz H: 7cm Dia: 11cm CTN QTY 6 €9.03
CAPPUCCINO CUP
WH CB281 34cl 12oz
H: 6.5cm Dia: 11cm
CTN QTY 24 €7.91
CAPPUCCINO CUP
WH CB111 28cl 10oz H: 6cm
Dia: 11cm
CTN QTY 12 €7.11
WH CB201 22.7cl 8oz H: 5.5cm Dia: 9.5cm CTN QTY 24 €6.32
WH CB061 17cl 6oz
H: 5.5cm Dia: 9cm
CTN QTY 12 €5.88
SAUCER
WH CSS 1 15.6cm 6¼"
CTN QTY 24 €4.56 (Fits WH CB441, WH CB401, WH CB281, WH CB201, WH CB111 & WH CB061)
ESPRESSO CUP
WH CEB91 10cl 3.5oz
H: 5.5cm
Dia: 6.5cm
CTN QTY 24 €5.37
ESPRESSO SAUCER
WH ESS 1 11.8cm 4½"
CTN QTY 24 €3.66 (Fits WH CEB91)
NOVA TEAPOT


WH T75 1 42cl 15oz H: 8cm
CTN QTY 4 €28.42
REPLACEMENT LID WH T75L1





CTN QTY 6 €11.39
CAFÉ LATTE MUG
WH MCLL1 44cl 16oz H: 11cm Dia: 10.5cm CTN QTY 6 €9.27
WH MCLM1 40cl 14oz H: 11cm Dia: 10cm CTN QTY 6 €8.04
CAFÉ LATTE MUG



WH MCL 1 34cl 12oz H: 11cm Dia: 9cm CTN QTY 12 €7.87
LARGE CAFÉ SAUCER
QTY 24 €3.96 (Fits WH MCLL1, WH MCLM1 & WH MCL1 )
CAFÉ
Compact is a comprehensive stacking beverage system that provides a fresh and practical solution for modern beverage service. The range offers outstanding functionality combined with a stylish retro design.
STACKING CUP
WH FTC71 21.3cl 7.5oz H: 6.2cm Dia: 8cm CTN QTY 24 €6.18
STACKING CUP
WH FT101 28.4cl 10oz H: 8cm Dia: 8cm CTN QTY 24 €7.73
SAUCER
WH FS6 1 15.2cm 6" CTN QTY 24 €4.16 (Fits WH FTC71 & WH FT101)
JUG
WH FJ101 28.4cl 10oz H: 8.7cm CTN QTY 4 €14.72
BEVERAGE POT WH FT151 42.6cl 15oz H: 11.7cm CTN QTY 4 €27.82




BEVERAGE POT REPLACEMENT LID WH FL151 CTN QTY 6 €11.48


SALT
WH FSP 1 6.5cm 2½" CTN QTY 12 €11.46
PEPPER
WH FPP 1 6.5cm 2½" CTN QTY 12 €11.46
Perfect solutions to complement flatware
Add value to any beverage service with this comprehensive collection of White Holloware. Product performance is key with an excellent choice of shape and capacity.



MAPLE BREAKFAST CUP
WH CBM 1 28cl 10oz H: 6.8cm Dia: 8.6cm CTN QTY 24 €7.11
MAPLE TEA CUP

WH COL 1 19.6cl 7oz H: 6.5cm Dia: 7.5cm CTN QTY 24 €5.23

WINDSOR MUG
WH VMW 1 28cl 10oz H: 9.5cm Dia: 7.8cm CTN QTY 36 €5.00
NOVA MUG
WH MB 1 22.4cl 8oz H: 8.6cm Dia: 7.8cm CTN QTY 24 €7.62
SAUCER
WH TSOL1 15cm 5⅞"
CTN QTY 24 €4.22 (Fits with WH CBM 1, WH COL 1, WH VMW 1, WH MB 1)
NOVA TEA CUP
WH CN 1 21cl 7.5oz H: 7cm Dia: 8.2cm CTN QTY 24 €5.23
ELEGANT MUG



WH ME 1 28cl 10oz
H: 9.6cm Dia: 8.2cm CTN QTY 24 €8.04
WHITE HOLLOWARE
SAUCER

WH TS 1 14cm 5½"
CTN QTY 24 €4.22 (Fits WH CN 1, WH ME 1)
Price shown is price per piece
STACKING MUG
WH MSS 1 28cl 10oz
H: 9.5cm Dia: 7.5cm
CTN QTY 24 €7.84
NOVA MUG
WH M50 1 28cl 10oz H: 8cm Dia: 8.2cm
CTN QTY 24 €8.42
BUBBLE CUP
WH SC121 34cl 12oz H: 8.5cm Dia: 8.5cm
CTN QTY 12 €8.50
SAUCER

WH BS6 1 16cm 6¼
CTN QTY 24 €4.35 (Fits WH SC121)
SANDRINGHAM TEA/ COFFEE POT
WH PS301 85.2cl 30oz H: 17.5cm
CTN QTY 4 €36.65
SANDRINGHAM REPLACEMENT LID
WH LS301
CTN QTY 6 €11.48
SANDRINGHAM TEA/ COFFEE POT




WH PS151 42cl 15oz H: 14.5cm
CTN QTY 4 €28.42
SANDRINGHAM REPLACEMENT LID
WH LS151
CTN QTY 6 €11.48
CAFÉ TEAPOT
WH CT121 34cl 12oz H: 12cm
CTN QTY 4 €24.62
CAFE TEAPOT LID
WH CTL 1
CTN QTY 6 €9.56
ONE CUP TEAPOT
WH OCT 1 36.2cl 13oz H: 10cm
CTN QTY 4 €25.40
ONE CUP TEAPOT REPLACEMENT LID
WH OCTL1
CTN QTY 6 €9.56
CAPPUCCINO CUP
COUNTER-SERVE SQUARE JUG

WHCWSQJ 1 1.5ltr 52.8oz 18 x 12cm
CTN QTY 2 €38.59
POLYCARBONATE SQUARE JUG LID

WHCWSQJL1 11cm 4⅜"
CTN QTY 6 €6.67
BIT ON THE SIDE JUG
WH BOJM1 34cl 12oz H:12cm Dia: 8.5cm
CTN QTY 4 €20.41
BIT ON THE SIDE JUG
WH BOJS1 8.5cl 3oz H: 8cm Dia: 7cm
CTN QTY 4 €14.47
SANDRINGHAM JUG/ CREAMER
WH JS1 1 56cl 20oz H: 15cm
CTN QTY 4 €19.68
SANDRINGHAM JUG/ CREAMER
WH JS501 28cl 10oz H: 12cm
CTN QTY 4 €15.54
SANDRINGHAM JUG/ CREAMER



WH JS251 14cl 5oz H: 10cm CTN QTY 4 €11.71
SANDRINGHAM/ NOVA SUGAR BOWL
WH B35 1 25.6cl 9oz 9cm 3½"
CTN QTY 12 €6.28
SUGAR BOWL LID
WH LS 1
CTN QTY 6 €10.49
SACHET SUGAR PACKET HOLDER
WH SH 1 11.7cm x 7.3cm 4⅝" x 2⅞"
CTN QTY 6 €18.31
BIT ON THE SIDE DIP POT
WH BODP1 5.7cl 2oz 5.5cm 2⅛"
CTN QTY 24 €4.66
* Polycarbonate lids are not available in France
MEDITERRANEAN UNHANDLED JUG
WH MJ 1 9cl 3oz CTN QTY 24 €10.62
MEDITERRANEAN
UNHANDLED JUG
WH MJ2 1 5.7cl 2oz CTN QTY 24 €10.62
WH CB281 34cl 12oz H: 6.5cm Dia: 11cm CTN QTY 24 €7.91 WHITE HOLLOWARE







An exciting tabletop personality that deliver style, individuality and great value to professional caterers. Tableware that bends to fit your needs. Art de Cuisine offers answers without compromise.

Una vajilla con personalidad que entrega estilo, individualidad y un precio competitivo a los profesionales de la hostelería.
Das vielseitige Art de Cuisine-Sortiment bietet Stil ohne Kompromisse und ist für das anspruchsvolle Gastgewerbe konzipiert.
Il piacere dell’ originalità Una grande personalità per dare stile, individualità e grande valore ai professionisti del catering.

Sembler différent que tout le
Les vaiselles innovantes qui offrent le style individu et le bon marché.
















COUPE PLATE
ZCCWMC291 29cm 11¼" CTN QTY 6 €16.61

COUPE PLATE
COUPE PLATE
ZCCWMC201 20.5cm 8¼" CTN QTY 6 €9.43 ZCCWMC161 15.5cm 6⅛" CTN QTY 6 €7.21
COUPE BOWL
LARGE
RECTANGULAR PLATE
ZCCWNRPL1 35.5 x 19cm 14" x 7½" CTN QTY 6 €39.27
MEDIUM RECTANGULAR PLATE ZCCWNRPM1 35.5 x 14.2cm 14" x 5½" CTN QTY 6 €30.60
BOWL ZCCWWB6 1 16cm 6¼" 48cl 17oz CTN QTY 6 €11.86
BOWL ZCCWWB5 1 13.4cm 5¼" 34cl 12oz CTN QTY 6 €10.42









































Menu Porcelain collection blends classic and contemporary styles. The vitrified porcelain offers a brilliant white finish, designed with functionality in mind across a full and varied range of plates, bowls, accessories and beverage.





























MID RIM PLATE
ZCA
MID RIM PLATE
ZCA PO101 25.4cm 10" CTN QTY 6 €7.25


ZCA PO9 1 22.8cm 9" CTN QTY 6 €6.37

MID RIM PLATE
ZCA PO8 1 20.3cm 8" CTN QTY 6 €5.25
ZCA PO6 1 17.1cm 6¾" CTN QTY 6 €3.97
COUPE PLATE
ZCAPMC311 31cm 12¼"
CTN QTY 6 €22.28
ZCAPMC271 27cm 10⅝" CTN QTY 6 €10.28
COUPE PLATE
BROAD
ZCA PO121 30.5cm 12" CTN QTY 6 €18.15

SQUARE PLATE
ZCAPSQPL1 30cm 11¾" CTN QTY 6 €19.70









SQUARE PLATE



ZCAPSQPS1 17.5cm 6⅞" CTN QTY 6 €7.36
LARGE
ZCAPRCPL1
MEDIUM
MEDIUM
ZCAPNRPM1
SMALL
BROAD
LARGE RECTANGULAR PLATE






ZCAPNRPL1 35.5 x 19cm 14" x 7½" CTN QTY 6 €31.19
MID
ZCA POMP1 29.2cm 11½" 56.8cl 20oz CTN QTY 6 €19.70

Price shown is price per piece
MID RIM SOUP BOWL
ZCA POMS1 22.8cm 9" 28cl 10oz
CTN QTY 6 €8.36
MID RIM BOWL
ZCA POMO1 16.5cm 6¼" 19.9cl 7oz CTN QTY 6 €6.37


LARGE SLANTED BOWL



ZCA SLBL1 21.5 x 9.8cm 8½" x 3⅞" 80cl 28oz
CTN QTY 6 €19.82
MEDIUM SLANTED BOWL









ZCA SLBM1 17.5 x 8.1cm 6⅞" x 3⅛" 40cl 14oz
CTN QTY 6 €13.60
BOWL
ZCAPWB6 1 16cm 6¼" 48cl 17oz
CTN QTY 6 €9.92
BOWL
ZCAPWB5 1 13.4cm 5¼" 34cl 12oz
CTN QTY 6 €8.49
STACKING CUP
ZCA POST1 21cl 7.5oz H: 7.1cm Dia: 7.1cm
CTN QTY 6 €3.62
SOUP CUP
ZCA POSC1 28cl 10oz H: 6cm Dia: 10cm
CTN QTY 6 €5.68
FLARED TEA CUP
ZCA POTC1 23cl 8oz H: 8cm Dia: 9cm
CTN QTY 6 €5.68
BROAD RIM TEA SAUCER
ZCA POS61 16.5cm 6½"
CTN QTY 6 €4.26 (Fits ZCA POST1, ZCA POSC1 & ZCA POTC1)
CAPPUCCINO CUP
ZCA C12 1 34.1cl 12oz H: 6.5cm Dia: 10.5cm CTN QTY 6 €7.36
CAPPUCCINO CUP
ZCA PC7 1 19.9cl 7oz H: 6.5cm Dia: 9cm CTN QTY 6 €5.38
SAUCER
ZCA POSM1 15.5cm 6⅛"
CTN QTY 6 €4.26 (Fits ZCA C12 1 & ZCA PC7 1)
FLARED TEA CUP
ZCA POM21 34cl 12oz H: 9cm Dia: 10cm CTN QTY 6 €8.22
BROAD RIM TEA SAUCER
ZCA POS71 17.1cm 6¾" CTN QTY 6 €5.09 (Fits ZCA POM21)
ESPRESSO CUP







ZCA PEC31 8.5cl 3oz H: 5cm Dia: 7cm CTN QTY 6 €4.54
SMALL SAUCER


ZCA POSS1 12.7cm 5" CTN QTY 6 €3.40 (Fits ZCA PEC31)







FLARED MUG

ZCA POM 1 29.8cl 10.5oz H: 11cm Dia: 9cm CTN QTY 6 €7.67
ZCA POP11 42cl 15oz H: 12cm CTN QTY 4 €21.97 REPLACEMENT LID ZCA PL151 CTN QTY 6 €7.39










JUG
ZCA POJ51 14cl 5oz H: 8.5cm CTN QTY 4 €8.49
JUG ZCA POJ21 6cl 2oz H: 7cm CTN QTY 4 €5.68







OPEN SUGAR
ZCA POSU1 8.5cl 3oz H: 5cm Dia: 7cm CTN QTY 6 €3.97
PRESENTATION PAN
ZCAPPP5 1 13.4cm 5¼" 34cl 12oz CTN QTY 6 €22.64
PRESENTATION PAN
ZCAPPP4 1 11.8cm 4¼" 23cl 8oz CTN QTY 6 €17.02
MINI SAUCE PAN

ZCAPMS4 1 8 x 4.5cm 3" x 1¾" 11cl 4oz CTN QTY 6 €11.32

A
Introducing Future Care, a range of specialist ceramics designed to assist independence and support wellbeing. The collection features individual pieces ergonomically designed for the health care market, suitable for care homes, hospitals, retirement homes and care villages. Future Care is a classic range tailored for individual personal needs and enhances food presentation.
A stylish and functional white porcelain collection that delivers on durability and practicality.
Designed with the needs of the ageing population in mind. Future care provides additional grip, stability and food control, providing greater independence for the individual.
All items have a wide stackable base for storage and to maximize stability.
The plate is designed to have full contact with a heated tray, retaining heat and keeping food hot for longer.

Future Care can be complemented with Art de Cuisine Menu to provide a full tabletop solution.
All items have been designed to fit easily into a dishwasher.
have been designed for the Future Care range. Care industry experts have identified that


is more visible against the contrast of blue tableware, improving food intake and nutrition. Future Care tableware is the natural choice for assisted living.














Rustic texture in bold, striking colours. Available across 4 contemporary colours, Rustics Snug Mugs are statement pieces for the tabletop.

WHITE SNUG MUG

ZCASMGWH1 35.5cl 12oz H: 8cm Dia: 10cm CTN QTY 6 €8.44
GREEN SNUG MUG

ZCASMGGR1 35.5cl 12oz H: 8cm Dia: 10cm CTN QTY 6 €8.44
RED SNUG MUG

ZCASMGRD1 35.5cl 12oz H: 8cm Dia: 10cm CTN QTY 6 €8.44
BLACK SNUG MUG
ZCASMGBK1 35.5cl 12oz H: 8cm Dia: 10cm CTN QTY 6 €8.44

















































PLATE
ZCATIG131 33cm 13"
CTN QTY 6 €22.13
PLATE
ZCATIG111 28cm 11" CTN QTY 6 €16.20

ZCATIGP91 23cm 9" CTN QTY 6 €11.75
SIDE PLATE
ZCATIGP71 18cm 7" CTN QTY 6 €9.88
OVAL PLATE
ZCATIG141 35.5 x 26.5cm 14" x 10½"



































CTN QTY 6 €26.60
OVAL PLATE




























ZCATIG121 32cm 12½"
CTN QTY 6 €20.66
SQUARE PLATE
ZCATIG301 30 x 30cm 11¾" x 11¾" CTN QTY 6 €38.20



SQUARE PLATE
ZCATIG271 27 x 27cm 10¾" x 10¾" CTN QTY 6 €24.63

SQUARE PLATE
ZCATIG211 21 x 21cm 8¼" x 8¼" CTN QTY 6 €18.50
RECTANGULAR PLATE
ZCATIG351 35 x 18cm 13⅞" x 7⅛" CTN QTY 6 €39.41
RECTANGULAR PLATE
ZCATIG291 29 x 15cm 11⅜" x 5⅞" CTN QTY 6 €29.21
RECTANGULAR PLATE
ZCATIG151 15 x 10cm 5⅞" x 3⅞" CTN QTY 6 €13.49
RECTANGULAR DISH
ZCATIGRD1 17 x 13cm 6¾" x 5⅛" 48.3cl 17oz CTN QTY 6 €16.20







INDIVIDUAL DISH
ZCATIGI 1 14cm 5½" 28.4cl 10oz CTN QTY 6 €10.25

INDIVIDUAL DISH
ZCATIGID1 12cm 4¾" 19cl 6.6oz CTN QTY 6 €8.75
LARGE DISH
ZCATIGLP1 16cm 6¼" 55cl 19.3oz CTN QTY 6 €14.71




SMALL DISH
ZCATIGSP1 14cm 5½" 40cl 14oz CTN QTY 6 €11.75





Create the ultimate food display using versatile buffet pieces in ceramic, wood and melamine. Designed to work together, Churchill’s mixed material buffet solutions can create a variety of looks, from classical and elegant hotel breakfast buffet, to a rustic market fresh style lunch feast or sleek, urban corporate meeting breakout.

Price shown
Create eye-catching buffet displays with Alchemy buffet trays. A stylish, modular and versatile concept, available in a mix of melamine colours, white and hand decorated ceramic and acacia wood. The range is perfect for deli style buffet displays, working lunches and conference catering.

RECTANGULAR CERAMIC BUFFET TRAY
APRBART 1 30 x 14.5cm 11¾" x 5¾"
CTN QTY 6 €32.40
RECTANGULAR CERAMIC BUFFET TRAY
APRBART21 56 x 15.3cm 22" x 6"
CTN QTY 4 €79.79
RECTANGULAR CERAMIC BUFFET TRAY
APRBART31 53 x 32.5cm 20⅞" x 12¾"
CTN QTY 2 €122.58

RECTANGULAR CERAMIC BUFFET TRAY
APRBART41 46 x 10cm 18" x 3⅞"
CTN QTY 4 €68.87
RECTANGULAR CERAMIC BUFFET TRAY
APRBART51 58 x 20cm 22⅞" x 7⅞"
CTN QTY 4 €124.00
RECTANGULAR CERAMIC BUFFET TRAY
APRBART61 17 x 10cm 6¾" x 3⅞"
CTN QTY 6 €23.43
SQUARE CERAMIC BUFFET TRAY
APRBAST 1 30.3 x 30.3cm 11⅞" x 11⅞"
CTN QTY 4 €72.56
HINTS BARLEY WHITE
RECTANGULAR BUFFET TRAY
SHWHART 1 30 x 14.5cm 11¾" x 5¾" CTN QTY 6 €33.43
HINTS BARLEY WHITE SQUARE BUFFET TRAY



SHWHAST 1 30.3 x 30.3cm 11⅞" x 11⅞" CTN QTY 4 €74.92
HINTS INDIGO BLUE
RECTANGULAR BUFFET TRAY
SHBIART 1 30 x 14.5cm 11¾" x 5¾"
CTN QTY 6 €33.43
HINTS INDIGO BLUE
SQUARE BUFFET TRAY
SHBIAST 1 30.3 x 30.3cm 11⅞" x 11⅞"
CTN QTY 4 €74.92
Polycarbonate tray covers avaliable on page 326 - 327.
An extensive range of melamine shapes in a variety of colours and finishes, designed to work with the comprehensive Churchill range of ceramics and wood.
Versatile pieces work for all manner of food displays, from modular buffet trays to soft, organic shaped bowls, available in either gloss or matte finishes. Designed in house, all shapes are exclusive to Churchill and made with 100% food safe melamine.
Churchill melamine is stain resistant and dishwasher safe, vigorously tested to ensure it meets the demands of the hospitality environment.

Price shown is price per piece
RECTANGULAR GRANITE MELAMINE BUFFET TRAY
ZPL MRG21 56 x 15.3cm 22" x 6"
CTN QTY 4 €54.15
RECTANGULAR GRANITE MELAMINE BUFFET TRAY
ZPL MRG31 53 x 32.5cm 20⅞" x 12¾"
CTN QTY 2 €83.58
RECTANGULAR GRANITE MELAMINE BUFFET TRAY
ZPL MRTG1 30 x 14.5cm 11¾" x 5¾"
CTN QTY 6 €22.11
SQUARE GRANITE

MELAMINE BUFFET TRAY
ZPL MSTG1 30.3 x 30.3cm 11⅞" x 11⅞"
CTN QTY 4 €49.41
RECTANGULAR BLACK MELAMINE BUFFET TRAY
ZPL MRT21 56 x 15.3cm 22" x 6"
CTN QTY 4 €49.21
RECTANGULAR BLACK MELAMINE BUFFET TRAY
ZPL MRT31 53 x 32.5cm 20⅞" x 12¾"
CTN QTY 2 €75.98
RECTANGULAR BLACK MELAMINE BUFFET TRAY


ZPL MRT 1 30 x 14.5cm 11¾" x 5¾"
CTN QTY 6 €20.09
SQUARE BLACK
MELAMINE BUFFET TRAY
ZPL MST 1 30.3 x 30.3cm 11⅞" x 11⅞"
CTN QTY 4 €44.91
RECTANGULAR BUFFET COVER 56 x 15.3cm
ZPL PRT2 1
APRBART21
RECTANGULAR BUFFET COVER 53 x 32.5cm
ZPL PRT3 1
APRBART31
RECTANGULAR BUFFET COVER 30 x 14.5cm
ZPL PRT 1
SQUARE BUFFET COVER 30.3 x 30.3cm
ZPL PST 1
RECTANGULAR BUFFET COVER 46 x 10cm
ZPL PRT4 1
RECTANGULAR BUFFET COVER 58 x 20cm
ZPL PRT5 1
RECTANGULAR WHITE MELAMINE BUFFET TRAY
ZPL MRW21 56 x 15.3cm 22" x 6"
CTN QTY 4 €49.21
RECTANGULAR WHITE MELAMINE BUFFET TRAY
ZPL MRW31 53 x 32.5cm 20⅞" x 12¾"
CTN QTY 2 €75.98
RECTANGULAR WHITE MELAMINE BUFFET TRAY












ZPL MRTW1 30 x 14.5cm 11¾" x 5¾"
CTN QTY 6 €20.09
SQUARE WHITE MELAMINE BUFFET TRAY

ZPL MSTW1 30.3 x 30.3cm 11⅞" x 11⅞"
CTN QTY 4 €44.91
ZPL MRT21
ZPL MRG21
ZPL MRW21
ZPL MRT31 ZPL MRG31 ZPL MRW31
ZPL WGN11
ZPL BGN11
*Polycarbonate covers are not available in France.
APRBART 1 SHWHART 1 SHBIART 1 ZCAWWRT 1 ZPL MRT 1 ZPL MRTG1 ZPL MRTW1
APRBAST 1 SHWHAST 1 SHBIAST 1 ZPL MST 1 ZPL MSTG1 ZPL MSTW1
APRBART41 ZPL MRW41
APRBART51 ZPL MRW51
Polycarbonate Covers
RECTANGULAR BUFFET COVER
ZPL PRT21 56 x 15.3cm 22" x 6"
CTN QTY 2 €56.65
RECTANGULAR BUFFET COVER
ZPL PRT31 53 x 32.5cm 20⅞" x 12¾"
CTN QTY 2 €77.82
Polycarbonate covers are not avaliable in France.
RECTANGULAR BUFFET COVER
ZPL PRT 1 30 x 14.5cm 11¾" x 5 ¾"
CTN QTY 6 €33.37
SQUARE BUFFET COVER
ZPL PST 1 30.3 x 30.3cm 11⅞" x 11⅞"
CTN QTY 2 €44.45
RECTANGULAR WHITE
MELAMINE BUFFET TRAY
ZPL MRW41 46 x 10cm 18" x 3⅞"
CTN QTY 4 €34.56
RECTANGULAR WHITE
MELAMINE BUFFET TRAY
ZPL MRW51 58 x 20cm 22⅞" x 7⅞"
CTN QTY 4 €62.16
RECTANGULAR BUFFET COVER
ZPL PRT41 46 x 10cm 18" x 3⅞"
CTN QTY 2 €51.81

RECTANGULAR BUFFET COVER
ZPL PRT51 58 x 20cm 22⅞" x 7⅞"
CTN QTY 2 €75.54
DISTRESSED WOOD MELAMINE ROUND HANDLED PADDLE BOARD ZPL RPDW1 32 x 32cm 12½" x 12½"

CTN QTY 4 €37.49 (45cm 18" inc handle)
WHITE MELAMINE
GRANITE MELAMINE
LARGE HANDLED PADDLE BOARD
ZPL LPGR1 61 x 13cm 24" x 5"
CTN QTY 4 €38.21
*Size inc handle.
DISTRESSED WOOD MELAMINE
LARGE HANDLED PADDLE BOARD
ZPL LPWO1 61 x 13cm 24" x 5"
CTN QTY 4 €38.21
*Size inc handle.
BLACK GRANITE MELAMINE RECTANGULAR TILE







WHITE MELAMINE HANDLED PADDLE BOARD
ZPL HPW 1 26.6 x 14cm 10½" x 5½"
CTN QTY 4 €18.45 (37.3cm 14⅝" inc handle)
GRANITE MELAMINE
HANDLED PADDLE BOARD
ZPL HPG 1 26.6 x 14cm 10½" x 5½"
CTN QTY 4 €20.24 (37.3cm 14⅝" inc handle)
DISTRESSED WOOD MELAMINE HANDLED PADDLE BOARD
ZPL HPDW1 26.6 x 14cm 10½" x 5½"
CTN QTY 4 €20.24 (37.3cm 14⅝" inc handle)
WHITE MELAMINE TILT BUFFET BOWL ZPL SBWH1 33 x 15.5cm 13" x 6⅛" 350cl 123oz CTN QTY 2 €43.27
WHITE MELAMINE MOONSTONE BUFFET BOWL ZPL MBWH1 35.5 x 25 x 18cm 14" x 11" x 7⅛" 450cl 158oz CTN QTY 2 €43.27
WHITE MELAMINE MOONSTONE BUFFET BOWL ZPL WM251 25 x 19.5 x 12.4cm 9¾" x 7½" x 5" 129.85cl 45.75oz CTN QTY 4 €21.89
WHITE MELAMINE MOONSTONE BUFFET BOWL ZPL WM201 20 x 15.5 x 10cm 7¾" x 6" x 4" 59.95cl 21.1oz CTN QTY 4 €17.52











BARLEY WHITE RECTANGULAR BUFFET TRAY
ZPL STR31 53 x 32.5cm 20⅞" x 12¾" CTN QTY 2 €83.58
BARLEY WHITE RECTANGULAR BUFFET TRAY


ZPL STR21 53 x 16.2cm 22" x 6" CTN QTY 4 €54.15
BARLEY WHITE SQUARE BUFFET TRAY
ZPL STSQ1 30.3 x 30.3cm 11⅞" x 11⅞” CTN QTY 4 €49.41
BARLEY WHITE MOONSTONE BUFFET BOWL
ZPL STMB1 35.5 x 25 x 18cm 14" x 11" x 7⅛" 450cl 158oz CTN QTY 2 €47.58
BARLEY WHITE TRACE MELAMINE BOWL

ZPL STTB1 38cm 15" 460cl 161.8oz CTN QTY 2 €47.58

BARLEY WHITE MELAMINE ROUND HANDLED PADDLE BOARD

ZPL STRP1 32 x 32cm 12½" x 12½" CTN QTY 4 €37.49 (45cm 18" inc handle)

An extensive range of wooden pieces in a variety of shapes and finishes, from premium Alchemy Buffet Trays to a rustic natural finish.
All Churchill wood, from deli boards to buffet risers are designed to complement the Churchill ceramics portfolio.
At Churchill we only work in partnership with suppliers who share our policy on sustainability and environmental awareness, therefore our wood source is 100% renewable. Made from a

Bring height, colour and texture to buffet displays with Buffetscape wood. Organic and modular shapes in a selection of natural, rustic and graphite grey finishes enhance the beautiful colour and texture of acacia wood.




The items are designed to work together to create the ultimate visual food display.
LARGE WOODEN CRATE
ZCAWLWCR1 38 x 24 x 4.8cm 15" x 9½" x 1⅞" CTN QTY 4 €55.51
MEDIUM WOODEN CRATE
ZCAWMWCR1 30 x 20 x 4.8cm 11¾" x 7⅞" x 1⅞"
CTN QTY 4 €45.94
SMALL WOODEN CRATE
ZCAWSMCR1 30 x 11.8 x 4.8cm 11¾" x 4⅝" x 1⅞"
CTN QTY 4 €34.46
LARGE ORGANIC STAND
ZCAWLGST1 H: 14.5cm 5¾" Dia: 27.5cm 10⅞"
CTN QTY 4 €47.81
LARGE ROUND STAND


ZCAWLRST1 H: 15cm 5⅞" Dia: 25cm 9⅞"
CTN QTY 4 €47.81
SMALL ROUND STAND
ZCAWSRST1 H: 10cm 4" Dia: 15cm 6" CTN QTY 4 €34.58

LARGE ROUND PLANT POT

ZCAWLWPL1 H: 15cm 6" Dia: 27.5cm 10⅞" CTN QTY 4 €69.18
SMALL ROUND PLANT POT ZCAWSMPL1 H: 10cm 4" Dia: 19.8cm 7⅞" CTN QTY 4 €52.18
LARGE ORGANIC BOARD ZCAWOB1 1 45.5 x 14.5cm 18" x 5⅞" CTN QTY 4 €39.66 SMALL




LARGE RECTANGULAR STAND

LARGE NESTING RISER
ZCAWRLNC1 L: 44.5cm 17½" W: 25.8cm 10⅛" H: 23.5cm 9¼"
CTN QTY 1 €130.51
MEDIUM NESTING RISER
ZCAWRMNC1 L: 42.1cm 16⅝" W: 25.8cm 10⅛" H: 13.2cm 5¼"
CTN QTY 1 €105.56
SMALL NESTING RISER
ZCAWRSNC1 L: 39.7cm 15⅝" W: 25.8cm 10⅛" H: 5cm 2"
CTN QTY 1 €59.50
LARGE STACKING CRATE RISER
ZCAWLRCR1 L: 44.5cm 17½" W: 25.8cm 10 " H: 9.4cm 3¾"
CTN QTY 2 €69.72
SMALL STACKING CRATE RISER
ZCAWSSCR1 L: 25.8cm 10 " W: 22.15cm 8¾" H: 9.4cm 3¾"
CTN QTY 4 €46.45
ZCAWTBPP1 L: 44.5cm 17½" W: 13cm 5⅛" H: 3.9cm 1½"

CTN QTY 4 €41.23
SOLID BASE HANDLED TRAY
ZCAWSBHT1 39.7 x 25.8cm 15⅝" x 10"
CTN QTY 4 €51.40
BREAD BOARD INSERT
ZCAWBB1 1 37.3 x 23.4cm 14⅝" x 9⅛"
CTN QTY 4 €25.70 (Fits inside ZCAWSBHT1)
MEDIUM STEPPED PRESENTATION BOARD
ZCAWMRPB1 39.6 x 16cm 15½" x 6¼" CTN QTY 4 €37.77
SMALL STEPPED PRESENTATION BOARD ZCAWSRPB1 34.2 x 16cm 13½" x 6¼" CTN QTY 4 €31.20
ACACIA WOOD MEDIUM DOUBLE HANDLED BOARD




ZCAWDBH21 40 x 11.5cm 15 '' x 4 '' CTN QTY 4 €35.44
ACACIA

















LARGE
LARGE RECTANGULAR RISER ZCAWRRL 1 56 x 18 x 20cm 22" x 7⅛" x 7⅞" CTN QTY 2 €110.12

SMALL RECTANGULAR RISER ZCAWRRS 1 38 x 12 x 10cm 15" x 4¾" x 4" CTN QTY 2 €66.06 LARGE
LARGE SINGLE HANDLED WOODEN TRAY ZCAWIGT31 48 x 14cm 19" x 5½" CTN QTY 4 €42.48






MEDIUM SINGLE HANDLED WOODEN TRAY ZCAWIGT21 35.5 x 14cm 14" x 5½" CTN QTY 4 €35.44



RECTANGULAR CRATE ZCAWRCTC1 33 x 20 x 10cm 13" x 7⅞" x 4⅞" CTN QTY 4 €55.89
Exclusively designed in-house by our UK - based design team, Churchill cutlery has been specifically created for the hospitality environment with a focus on strength, comfort and style. Manufactured in high quality 18/10 stainless steel with a premium polished finish, Churchill cutlery meets the highest standards in durability and performance.
Fully stocked in our UK - based warehouse, with all the benefits of the Churchill continuity and service promise. Offering a variety of designs and styles, the range is ideal for both casual and premium settings, enhancing the dining experience and complementing the Churchill ceramics portfolio.











Climate change agreement - target set at 10% energy reduction per tonne of product produced
Our compressed air management system was installed
We introduced our first waste compactor
We introduced our environmental charter
40% of all UK products are now once fired
100% of waste now recycled - 0% to landfill *applicable to manufacturing waste
We give extensive consideration to the impact on the environment throughout our production processes and ensure that the best environmental option is always adopted.

Our new kiln reduces gas consumption by 22.5% per 12 items fired
In energy efficient lighting across the entire site
Internal team formed to audit business-wide processes in order to maximise energy efficiency and minimise environmental impact
100% of the electricity we use on our site comes from renewable sources
Our once firing technology was first introduced in 1980
Our fast fire tunnel kiln for Alchemy was introduced
We installed our fast fire eisenmann tunnel kiln for once fired cups
We first used eco glaze on all Super Vitrified Profile products
Achieved a 10% energy reduction target as set in 2000. New target for 2020 of a further 10% reduction
94% of all waste in 2012 was recycled
Our eco glaze is now used on all UK ceramic products
Waste clay reclamation machine installed - 50+ tonnes of clay reused and diverted from landfill in 2014
In two new energy efficient kilns, reducing gas consumption by 34%
Reduced reliance on fossil fuels by installing our first solar panels on site
Further investment in solar panels, generating enough electricity to run our new biscuit stock warehouse
Although glazing the feet of our ceramics adds complexity it increases functional benefits to the customer. Foot glazing requires ‘pin firing’. This prevents scratching to tables and plates when stacked.
Aunque esmaltar una pieza en su totalidad añade complejidad, esto aumenta los beneficios funcionales para el cliente. El esmaltado en la base de cada pieza requiere de un “pin-firing”. Esto evita que se rayen las mesas y platos cuando se apilan.
Obwohl das Glasieren der Füße unseres Geschirres die Komplexität erhöht, erhöht es den funktionellen Nutzen für den Kunden. Für eine FußGlasur ist das sogenannte “Pin-Firing” erforderlich. So wird das Zerkratzen von Tischen und Tellern beim Stapeln verhindert.
Sebbene la smaltatura dei piedi della nostra ceramica aggiunga complessità, accresce vantaggi funzionali per il cliente. La smaltatura dei piedi richiede una “cottura su punte”. In questo modo, si evitano i graffi sui tavoli e sui piatti quando vengono impilati.
Le procédé du talon émaillé est un réel avantage fonctionnel pour nos clients. Pour l’obtenir, l’assiette est laissée à sécher sur un trépied en bois. L’émail pulvérisé recouvre intégralement l’assiette sauf 3 petits points au dessous de l’assiette qui seront polis plus tard.
The technology used to form our products ensures consistency in size and weight allowing pieces to be stacked back of house using less space and reducing breakages. Breakages in ceramics are generally related to porosity or how much water a piece can absorb. Water absorption weakens the chemical structure affecting its durability over time. Through the process of vitrification, the particle structure of our ceramic body becomes strong, dense and watertight.
Our glaze is hard wearing and designed specifically for the hospitality environment. Sprayed glaze creates a smoother and more consistent finish.

La tecnología utilizada para formar nuestros productos asegura la consistencia en tamaño y peso permitiendo que las piezas se apilen eficientemente usando menos espacio y reduciendo las roturas.
Las roturas en la cerámica están generalmente relacionadas con la porosidad, o con la cantidad de agua que una pieza puede absorber. La absorción de agua debilita la estructura química afectando su durabilidad en el tiempo. A través del proceso de vitrificación, la estructura de partículas de nuestro cuerpo cerámico se vuelve fuerte, densa y hermética.
Die Ränder werden mit einem Schwamm bearbeitet, um eine runde, glatte Oberfläche zu erzeugen, die weniger anfällig für Absplitterungen ist.
La tecnologia impiegata per formare nostri prodotti garantisce omogeneita’ di peso e dimensioni, affinché possano essere impilati negli spazi di servizio con un minore ingombro e meno rotture.
Une technologie de pointe qui assure la régularité et une parfaite cohérence entre la taille, la forme et le poids du produit. Les espaces de stockage des professionnels sont optimisés.
Brüche in Keramik hängen im Allgemeinen mit der Porosität zusammen oder damit, wie viel Wasser ein Stück aufnehmen kann. Wasseraufnahme schwächt die chemische Struktur, was die Haltbarkeit im Laufe der Zeit beeinträchtigt.
Die Partikelstruktur unseres Keramischen Scherben wird durch den Vitrifizierungs Prozess robust, dicht und wasserundurchlässig.
Le rotture della ceramica dipendono in genere dalla porosità, cioè dalla quantità di acqua che un pezzo è in grado di assorbire. L’assorbimento di acqua indebolisce la struttura chimica, compromettendone la durata nel tempo. Mediante il processo di vetrificazione, la struttura delle partecicelle del nostro corpo ceramico diventa forte, denso e impermeabile.
Les fissures ou casses de céramique sont généralement liées au taux de porosité. L’absorption d’eau affaiblit la structure chimique de la céramique, affectant sa résistance dans le temps. Grâce au processus de vitrification, la structure granulaire du corps céramique se compacte et se densifie.
Our glazing system is carefully formulated to allow oversprayed glaze to be collected, go through a lengthy cleaning process and then be reused, minimising our impact on the environment.
Nuestro esmalte es resistente y está diseñado específicamente para el entorno de la hostelería. El esmalte que se aplica con spray crea un acabado más suave y consistente.
Nuestro sistema de esmaltado está cuidadosamente formulado para permitir que el esmalte pulverizado sobrante se recoja, pase por un largo proceso de limpieza y pueda luego ser reutilizado, minimizando nuestro impacto en el medio ambiente.
Unsere Glasur ist widerstandsfähig und speziell für das Gastgewerbe konzipiert. Die aufgesprühte Glasur erzeugt eine glattere und gleichmäßigere Oberfläche.
Il nostro smalto è resistente e appositamente studiato per le strutture ricettive. La smaltatura a spruzzo crea una finitura più liscia e uniforme.
Notre émail est conçu spécifiquement pour le secteur hôtelier. Le procédé d’émaillage par pulvérisation permet d’obtenir une finition plus lisse et homogène.
Unser Glasursystem so gut konzipiert ist, dass wir überschüssig gesprühte Glasur auffangen und nach einem langwierigen Reinigungsprozess erneut verwenden können, um unseren Umwelteinfluss zu minimieren?
Il nostro sistema di smaltatura è accuratamente formulato affinché lo smalto spruzzato in eccesso venga raccolto, subisca un lenta processo di pulizia e possa quindi essere riutilizzato, riducendo al minimo il nostro impatto sull’ambiente.
Notre système de pulvérisation nous permet de récupérer les excédents d’émail lors du process de nettoyage. En les intégrant à nouveau dans le process de fabrication, nous réduisons notre impact sur l’environnement.
We test the vitrification of our products everyday, both in the kilns during firing and in our laboratory when the manufacturing process is complete.
Probamos la vitrificación de nuestro producto todos los días, tanto en los hornos durante la cocción como en nuestro laboratorio cuando el proceso de fabricación está completo.
Wir testen die Vitrifizierung unserer Produkte tagtäglich, sowohl in den Öfen während des Brennens als auch in unserem Labor nach Vollendung des Herstellungsprozesses.
Ogni giorno sottoponiamo a test la vetrificazione dei nostri prodotti, sia nei forni durante la cottura, sia nel nostro laboratorio, al termine del processo di produzione.
Nous testons la vitrification de nos produits tous les jours, pendant le processus de cuisson et dans nos laboratoires une fois le produit terminé.
We test dishwasher durability to British Hospitality Standard BS 12875. In service testing has demonstrated that under hospitality use, this is the equal to 5000 dishwasher cycles.
Probamos la durabilidad en los lavavajillas según la Norma de Hostelería Británica BS 12875. En las pruebas se ha demostrado que el uso en hostelería, esto equivale a 5000 ciclos de lavavajillas.
Wir testen die GeschirspülerWiederstandsfähigkeit unserer Produkte laut des britischen GastronomieStandards BS 12875. In Servicetests wurde nachgewiesen, dass dies bei der Verwendung im Gastgewerbe 5000 Spülgängen entspricht.
Verifichiamo la durata in lavastoviglie secondo il British Hospitality Standard BS 12875. Dalle prove effettuate in servizio è emerso che l’uso in strutture ricettive equivale a 5.000 cicli in lavastoviglie.
Nous testons la résistance au lave-vaisselle selon la norme BS 12875. L’utilisation professionnelle démontre une résistance à plus de 5000 cycles au lave-vaisselle.

Manufactured in high quality 18/10 stainless steel.Churchill cutlery meets the highest standards in durability and performance.
El acero inoxidable 18/10 de alta calidad cumple con los más altos estándares de durabilidad y rendimiento.
Hergestellt aus reinem Edelstahl 18/10 erfüllt es höchste Standards in Qualität und Haltbarkeit.
L’alta qualita’ dell’acciaio 18/10 si aggiunge ai piu’ alti standard di durata e performance.
La haute qualité 18/10 Stainless steel contribue à la durabilité produit.







Enhance
